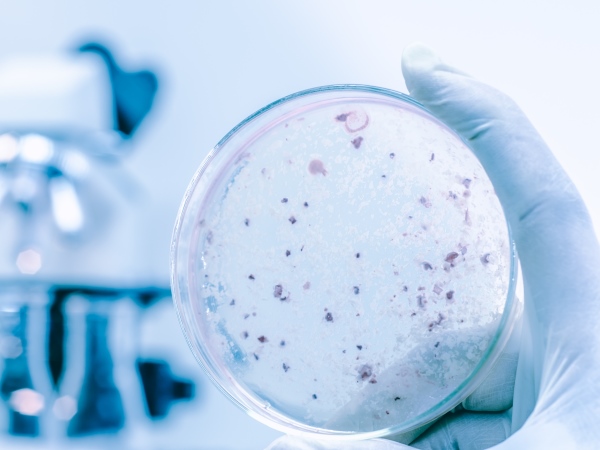
Confirmed case of Legionnaires disease after investigation launched at Isle of Wight Hotel and Spa Confirmed case of Legionnaires disease after investigation launched at Isle of Wight Hotel and Spa

Advanced Water
A company overview
EnquiriesWe take great pride in the quality of our service
View all of our full industry registrations
Working in partnership with these companies
Read about our high standards of service
Information and data security standards
Working for Advanced Water Technologies
At Advanced Water Technologies Ltd, we want to make sure that you are fully conversant and compliant with the latest legislation relating to water quality and water safety so that your premises are 100% safe and you are 100% compliant.
Advanced Water
Head Office
2 Webster Court
Carina Place
Gemini Business Park
Warrington
Cheshire
WA5 8WD
Regional Office
Unit 6
Midland Road
Midland Way
Barlborough
Derbyshire
S43 4UL
Southern Office
12 Kent House
Old Bexley Business Park
Bourne Road
Bexley
DA5 1LR
Please complete our online form to send your enquiries.
Accredited and Non-Accredited Legionella and Water Treatment / Hygiene Courses.
Contact us for more information about our latest news stories.
Make an Enquiry

Most distilleries focus on ingredients, fermentation, and maturation. But there's a silent variable that affects every batch the quality of your boiler steam. Untreated boiler water carries iron oxides, dissolved solids (TDS), and carbonic acid. When that contaminates your steam, it doesn't stay in the boiler. It carries over into your distillation process, affecting flavour consistency, batch quality, and your equipment over time.
The fix isn't complicated. But it does need to be right. AWT's steam boiler treatment programmes are built for production environments where steam quality is non-negotiable:
Effective boiler water treatment = higher steam quality. If your steam system hasn't been reviewed recently, that's worth changing.
With decades of experience in water hygiene and cooling tower maintenance, we deliver solutions that satisfy industry standards and exceed our clients' expectations of a water treatment provider. Get in touch today to discuss how we can start supporting your site by calling 01925 713273, emailing us at info@advanced-water.co.uk or by visiting our online enquiry form at https://www.advanced-water.co.uk/enquiries.
#WaterSafety #WaterDisinfection #CoolingTowers #WaterTreatment #Legionella #LegionellaControl #Chlorination #ChlorineDioxide #FacilitiesManagement #Training #AWT
Join us in supporting Antonio Solano Gonzalez this week as he represents Spain at the Roller Derby World Cup. Competing against teams including the USA, Scotland and Colombia, this is elite-level sport, built on discipline, precision and consistency.
Antonio brings this same mindset to his work with Advanced Water Technologies every day. Best of luck, Antonio - we are all behind you.
With decades of experience in water hygiene and cooling tower maintenance, we deliver solutions that satisfy industry standards and exceed our clients' expectations of a water treatment provider. Get in touch today to discuss how we can start supporting your site by calling 01925 713273, emailing us at info@advanced-water.co.uk or by visiting our online enquiry form at https://www.advanced-water.co.uk/enquiries.
#WaterSafety #WaterDisinfection #CoolingTowers #WaterTreatment #Legionella #LegionellaControl #Chlorination #ChlorineDioxide #FacilitiesManagement #Training #AWT
When heat can’t escape, you are not just risking a tube, you are risking your operation. For operations managers and engineers, this isn’t about theory, it’s about uptime, audits, and accountability.
Scale-related failures don’t happen in isolation:
By the time a tube fails, the real cost isn’t the repair — it’s everything around it. The question isn’t “is there scale?” It’s “what is it going to cost us if we ignore it?”
Only In April 2026 - Free UK-wide site audit (T&C Applies)
Follow our page at https://www.linkedin.com/company/advanced-water-technologies/ and comment “CHECK” - we’ll get in touch.
With decades of experience in water hygiene and cooling tower maintenance, we deliver solutions that satisfy industry standards and exceed our clients' expectations of a water treatment provider. Get in touch today to discuss how we can start supporting your site by calling 01925 713273, emailing us at info@advanced-water.co.uk or by visiting our online enquiry form at https://www.advanced-water.co.uk/enquiries.
#WaterSafety #WaterDisinfection #CoolingTowers #WaterTreatment #Legionella #LegionellaControl #Chlorination #ChlorineDioxide #FacilitiesManagement #Training #AWT
Follow us on LinkedIn and comment “CHECK” on https://www.linkedin.com/
Scale acts as an insulator. Heat can’t escape properly, so metal temperatures increase. That’s when tubes start to overheat, weaken, and ultimately fail — and that’s where the real risk sits. It is not just about extra fuel usage. It’s about asset integrity, safety, and whether the boiler should be allowed to continue operating.
With decades of experience in water hygiene and cooling tower maintenance, we deliver solutions that satisfy industry standards and exceed our clients' expectations of a water treatment provider. Get in touch today to discuss how we can start supporting your site by calling 01925 713273, emailing us at info@advanced-water.co.uk or by visiting our online enquiry form at https://www.advanced-water.co.uk/enquiries.
#WaterSafety #WaterDisinfection #CoolingTowers #WaterTreatment #Legionella #LegionellaControl #Chlorination #ChlorineDioxide #FacilitiesManagement #Training #AWT
In many cases, the issue isn't just fuel prices; it's what's happening inside your system. Without Preventative Boiler Management, small issues like poor softener performance turn into scale, inefficiency, and inspection risk.
Prevention isn’t an extra, it is what keeps your system running properly.
With decades of experience in water hygiene and cooling tower maintenance, we deliver solutions that satisfy industry standards and exceed our clients' expectations of a water treatment provider. Get in touch today to discuss how we can start supporting your site by calling 01925 713273, emailing us at info@advanced-water.co.uk or by visiting our online enquiry form at https://www.advanced-water.co.uk/enquiries.
#WaterSafety #WaterDisinfection #CoolingTowers #WaterTreatment #Legionella #LegionellaControl #Chlorination #ChlorineDioxide #FacilitiesManagement #Training #AWT
What looks fine might already be costing you and more importantly, putting your systems at risk. Resin doesn’t fail overnight, it degrades slowly. When it does, hardness slips through, scale starts to form inside your boiler tubes, and that’s where problems begin. Not just efficiency loss, but inspection risk. Insurance inspectors aren’t just looking at performance, they’re looking at condition. Poor water treatment leads to scaled tubes, increased failure risk and potential non-compliance.
If you haven’t checked your resin recently, now is the time. Prevent the problem before it shows up where it matters.
With decades of experience in water hygiene and cooling tower maintenance, we deliver solutions that satisfy industry standards and exceed our clients' expectations of a water treatment provider. Get in touch today to discuss how we can start supporting your site by calling 01925 713273, emailing us at info@advanced-water.co.uk or by visiting our online enquiry form at https://www.advanced-water.co.uk/enquiries.
#WaterSafety #WaterDisinfection #CoolingTowers #WaterTreatment #Legionella #LegionellaControl #Chlorination #ChlorineDioxide #FacilitiesManagement #Training #AWT
If you operate a cooling tower or steam boiler, what you can’t see is often what costs you most. We are offering a free system audit to help you identify hidden issues before they escalate into downtime, compliance risks, or unnecessary expense.
What you’ll gain:
How to claim your free audit:
Limited availability. April 2026 only.
With decades of experience in water hygiene and cooling tower maintenance, we deliver solutions that satisfy industry standards and exceed our clients' expectations of a water treatment provider. Get in touch today to discuss how we can start supporting your site by calling 01925 713273, emailing us at info@advanced-water.co.uk or by visiting our online enquiry form at https://www.advanced-water.co.uk/enquiries.
#WaterSafety #WaterDisinfection #CoolingTowers #WaterTreatment #Legionella #LegionellaControl #Chlorination #ChlorineDioxide #FacilitiesManagement #Training #AWT
Did you know that positive Legionella detection rates rose by over 20% following periods of reduced occupancy? Stagnant water in underused systems, cooling towers, calorifiers, little-used outlets creates the ideal environment for bacteria to grow. And this isn’t just a retrospective issue. If your building has reduced occupancy (or is about to), careful, measured strategies need to be in place to control the risk.
For facilities managers across Greater Manchester, Yorkshire & the North East: Now is the time to review your water systems. AWT provides Legionella risk assessments and water hygiene surveys across the North. Our engineers are local — and ready to support you.
Suddenly your biggest expense just got bigger. All from something that’s often overlooked. We see this every day and in many cases, it’s fixable. Would your system pass an efficiency check today? If you are unsure, let us find out together.
With decades of experience in water hygiene and cooling tower maintenance, we deliver solutions that satisfy industry standards and exceed our clients' expectations of a water treatment provider. Get in touch today to discuss how we can start supporting your site by calling 01925 713273, emailing us at info@advanced-water.co.uk or by visiting our online enquiry form at https://www.advanced-water.co.uk/enquiries.
#WaterSafety #WaterDisinfection #CoolingTowers #WaterTreatment #Legionella #LegionellaControl #Chlorination#ChlorineDioxide #FacilitiesManagement #Training #AWT
When was the last time you checked what scale is doing inside your boiler?
Because:
Suddenly your biggest expense just got bigger. All from something that’s often overlooked. We see this every day and in many cases, it’s fixable. Would your system pass an efficiency check today? If you are unsure, let us find out together.
With decades of experience in water hygiene and cooling tower maintenance, we deliver solutions that satisfy industry standards and exceed our clients' expectations of a water treatment provider. Get in touch today to discuss how we can start supporting your site by calling 01925 713273, emailing us at info@advanced-water.co.uk or by visiting our online enquiry form at https://www.advanced-water.co.uk/enquiries.
#WaterSafety #WaterDisinfection #CoolingTowers #WaterTreatment #Legionella #LegionellaControl #Chlorination#ChlorineDioxide #FacilitiesManagement #Training #AWT
With fuel prices making headlines again, many facilities are starting to feel the pressure on operational costs. We have compiled a short breakdown of what the recent increases could mean for the real cost of steam production. If you're looking to protect your operations from rising energy costs, speak to our team about how preventative maintenance and efficient steam systems can help keep your costs under control.
Recent geopolitical developments in the Middle East have caused a sharp surge in global energy markets. With the closure of the Strait of Hormuz and the halt of LNG production by QatarEnergy, UK industrial fuel prices have risen dramatically in just one week. Between 2nd March and 9th March 2026, estimated wholesale-linked fuel costs used in steam production increased significantly:
For facilities relying on steam systems, these increases have an immediate impact. Fuel typically represents around 85% of the total cost of generating steam, meaning fluctuations in energy markets quickly translate into higher operating costs across many industrial sectors. However, while fuel prices are outside anyone’s control, the efficiency of the steam system itself is not.
What Does Steam Typically Cost?
The industrial cost of steam in the UK can vary widely depending on efficiency and operating conditions.
Typical benchmarks include:
Historic fuel-based estimates (2009 reference) illustrate how much fuel choice influences steam cost:
However, the true cost of steam is rarely just the fuel.
Loaded vs Unloaded Steam Cost
Steam costs are often described in two ways: Unloaded Cost Covers only the fuel required to produce steam and Loaded Cost Includes additional operational factors such as:
In many cases, the loaded cost of steam can be two to three times higher than the fuel cost alone.
Why Efficiency Matters More Than Ever
When energy prices rise, inefficiencies inside the steam system become significantly more expensive. Issues such as scale build-up, poor water treatment, inefficient condensate return, and reduced heat transfer all increase the amount of fuel required to generate steam.
By comparison, well-maintained systems that return hot condensate and recover flash steam can save tens of thousands of pounds annually while improving reliability and energy efficiency.
In times of volatile energy markets, focusing on what you can control inside your plant becomes even more important.
With decades of experience in water hygiene and cooling tower maintenance, we deliver solutions that satisfy industry standards and exceed our clients' expectations of a water treatment provider. Get in touch today to discuss how we can start supporting your site by calling 01925 713273, emailing us at info@advanced-water.co.uk or by visiting our online enquiry form at https://www.advanced-water.co.uk/enquiries.
#WaterSafety #WaterDisinfection #CoolingTowers #WaterTreatment #Legionella #LegionellaControl #Chlorination#ChlorineDioxide #FacilitiesManagement #Training #AWT
Spring brings warmer water temperatures, which increases the risk of Legionella growth across building water systems. For Facilities Managers, this is often when weaknesses in monitoring or record-keeping start to show.
A quick check: Can your Legionella logbook demonstrate these five essentials today?
If any of these are missing, the responsibility sits with the Duty Holder under ACoP L8. Advanced Water Technologies supports organisations with risk assessments, compliance auditing and water hygiene programmes that withstand scrutiny. Before the next inspection, it may be worth asking one question: Would your system pass today?
With decades of experience in water hygiene and cooling tower maintenance, we deliver solutions that satisfy industry standards and exceed our clients' expectations of a water treatment provider. Get in touch today to discuss how we can start supporting your site by calling 01925 713273, emailing us at info@advanced-water.co.uk or by visiting our online enquiry form at https://www.advanced-water.co.uk/enquiries.
#WaterSafety #WaterDisinfection #CoolingTowers #WaterTreatment #Legionella #LegionellaControl #Chlorination#ChlorineDioxide #FacilitiesManagement #Training #AWT
A single consultation could identify the inefficiency that’s been costing you time and money for years. It is obvious that your plant is running today. But is it running as safely or efficiently as it could be? Expert water management isn’t an overhead cost, it’s an investment in your production continuity. Start March with a clear view of your facility’s health. Contact Advanced Water Technologies for a comprehensive water system health check.
With decades of experience in water hygiene and cooling tower maintenance, we deliver solutions that satisfy industry standards and exceed our clients' expectations of a water treatment provider. Get in touch today to discuss how we can start supporting your site by calling 01925 713273, emailing us at info@advanced-water.co.uk or by visiting our online enquiry form at https://www.advanced-water.co.uk/enquiries.
#WaterSafety #WaterDisinfection #CoolingTowers #WaterTreatment #Legionella #LegionellaControl #Chlorination#ChlorineDioxide #FacilitiesManagement #Training #AWT
Assessment identifies hazards. Proactive management prevents them. It may be obvious that cooling towers carry a potential risk for Legionella. Every plant manager knows the ACOP L8 guidelines, but Legionella doesn’t care about your annual audit.
It is a 24/7 biological threat. In food production environments, where organic matter is often present, the risk is amplified. If cooling towers are only checked to “tick a box” for the regulator, the site is not truly protected. Legionella is not just a health risk, it is a high-profile legal liability that have the potential to shut a food plant down. Advanced Water Technologies (AWT) provides the continuous care, monitoring, and precise dosing required to keep sites safe and compliant, 24/7.
With decades of experience in water hygiene and cooling tower maintenance, we deliver solutions that satisfy industry standards and exceed our clients' expectations of a water treatment provider. Get in touch today to discuss how we can start supporting your site by calling 01925 713273, emailing us at info@advanced-water.co.uk or by visiting our online enquiry form at https://www.advanced-water.co.uk/enquiries.
#WaterSafety #WaterDisinfection #CoolingTowers #WaterTreatment #Legionella #LegionellaControl #Chlorination#ChlorineDioxide #FacilitiesManagement #Training #AWT
Here is a topic you can not miss reading today because your boiler room might be burning your profit margins. So let’s talk about the operational impact. It is obvious that boilers require significant energy and fuel to run. However, just 1.5mm of scale buildup inside your boiler tubes has the potential to increase fuel consumption by ~15%.
In a high-volume food plant, that can mean thousands of pounds wasted every month. Not to mention, poor steam quality can lead to “carryover”, contaminating the very food you are trying to process.Proper water softening and oxygen scavenging isn't just maintenance, it's a direct boost to your bottom line, helping to reduce:
With decades of experience in water hygiene and cooling tower maintenance, we deliver solutions that satisfy industry standards and exceed our clients' expectations of a water treatment provider. Get in touch today to discuss how we can start supporting your site by calling 01925 713273, emailing us at info@advanced-water.co.uk or by visiting our online enquiry form at https://www.advanced-water.co.uk/enquiries.
#WaterSafety #WaterDisinfection #CoolingTowers #WaterTreatment #Legionella #LegionellaControl #Chlorination#ChlorineDioxide #FacilitiesManagement #Training #AWT
You don’t need three different contractors; you need one specialist who understands the chemistry of the whole plant - the entire ecosystem. We manage the steam (boilers), the temperature (cooling towers), the efficiency (closed loops), and wastewater under one technical strategy.
It is obvious that you need specialists for your boilers, cooling towers, and effluent systems but using different contractors for different water systems can - and often does - create technical blind spots. Think of it like a car mirror: what if we tell you that those blind spots are actually avoidable?
When one hand doesn’t know what the other is doing, chemistry conflicts arise, efficiency drops, and over time this leads to infrastructure fatigue, damaging the wider ecosystem. Advanced Water Technologies provides a holistic approach. We manage the steam, the temperature, and the safety of your entire facility under one cohesive strategy. One partner. Total oversight.
With decades of experience in water hygiene and cooling tower maintenance, we deliver solutions that satisfy industry standards and exceed our clients' expectations of a water treatment provider. Get in touch today to discuss how we can start supporting your site by calling 01925 713273, emailing us at info@advanced-water.co.uk or by visiting our online enquiry form at https://www.advanced-water.co.uk/enquiries.
#WaterSafety #WaterDisinfection #CoolingTowers #WaterTreatment #Legionella #LegionellaControl #Chlorination#ChlorineDioxide #FacilitiesManagement #Training #AWT
Most water issues don’t start as emergencies. They start quietly, between inspections, between maintenance visits, between “everything seems fine”. But the truth is, most “unexpected” water issues aren’t unexpected at all. They’re simply unmonitored.
With AWT's Technology, we don’t just see snapshots in time; we see hashtag#trends. Gradual shifts in data allow us to accurately identify where an issue is likely to arise, long before it becomes visible on-site or in a test result.
The true cost of poor water management isn’t the repair bill for a pump, it’s the risk of a total product recall or an emergency plant shutdown. Without proactive control, biofilm formation is likely in most operational water systems, creating the opportunity for Legionella to persist and thrive in the gaps of reactive, schedule-based maintenance.
That’s why prevention matters. With AWT systems and remote monitoring platforms, risks are identified early, before they become visible, before they become reportable, before they become reputational. Prevention isn’t just a safety measure. It’s production insurance.
With decades of experience in water hygiene and cooling tower maintenance, we deliver solutions that satisfy industry standards and exceed our clients' expectations of a water treatment provider. Get in touch today to discuss how we can start supporting your site by calling 01925 713273, emailing us at info@advanced-water.co.uk or by visiting our online enquiry form at https://www.advanced-water.co.uk/enquiries.
#WaterSafety #WaterDisinfection #CoolingTowers #WaterTreatment #Legionella #LegionellaControl #Chlorination#ChlorineDioxide #FacilitiesManagement #Training #AWT
It is obvious that your facility uses water. You see it at the wash stations and in the ingredient mixing. Water is actually the "circulatory system" of your entire factory. It’s the steam in your boilers, the coolant in your refrigeration towers, and the heat transfer in your closed loops. If the chemistry is off in one area, the "infection" spreads, leading to scale, corrosion, and bacterial growth across the whole site.
Understanding the full map of your water usage is the first step toward total site efficiency.
With decades of experience in water hygiene and cooling tower maintenance, we deliver solutions that satisfy industry standards and exceed our clients' expectations of a water treatment provider. Get in touch today to discuss how we can start supporting your site by calling 01925 713273, emailing us at info@advanced-water.co.uk or by visiting our online enquiry form at https://www.advanced-water.co.uk/enquiries.
#WaterSafety #WaterDisinfection #CoolingTowers #WaterTreatment #Legionella #LegionellaControl #Chlorination#ChlorineDioxide #FacilitiesManagement #Training #AWT
When you look at water through this lens, it stops being a background utility and becomes one of the most critical parts of your operation. Advanced Water Technologies provides continuous water treatment and monitoring for food manufacturers, restaurants and food production sites across the UK. From steam boiler treatment and cooling tower Legionella control to closed loop and process water systems, we help our clients keep water safe, compliant and under control every day.
Because water safety and compliance is not optional. It is regulated by law in the UK, just like every other part of your food safety system. Let’s state the obvious:
But what if your water is not managed correctly?
With decades of experience in water hygiene and cooling tower maintenance, we deliver solutions that satisfy industry standards and exceed our clients' expectations of a water treatment provider. Get in touch today to discuss how we can start supporting your site by calling 01925 713273, emailing us at info@advanced-water.co.uk or by visiting our online enquiry form at https://www.advanced-water.co.uk/enquiries.
#WaterSafety #WaterDisinfection #CoolingTowers #WaterTreatment #Legionella #LegionellaControl #Chlorination#ChlorineDioxide #FacilitiesManagement #Training #AWT
Facility Managers, Engineering Managers, QA Managers and Operations Leaders in the food industry. Let us run a quick reality check on your water systems. How confident are you that you can answer “Yes” to the following?
If you cannot confidently answer “Yes” to all of these, your water systems may be putting your operation, compliance, and product safety at risk.
Do you have full control and oversight of your site’s water systems?
Most importantly, act now and speak to us today so we can help you.
With decades of experience in water hygiene and cooling tower maintenance, we deliver solutions that satisfy industry standards and exceed our clients' expectations of a water treatment provider. Get in touch today to discuss how we can start supporting your site by calling 01925 713273, emailing us at info@advanced-water.co.uk or by visiting our online enquiry form at https://www.advanced-water.co.uk/enquiries.
#WaterSafety #WaterDisinfection #CoolingTowers #WaterTreatment #Legionella #LegionellaControl #Chlorination #ChlorineDioxide #FacilitiesManagemt #Training #AWT
As we look ahead to 2026, we’re excited about what’s to come. The progress we’ve made, the capabilities we continue to build, and our growing national reach are all driven by the dedication, expertise, and commitment of our teams across the UK.
Thank you to everyone who has supported our stakeholders and helped strengthen the business over the past year. With continued investment in people, technology, and innovation, we look forward to delivering even greater value in the year ahead to our new and old customers alike. Follow us to see how we continue to advance water technologies across the UK.
With decades of experience in water hygiene and cooling tower maintenance, we deliver solutions that satisfy industry standards and exceed our clients' expectations of a water treatment provider. Get in touch today to discuss how we can start supporting your site by calling 01925 713273, emailing us at info@advanced-water.co.uk or by visiting our online enquiry form at https://www.advanced-water.co.uk/enquiries.
#WaterSafety #WaterDisinfection #CoolingTowers #WaterTreatment #Legionella #LegionellaControl #Chlorination#ChlorineDioxide #FacilitiesManagemt #Training #WaterSafety #AWT
The Legionella Risk Assessment package from AWT brings together multiple technical elements into one coherent view of a site’s water system. Each component, from asset clarity to site-specific monitoring, is developed by specialists to ensure risk is assessed in context, not isolation. It is designed to provide clarity, accuracy and long-term relevance, not just a single moment in time.
The aim of any Legionella Risk Assessment should be to assess and record the extent, condition, design and management of all water systems within a property. It should assess and describe the risk of bacterial contamination by Legionella species, the potential for the bacteria to multiply and the potential for this to infect people with Legionnaires disease. If you want to learn more visit: https://www.advanced-water.co.uk/legionella-risk.
Legionellacontrol.org.uk just posted on 12/12/2025, and the latest UKHSA data shows a clear and encouraging shift. At first glance, the headline figures look positive. But when you step back and look at the full UKHSA study a different pattern emerges: over the past 15 years, cases have risen steadily — with 2023 marking the highest peak on record. The long-term trend is upward, not flat.
That tells us something important: short-term progress doesn’t erase long-term risk.
This improvement does, however, reflect growing awareness, stronger processes, better training, and a real increase in competence across water safety measurements. Businesses, teams, and individuals are taking Legionella risk seriously — and it’s making a visible difference. (And yes, men still feature more heavily in the statistics. Considering they also make up a large portion of roles in engineering, maintenance, HVAC and compliance, it’s probably no surprise.)
Statistics like these are solid proof that prevention work — from accurate risk assessments to good record-keeping and well-managed systems — is not just paperwork. It’s real risk reduction, reflected in real outcomes.
And this is where the bigger picture matters: based on the past 15 years of UKHSA surveillance data, we modelled a projection for the next 15 years. The results show that, unless compliance continues to strengthen and risk management improves, case numbers could keep rising — even if individual years dip up or down. Based on the 15-year trend analysis, projected Legionnaires’ disease cases may reach approximately 593 annually by 2040 (±10%: 534–652), assuming no significant changes in risk management practices.
At AWT, we’re delighted to see the positive movement reflected in 2024. But we’re equally focused on the long-term horizon — helping organisations stay ahead of risk through expert consultancy, risk assessments, safety planning, and water treatment solutions.
Progress is real, and worth celebrating. But prevention is ongoing — and the future depends on what we do next.
We’d like to remind you that AWT is here to support your organisation with the full spectrum of services — from consultancy and risk management to treatment and compliance. If you’d like to learn more about how we can help, or discuss any aspect of this article in more detail, please don’t hesitate to contact us.
With decades of experience in water hygiene and cooling tower maintenance, we deliver solutions that satisfy industry standards and exceed our clients' expectations of a water treatment provider. Get in touch today to discuss how we can start supporting your site by calling 01925 713273, emailing us at info@advanced-water.co.uk or by visiting our online enquiry form at https://www.advanced-water.co.uk/enquiries.
#WaterSafety #WaterDisinfection #CoolingTowers #WaterTreatment #Legionella #LegionellaControl #Chlorination#ChlorineDioxide #FacilitiesManagemt #Training #WaterSafety #AWT
Season’s greetings from all of us and we wish you a Merry Christmas and a Happy New Year. We are taking orders throughout December and will be operational offering products and services as normal. We would like to thank everyone involved with our company including our employees, customers, suppliers and people who have been involved in projects and related activities. We look forward to working with you in 2026.
What makes Advanced Water Technologies different is our people, experts in what we do and passionate about developing long lasting and trusted customer relationships. Our staff are regularly trained and competency checked to ensure we deliver the best water treatments possible. Our customers are pretty special and important to us too. To ensure that we continue to operate at the highest levels of customer service and technical know-how, we undertake an independent evaluation every year.
#SeasonsGreeting #WaterSafety #WaterDisinfection #CoolingTowers #WaterTreatment #Legionella #LegionellaControl #Chlorination#ChlorineDioxide #FacilitiesManagemt #Training #WaterSafety #AWT
Forward-thinking managers are already planning ahead - and it shows. Two of our 2026 Legionella risk-prevention courses are already fully booked. If you know this skill, knowledge and competence are needed within your business, make sure to secure your spot early. Take a look at our 2026 training calendar and plan ahead with confidence.
Whether you need open courses, company-exclusive sessions or flexible online learning, we’ve got you covered. Our Ofqual-accredited and specialist courses are delivered on-site, remotely or at our Barlborough Training Academy, providing industry-leading competence in Legionella risk management.
Submit your application here or get in touch with us if you have any questions. Visit the full list of course options for 2026 at https://www.advanced-water.co.uk/training-academy
With decades of experience in water hygiene and cooling tower maintenance, we deliver solutions that satisfy industry standards and exceed our clients' expectations of a water treatment provider. Get in touch today to discuss how we can start supporting your site by calling 01925 713273, emailing us at info@advanced-water.co.uk or by visiting our online enquiry form at https://www.advanced-water.co.uk/enquiries.
#WaterSafety #WaterDisinfection #CoolingTowers #WaterTreatment #Legionella #LegionellaControl #Chlorination #ChlorineDioxide #FacilitiesManagement #Training #AWT
Now, let’s factor in HSE’s Fee for Intervention. Many businesses don’t realise that compliance issues come with an ongoing hourly charge from HSE called hashtag#FFIcosts that can quickly escalate during an investigation. That hourly rate has only increased since the 2023 case study, when FFI was £163/hour. This has increased to £183/hour in 2025. How confident are you in your water safety management? We urge you to don’t leave it to chance, reach out to us today to review your water systems and ensure you’re fully compliant:
In September 2020, five people (employees and members of the public) contracted Legionnaires' disease from the vicinity of the company's site. One person required intensive care and ventilator support. A Health and Safety Executive (HSE) investigation found that the company's water-cooling towers and pipes were in an "alarmingly poor condition," which allowed the Legionella bacteria to multiply. The condition was described by an HSE principal inspector as the "worst" she had ever seen.
With decades of experience in water hygiene and cooling tower maintenance, we deliver solutions that satisfy industry standards and exceed our clients' expectations of a water treatment provider. Get in touch today to discuss how we can start supporting your site by calling 01925 713273, emailing us at info@advanced-water.co.uk or by visiting our online enquiry form at https://www.advanced-water.co.uk/enquiries.
#WaterSafety #WaterDisinfection #CoolingTowers #WaterTreatment #Legionella #LegionellaControl #Chlorination #ChlorineDioxide #FacilitiesManagement #Training #AWT
Don’t miss this, spaces are filling up. Do you or your team manage cooling towers or evaporative condensers? We have only 10 places remaining on our upcoming Highfield Level 2 Award in Legionella Awareness Course (RQF) Cooling Towers and Evaporative Condensers. To find out more details about the course or to book your spot visit: https://www.advanced-water.co.uk/training-academy. Stay compliant. Protect your team. Prevent Legionnaires' Disease.
With decades of experience in water hygiene and cooling tower maintenance, we deliver solutions that satisfy industry standards and exceed our clients' expectations of a water treatment provider. Get in touch today to discuss how we can start supporting your site by calling 01925 713273, emailing us at info@advanced-water.co.uk or by visiting our online enquiry form at https://www.advanced-water.co.uk/enquiries.
#WaterSafety #WaterDisinfection #CoolingTowers #WaterTreatment #Legionella #LegionellaControl #Chlorination #ChlorineDioxide #FacilitiesManagement #Training #AWT
Why Corrosion Rates in Closed Systems Must Be Monitored Daily Regularly? The answer is that it is a silent killer without monitoring. Is your closed system protected, or just waiting to fail? Click the link in the post to speak to a closed system specialist now.
Read our visuals to understand why daily regular monitoring is non-negotiable and how to protect your high-value assets.
With decades of experience in water hygiene and cooling tower maintenance, we deliver solutions that satisfy industry standards and exceed our clients' expectations of a water treatment provider. Get in touch today to discuss how we can start supporting your site by calling 01925 713273, emailing us at info@advanced-water.co.uk or by visiting our online enquiry form at https://www.advanced-water.co.uk/enquiries.
#WaterSafety #WaterDisinfection #CoolingTowers #WaterTreatment #Legionella #LegionellaControl #Chlorination #ChlorineDioxide #FacilitiesManagement #Training #AWT
A Legionella Risk Assessment Names The Risk But Does Not Eliminate It
Read our guide to understand the critical difference between the Assessment and the ongoing Control Scheme required by ACOP L8. Don't confuse a report with safety. Full ACOP L8 compliance is an ongoing action.
With decades of experience in water hygiene and cooling tower maintenance, we deliver solutions that satisfy industry standards and exceed our clients' expectations of a water treatment provider. Get in touch today to discuss how we can start supporting your site by calling 01925 713273, emailing us at info@advanced-water.co.uk or by visiting our online enquiry form at https://www.advanced-water.co.uk/enquiries.
#WaterSafety #WaterDisinfection #CoolingTowers #WaterTreatment #Legionella #LegionellaControl #Chlorination #ChlorineDioxide #FacilitiesManagement #Training #AWT
Your process system is probably unique, so why are you using standard, generic treatment chemistry? In complex industrial environments, standard products often fall short, leading to inconsistent results, higher usage, and, ultimately, costly system damage. The visuals below will outline why bespoke chemical programming is an important investment.
Find out more about a custom programme designed for your plant's success and share this with a colleague who manages industrial process water.
With decades of experience in water hygiene and cooling tower maintenance, we deliver solutions that satisfy industry standards and exceed our clients' expectations of a water treatment provider. Get in touch today to discuss how we can start supporting your site by calling 01925 713273, emailing us at info@advanced-water.co.uk or by visiting our online enquiry form at https://www.advanced-water.co.uk/enquiries.
#WaterSafety #WaterDisinfection #CoolingTowers #WaterTreatment #Legionella #LegionellaControl #Chlorination #ChlorineDioxide #FacilitiesManagement #Training #AWT
Most facility managers know scale is a problem, but few realise the staggering cost hiding in their boiler system. Just a thin layer of scale drastically reduces heat transfer efficiency, forcing your system to work harder and unnecessarily increasing your fuel costs. We have broken down the risk into three quick checks that every engineer and manager should review today. Swipe through to see the checklist that helps to protect your assets and your P&L.
Don't let scale silently erode your profits. This is a risk that requires your action. Share this with your Facility Manager or Maintenance team.
With decades of experience in water hygiene and cooling tower maintenance, we deliver solutions that satisfy industry standards and exceed our clients' expectations of a water treatment provider. Get in touch today to discuss how we can start supporting your site by calling 01925 713273, emailing us at info@advanced-water.co.uk or by visiting our online enquiry form at https://www.advanced-water.co.uk/enquiries.
#WaterSafety #WaterDisinfection #CoolingTowers #WaterTreatment #Legionella #LegionellaControl #Chlorination #ChlorineDioxide #FacilitiesManagement #Training #AWT
Compliance requires vigilance. In our experience auditing cooling tower systems, we repeatedly see three critical monitoring failures that immediately raise the risk profile and flag potential audit issues. These aren't system failures, they are people failures. Swipe through and check if your current monitoring process is exposed. Monitoring is your first and best line of defence. Don't leave your cooling tower compliance to chance. Ask yourself this: What is the most common monitoring mistake you’ve witnessed in your career?
With decades of experience in water hygiene and cooling tower maintenance, we deliver solutions that satisfy industry standards and exceed our clients' expectations of a water treatment provider. Get in touch today to discuss how we can start supporting your site by calling 01925 713273, emailing us at info@advanced-water.co.uk or by visiting our online enquiry form at https://www.advanced-water.co.uk/enquiries.
#WaterSafety #WaterDisinfection #CoolingTowers #WaterTreatment #Legionella #LegionellaControl #Chlorination#ChlorineDioxide #FacilitiesManagement #Training #AWT
Don’t miss this Legionella Awareness Course as spaces are filling up. Do you or your team manage cooling towers or evaporative condensers? We have only 10 places remaining on our upcoming Highfield Level 2 Award in Legionella Awareness Course (RQF) Cooling Towers and Evaporative Condensers.
To find out more details about the course or to book your spot visit https://www.advanced-water.co.uk/training-academy. Stay compliant. Protect your team. Prevent Legionnaires' Disease.
With decades of experience in water hygiene and cooling tower maintenance, we deliver solutions that satisfy industry standards and exceed our clients' expectations of a water treatment provider. Get in touch today to discuss how we can start supporting your site by calling 01925 713273, emailing us at info@advanced-water.co.uk or by visiting our online enquiry form at https://www.advanced-water.co.uk/enquiries.
#WaterSafety #WaterDisinfection #CoolingTowers #WaterTreatment #Legionella #LegionellaControl #Chlorination#ChlorineDioxide #FacilitiesManagement #Training #AWT
If you think your water systems are due for a review, reach out to us and book a free consultation today. Keeping your water systems safe isn’t just best practice, it’s a regulatory requirement.
Here are a few key times disinfection is necessary:
Regular risk assessments and monitoring are key to knowing when disinfection is needed. A proactive approach protects both building occupants and your business from potential legal and health risks. Visit our website to learn how we can help you stay aligned with UK standards.
With decades of experience in water hygiene and cooling tower maintenance, we deliver solutions that satisfy industry standards and exceed our clients' expectations of a water treatment provider. Get in touch today to discuss how we can start supporting your site by calling 01925 713273, emailing us at info@advanced-water.co.uk or by visiting our online enquiry form at https://www.advanced-water.co.uk/enquiries.
#WaterSafety #WaterDisinfection #CoolingTowers #WaterTreatment #Legionella #LegionellaControl #Chlorination#ChlorineDioxide #FacilitiesManagement #Training #AWT
Just about two weeks ago, Members of AWT gathered for a fantastic day out at Newbury Racecourse with the AWT Southern Regional team. Organised by our Southern Regional Manager Shane, it was such a great opportunity to connect, celebrate, and recognise the hard work and dedication that everyone contributes to the region.
AWT is grateful to be part of such a committed group of people who always bring their best. A dedicated water treatment and hygiene specialists focused on providing optimum solutions across a vast array of services, chemicals, equipment, risk assessments supported by innovative IT technologies for optimal performance and assured compliance.
#CoolingTowers #WaterTreatment #Chlorination #Legionella #ChlorineDioxide #Training #WaterSafety #AWT
These units were built with free ClO2 analyser for easy readout display and protection mechanisms to prevent overdosing. This has ensured our client maintains compliance with disinfection of potable quality water and reduction in chemical consumption costs.
A recent install we’re proud of. We replaced outdated hashtag#ClO₂ systems at a key client site with state-of-the-art units - now complete with:
What is the outcome? Improved compliance, reduced chemical use, and peace of mind for the client. Safe to say, this marks another successful project delivered by AWT. ClO2 refers to chlorine dioxide, a powerful and fast-acting chemical compound used as a disinfectant, biocide, and sanitizer in various industries, including pulp and paper bleaching, water treatment, and food processing. It is a yellow-green gas that acts as a strong oxidizing agent, but it is also toxic and unstable, requiring careful handling and often on-site generation for safe use.
#CoolingTowers #WaterTreatment #Chlorination #Legionella #ChlorineDioxide #Training #WaterSafety #AWT
Your Legionella risk assessment is a legal obligation and a crucial first step, but it's not the last. The Health and Safety Executive's Approved Code of Practice (ACOP L8) is clear: inadequate training is a major factor in outbreaks of Legionnaires' disease. This is why having a competent and trained team isn't just a good idea - it's a legal necessity. A well-trained team is your most effective way to protect your business from legal, financial, and operational risks.
The Advanced Water Technologies Training Academy is here to build that competence. We offer internationally recognised, Ofqual-accredited courses, including:
With courses already scheduled for 2025 and 2026, there’s no better time to invest in your team. We offer flexible training either at our bespoke training facility Barlborough (Derbyshire), on your site anywhere in the UK, or online, to suit your needs.
We understand it’s not always convenient to travel away from your place of work, this is why each course listed above can be delivered exclusively to your company at your site, or remotely via Teams/Zoom. With up to ten candidates per course, this makes it the most cost-effective way of funding your training needs. To arrange a date *or to discuss the courses we offer, please contact us at training@advanced-water.co.uk. Ready to invest in your team's expertise? Contact us to book your training today.
#Cooling #Tower #Water #Treatment #Chlorination #Legionella #Training #AWT
Big performance in a small footprint? Challenge accepted. At Advanced Water Technologies, we thrive on making the impossible possible. When a client needed chemical dosing and storage for nine condensers - all within a space just 6m x 2.5m. Our team designed and delivered a fully bespoke solution that fit like a glove. We are ready! Take a look at one of our latest installs below and see what’s possible when experience meets innovation.
#Cooling #Tower #Water #Treatment #Chlorination #Legionella #Training #AWT
In November 2024, HSL Compliance completed the acquisition of industrial water treatment services provider, Advanced Water Technologies. AWT has offices across the UK employing over 80 people. The acquisition significantly enhances HSL's presence in the UK industrial water treatment market being greater scale, increased opportunity for colleagues and enhancing the combined service offered to clients.
The acquisition takes the combined companies headcount to over 600 people. Following the acquisition, Directors Peter Barratt, Mark Gowland and their senior management team remain in charge of the business to ensure continuity of service to clients. HSL Compliance is a risk and compliance leader, specialising in water, hazardous materials, fire safety and associated Health Safety and Environmental services. As health and safety regulations evolve, keeping your people safe and assuring compliance can be a time-consuming challenge. HSL Compliance makes it simple. From inspection and analysis to remediation and ongoing monitoring, you can count on expert guidance and a service that’s tailored to you.
#Cooling #Tower #Water #Treatment #Chlorination #Legionella #Training #AWT
We would like to take a moment to introduce you to our Southern Regional Team! We’re proud of the incredible service our regional model delivers across the country for our valued clients.
Speaking within the group about what each person specialises in, it was clear that the depth of experience is incredible. Key areas of specialist knowledge include: Effluent, Training, Mechanical Engineering, Closed Systems, Water Hygiene, FMs, Swimming Pools, and so much more!
All of our account managers and regional managers actively visit sites, committed to understand your specific requirements, and are always on hand to help. With regular team meetings held to discuss their experiences and opinions/ideas, the teams are constantly expanding their own knowledge, gathering an ever-growing array of solutions to share with their clients. And the best part of having a close-knit, regional team, local to your site? If your account manager is unavailable for whatever reason, there’s always a colleague nearby to step in and help.
#CoolingTower #WaterTreatment #Chlorination #LegionellaRisk #Training #AWT
Here at Advanced Water Technologies, we understand that effective cooling tower maintenance is crucial for both operational efficiency and compliance. By using our skilled engineers and disinfection process, we help ensure optimal performance and demonstrate full compliance with regulatory safety standards.
Advanced Water Technologies can also offer GRP (Glass Reinforced Plastic) relining of cooling tower sumps, should corrosion start to be identified. Check out the before and after images. Over time, cooling towers can suffer from surface degradation, leading to corrosion, encouraging bacterial growth. Enhanced GRP relining processes restore the integrity of internal surfaces to a ‘like-new’ condition, improving durability, system hygiene, and extending the asset’s service life.
With decades of experience in water hygiene and cooling tower maintenance, we deliver solutions that satisfy industry standards and exceed our clients' expectations of a water treatment provider. Get in touch today to discuss how we can start supporting your site!
#Cooling #Tower #Water #Treatment #Chlorination #Legionella #Training #AWT
AWT Training course on 8th July 2025 at our training academy next door to Junction 30 on the M1 in Barlborough, Derbyshire. More details can be found at www.advanced-water.co.uk/training-academy or to confirm your booking please contact us at training@advanced-water.co.uk.
Is this course for you or your staff?
This Ofqual-accredited course is aimed at senior people in any organisation and those who manage building water systems, particularly those individuals who are Dutyholders, Responsible Persons or supervisors, to ensure the risk presented by Legionella bacteria is minimised and compliance is achieved.
Why should I attend?
This course is designed to highlight the responsibilities and duties of Dutyholders and Responsible Persons and reduce the risk associated with the waterborne bacteria that cause Legionnaires’ Disease. Delegates who attend this course will leave with an understanding of how to apply relevant legislation within their day-to-day duties, with a particular focus on the Health and Safety Executive’s Approved Code of Practice L8 and accompanying Technical Guidance HSG 274 documents.
On the completion of the course candidates will:
Course duration and accreditation:
This is a one-day course. Successful delegates will achieve a formal Level 3 qualification awarded by Highfield Qualifications Ltd. The qualification is accredited by Ofqual (the Qualifications and Examinations regulator for England and Northern Ireland) and sits on the Regulated Qualifications Framework (RQF). Photo ID i.e. Passport or driving licence is required to attend the course. A webcam which is on during the whole of the training if it is an on-line course. *Online course only.
#Cooling #Tower #Water #Treatment #Chlorination #Legionella #Training #AWT
Water treatment is no longer about manual checks and reactive maintenance. With technology like cooling water monitors fitted with SIM card routers, we enable remote access to crucial system data.
What does that mean for our clients?
Smart water management isn’t just the future - it’s happening now. Want to be able to access extensive reports and make changes as needed, securely? We’ve got the technology to ensure you’re always covered and always in the know.
For one of our clients, we added pH, conductivity, bromine and corrosion sensors within their cooling towers and a SIM card to allow for secure remote access. As a result, they saw a reduction in microbiological growth on their dip-slide which essentially reduced their risk of legionella. If there’s an issue, they get a warning instantaneously of levels not being as they should be. On top of that, at ease, our client can extract comprehensive reports to prove compliance for Health and Safety visits, a reduction is risk, stress, and time, all from our solution. Want to know more? Get in contact today.
#Cooling #Tower #Water #Treatment #Chlorination #Legionella #Training #AWT
AWT Training course on 8th April 2025 at our training academy next door to Junction 30 on the M1 in Barlborough, Derbyshire. More details can be found at www.advanced-water.co.uk/training-academy or to confirm your booking please contact us at training@advanced-water.co.uk.
Is this course for you or your staff?
This Ofqual accredited course is aimed at staff involved in managing, supervising, and monitoring hot and cold systems to ensure the risk presented by Legionella bacteria is minimised and compliance is achieved.
Why should I attend?
This course is designed to raise awareness and reduce the risk associated with the waterborne bacteria that cause Legionnaires’ Disease. Delegates who attend this course will leave with an understanding of how to apply relevant legislation within their day-to-day duties, with a particular focus on the Health and Safety Executive’s Approved Code of Practice L8 and accompanying Technical Guidance HSG 274 documents.
On the completion of the course candidates will:
Course duration and accreditation:
This is a one-day course. Successful delegates will achieve a formal Level 2 qualification awarded by Highfield Qualifications Ltd. The qualification is accredited by Ofqual (the Qualifications and Examinations regulator for England and Northern Ireland) and sits on the Regulated Qualifications Framework (RQF).
Photo ID i.e. Passport or driving licence is required to attend the course. A webcam which is on during the whole of the training if it is an on-line course. *Online course only.
#Cooling #Tower #Water #Treatment #Chlorination #Legionella #Training #AWT
Advanced Water Technologies are recruiting, a vacancy has arisen for an Environmental Service Technician to join our Yorkshire based team, working out of our Barlborough Office (M1 junction 30). Some experience of the water industry is desirable including water hygiene work, cooling tower and water tank clean and disinfection. For more details contact hr@advanced-water.co.uk.
#Cooling #Tower #Water #Treatment #Chlorination #Legionella #Training #AWT
AWT Training course on 17th March 2025 at our training academy next door to Junction 30 on the M1 in Barlborough, Derbyshire. More details can be found at www.advanced-water.co.uk/training-academy or to confirm your booking please contact us at training@advanced-water.co.uk.
Is this course for you or your staff?
This Ofqual accredited course is aimed at staff involved in managing, supervising, and monitoring cooling towers and evaporative condensers to ensure the risk presented by Legionella bacteria is minimised and compliance is achieved.
Why should I attend?
This course is designed to raise awareness and reduce the risk associated with the waterborne bacteria that cause Legionnaires’ Disease. Delegates who attend this course will leave with an understanding of how to apply relevant legislation within their day-to-day duties, with a particular focus on the Health and Safety Executive’s Approved Code of Practice L8 and accompanying Technical Guidance HSG 274 documents.
On the completion of the course candidates will:
Course duration and accreditation:
This is a one-day course. Successful delegates will achieve a formal Level 2 qualification awarded by Highfield Qualifications Ltd. The qualification is accredited by Ofqual (the Qualifications and Examinations regulator for England and Northern Ireland) and sits on the Regulated Qualifications Framework (RQF).
Photo ID i.e. Passport or driving licence is required to attend the course. A webcam which is on during the whole of the training if it is an on-line course. *Online course only.
#Cooling #Tower #Water #Treatment #Chlorination #Legionella #Training #AWT
AWT Training course on 24th January 2025 at our training academy next door to Junction 30 on the M1 in Barlborough, Derbyshire. More details can be found at www.advanced-water.co.uk/training-academy or to confirm your booking please contact us at training@advanced-water.co.uk.
Is this course for you or your staff?
This Ofqual accredited course is aimed at staff involved in managing, supervising, and monitoring hot and cold systems to ensure the risk presented by Legionella bacteria is minimised and compliance is achieved.
Why should I attend?
This course is designed to raise awareness and reduce the risk associated with the waterborne bacteria that cause Legionnaires’ Disease. Delegates who attend this course will leave with an understanding of how to apply relevant legislation within their day-to-day duties, with a particular focus on the Health and Safety Executive’s Approved Code of Practice L8 and accompanying Technical Guidance HSG 274 documents.
On the completion of the course candidates will:
Course duration and accreditation:
This is a one-day course. Successful delegates will achieve a formal Level 2 qualification awarded by Highfield Qualifications Ltd. The qualification is accredited by Ofqual (the Qualifications and Examinations regulator for England and Northern Ireland) and sits on the Regulated Qualifications Framework (RQF).
Photo ID i.e. Passport or driving licence is required to attend the course. A webcam which is on during the whole of the training if it is an on-line course. *Online course only.
#Cooling #Tower #Water #Treatment #Chlorination #Legionella #Training #AWT
Season’s greetings from all of us and we wish you a Merry Christmas and a Happy New Year. We are taking orders throughout December and will be operational offering products and services as normal. Our last working day before Christmas will be Monday 23rd December 2024, reopening on Thursday 2nd January 2025. We would like to thank everyone involved with our company including our employees, customers, suppliers and people who have been involved in projects and related activities.
Advanced Water Technologies offer a wide range of water treatment services and management programmes. We have over 200 years of practical experience, comprehensive industry accreditations and a vast knowledge of water treatment products and services. This means we can provide a comprehensive range of water treatment programmes designed to meet customer’s exact needs and conforming to the latest legislation requirements.
We have locations in the North West, East Midlands and the South East delivering flexible water treatment products and services nationally throughout the UK. Covering a range of industrial and commercial sectors, we consistently deliver quality water treatment solutions that are financially, technically and environmentally sustainable. We look forward to working with you in 2025.
#Cooling #Tower #Water #Treatment #Chlorination #Legionella #Training #AWT
The highly successful Highfield water treatment training courses offered by Advanced Water Technologies have been released for 2025. There are 14 training courses available from January to December 2025 following on from our well received and attended program from 2024. More details can be found at www.advanced-water.co.uk/training-academy or to confirm your booking please contact us at training@advanced-water.co.uk.
Our full course schedule for 2025 is presented below:
#Cooling #Tower #Water #Treatment #Chlorination #Legionella #Training #AWT
Advanced Water Technologies looking to fulfil two roles covering Scotland, North East England and Yorkshire due to rapid growth. £40k to £50k salary dependent on experience plus an excellent bonus scheme. Company car (including electric vehicle options) or car allowance options. Water treatment specialists required, experience with Cooling Towers and Steam Boilers is essential. Send your CV you info@advanced-water.co.uk.co.uk.
At Advanced Water Technologies Ltd our people are our most important asset and we place great importance on professional and personal development to ensure they are best placed to help our customers.
Employee continuity is an essential part of our company. We feel this is essential when offering a quality service, as it means our engineers are able to build an extensive knowledge of your site and the works required to be carried out.
Because we take great pride in the quality of our service, we have developed a loyal team of dedicated specialists who are:
We have locations in the North West, East Midlands and the South East delivering flexible water treatment products and services nationally throughout the UK. Serving a wide range of industries, we strive to continually add value and make a difference to our customers' businesses.
#AWT #Cooling #Tower #Water #Treatment #Chlorination #Legionella #Training #AWT
AWT Training course on 23rd January 2025 at our training academy next door to Junction 30 on the M1 in Barlborough, Derbyshire. More details can be found at www.advanced-water.co.uk/training-academy or to confirm your booking please contact us at training@advanced-water.co.uk.
Is this course for you or your staff?
This Ofqual-accredited course is aimed at senior people in any organisation and those who manage building water systems, particularly those individuals who are Dutyholders, Responsible Persons or supervisors, to ensure the risk presented by Legionella bacteria is minimised and compliance is achieved.
Why should I attend?
This course is designed to highlight the responsibilities and duties of Dutyholders and Responsible Persons and reduce the risk associated with the waterborne bacteria that cause Legionnaires’ Disease.
Delegates who attend this course will leave with an understanding of how to apply relevant legislation within their day-to-day duties, with a particular focus on the Health and Safety Executive’s Approved Code of Practice L8 and accompanying Technical Guidance HSG 274 documents.
On the completion of the course candidates will:
Course duration and accreditation:
This is a one-day course. Successful delegates will achieve a formal Level 3 qualification awarded by Highfield Qualifications Ltd. The qualification is accredited by Ofqual (the Qualifications and Examinations regulator for England and Northern Ireland) and sits on the Regulated Qualifications Framework (RQF).
Photo ID i.e. Passport or driving licence is required to attend the course. A webcam which is on during the whole of the training if it is an on-line course. *Online course only.
#Cooling #Tower #Water #Treatment #Chlorination #Legionella #Training #AWT
This week Advanced Water Technologies have taken delivery of a number of new vehicles. Working in Partnership with TCH leasing, AWT will be replacing its fleet of vans fully over the coming months. Thank you to all TCH for making this a smooth and easy transition. In addition, AWT is working on a project to have some biodiesel tanks installed, that will allow its fleet of vans to be run on an alternative fuel, which will have a significant impact on the C02e outputs. Find out more at https://www.advanced-water.co.uk/latest-news.
#CoolingTower #WaterTreatment #Chlorination #LegionellaRisk #Training #AWT
AWT Training course on 8th November 2024 at our training academy next door to Junction 30 on the M1 in Barlborough, Derbyshire. More details can be found at www.advanced-water.co.uk/training-academy or to confirm your booking please contact us at training@advanced-water.co.uk.
Is this course for you or your staff?
This Ofqual accredited course is aimed at staff involved in managing, supervising, and monitoring cooling towers and evaporative condensers to ensure the risk presented by Legionella bacteria is minimised and compliance is achieved.
Why should I attend?
This course is designed to raise awareness and reduce the risk associated with the waterborne bacteria that cause Legionnaires’ Disease. Delegates who attend this course will leave with an understanding of how to apply relevant legislation within their day-to-day duties, with a particular focus on the Health and Safety Executive’s Approved Code of Practice L8 and accompanying Technical Guidance HSG 274 documents.
On the completion of the course candidates will:
Course duration and accreditation:
This is a one-day course. Successful delegates will achieve a formal Level 2 qualification awarded by Highfield Qualifications Ltd. The qualification is accredited by Ofqual (the Qualifications and Examinations regulator for England and Northern Ireland) and sits on the Regulated Qualifications Framework (RQF).
Photo ID i.e. Passport or driving licence is required to attend the course. A webcam which is on during the whole of the training if it is an on-line course. *Online course only.
#Cooling #Tower #Water #Treatment #Chlorination #Legionella #Training #AWT
AWT Training course on 3rd October 2024 at our training academy next door to Junction 30 on the M1 in Barlborough, Derbyshire. More details can be found at www.advanced-water.co.uk/training-academy or to confirm your booking please contact us at training@advanced-water.co.uk.
Is this course for you or your staff?
This Ofqual accredited course is aimed at staff involved in managing, supervising, and monitoring hot and cold systems to ensure the risk presented by Legionella bacteria is minimised and compliance is achieved.
Why should I attend?
This course is designed to raise awareness and reduce the risk associated with the waterborne bacteria that cause Legionnaires’ Disease. Delegates who attend this course will leave with an understanding of how to apply relevant legislation within their day-to-day duties, with a particular focus on the Health and Safety Executive’s Approved Code of Practice L8 and accompanying Technical Guidance HSG 274 documents.
On the completion of the course candidates will:
Course duration and accreditation:
This is a one-day course. Successful delegates will achieve a formal Level 2 qualification awarded by Highfield Qualifications Ltd. The qualification is accredited by Ofqual (the Qualifications and Examinations regulator for England and Northern Ireland) and sits on the Regulated Qualifications Framework (RQF).
Photo ID i.e. Passport or driving licence is required for attendance.
A webcam which is on during the whole of the training if it is an on-line course. *Online course only.
#Cooling #Tower #Water #Treatment #Chlorination #Legionella #Training #AWT
Mega Miles Month takes place from the 1st-31st August. We’re asking teams to join in by walking, running, cycling or using a wheelchair or walking aid as much as possible during the month of August. You would each keep track of your miles and get sponsored as you go, contributing towards a team mileage target and fundraising goal. One of the AWT team Simon Ostick attended a recent Colleague Awards event which had Mega Miles as a sponsor with Natalie Bargery as the main contact.
For more information take a look at the Mega Miles Month Fundraising page https://fundraising.makingspace.co.uk/fundraising-group/megamilesmonth
#CoolingTower #WaterTreatment #Chlorination #LegionellaRisk #Training #AWT
AWT Training course on 15th August 2024 at our training academy next door to Junction 30 on the M1 in Barlborough, Derbyshire. More details can be found at www.advanced-water.co.uk/training-academy or to confirm your booking please contact us at training@advanced-water.co.uk.
Is this course for you or your staff?
This Ofqual accredited course is aimed at staff involved in managing, supervising, and monitoring cooling towers and evaporative condensers to ensure the risk presented by Legionella bacteria is minimised and compliance is achieved.
Why should I attend?
This course is designed to raise awareness and reduce the risk associated with the waterborne bacteria that cause Legionnaires’ Disease. Delegates who attend this course will leave with an understanding of how to apply relevant legislation within their day-to-day duties, with a particular focus on the Health and Safety Executive’s Approved Code of Practice L8 and accompanying Technical Guidance HSG 274 documents.
On the completion of the course candidates will:
Course duration and accreditation:
This is a one-day course. Successful delegates will achieve a formal Level 2 qualification awarded by Highfield Qualifications Ltd. The qualification is accredited by Ofqual (the Qualifications and Examinations regulator for England and Northern Ireland) and sits on the Regulated Qualifications Framework (RQF).
Photo ID i.e. Passport or driving licence is required for attendance.
#Cooling #Tower #Water #Treatment #Chlorination #Legionella #Training #AWT
Advanced Water Technologies are recruiting, a vacancy has arisen for an Environmental Service Technician to join our Yorkshire based team, working out of our Barlborough Office (M1 junction 30). Some experience of the water industry is desirable including water hygiene work, cooling tower and water tank clean and disinfection. For more details contact mmyers@advanced-water.co.uk.
#Cooling #Tower #Water #Treatment #Chlorination #Legionella #Training #AWT
AWT Training course on 3rd July 2024 at our training academy next door to Junction 30 on the M1 in Barlborough, Derbyshire. More details can be found at www.advanced-water.co.uk/training-academy or to confirm your booking please contact us at training@advanced-water.co.uk.
Is this course for you or your staff?
This Ofqual accredited course is aimed at staff involved in managing, supervising, and monitoring hot and cold systems to ensure the risk presented by Legionella bacteria is minimised and compliance is achieved.
Why should I attend?
This course is designed to raise awareness and reduce the risk associated with the waterborne bacteria that cause Legionnaires’ Disease.
Delegates who attend this course will leave with an understanding of how to apply relevant legislation within their day-to-day duties, with a particular focus on the Health and Safety Executive’s Approved Code of Practice L8 and accompanying Technical Guidance HSG 274 documents.
On the completion of the course candidates will:
Course duration and accreditation:
This is a one-day course. Successful delegates will achieve a formal Level 2 qualification awarded by Highfield Qualifications Ltd. The qualification is accredited by Ofqual (the Qualifications and Examinations regulator for England and Northern Ireland) and sits on the Regulated Qualifications Framework (RQF). Photo ID i.e. Passport or driving licence is required for attendance.
#Cooling #Tower #Water #Treatment #Chlorination #Legionella #Training #AWT
AWT Training course on 9th May 2024 at our training academy next door to Junction 30 on the M1 in Barlborough, Derbyshire. More details can be found at www.advanced-water.co.uk/training-academy or to confirm your booking please contact us at training@advanced-water.co.uk.
Is this course for you or your staff?
This Ofqual accredited course is aimed at staff involved in managing, supervising, and monitoring cooling towers and evaporative condensers to ensure the risk presented by Legionella bacteria is minimised and compliance is achieved.
Why should I attend?
This course is designed to raise awareness and reduce the risk associated with the waterborne bacteria that cause Legionnaires’ Disease. Delegates who attend this course will leave with an understanding of how to apply relevant legislation within their day-to-day duties, with a particular focus on the Health and Safety Executive’s Approved Code of Practice L8 and accompanying Technical Guidance HSG 274 documents.
On the completion of the course candidates will:
Course duration and accreditation:
This is a one-day course. Successful delegates will achieve a formal Level 2 qualification awarded by Highfield Qualifications Ltd. The qualification is accredited by Ofqual (the Qualifications and Examinations regulator for England and Northern Ireland) and sits on the Regulated Qualifications Framework (RQF). Photo ID i.e. Passport or driving licence.
#Cooling #Tower #Water #Treatment #Chlorination #Legionella #Training #AWT
AWT Training course on 26th April 2024 at our training academy next door to Junction 30 on the M1 in Barlborough, Derbyshire. More details can be found at www.advanced-water.co.uk/training-academy or to confirm your booking please contact us at training@advanced-water.co.uk.
Is this course for you or your staff?
This Ofqual accredited course is aimed at staff involved in managing, supervising, and monitoring hot and cold systems to ensure the risk presented by Legionella bacteria is minimised and compliance is achieved.
Why should I attend?
This course is designed to raise awareness and reduce the risk associated with the waterborne bacteria that cause Legionnaires’ Disease. Delegates who attend this course will leave with an understanding of how to apply relevant legislation within their day-to-day duties, with a particular focus on the Health and Safety Executive’s Approved Code of Practice L8 and accompanying Technical Guidance HSG 274 documents.
On the completion of the course candidates will:
Course duration and accreditation:
This is a one-day course. Successful delegates will achieve a formal Level 2 qualification awarded by Highfield Qualifications Ltd. The qualification is accredited by Ofqual (the Qualifications and Examinations regulator for England and Northern Ireland) and sits on the Regulated Qualifications Framework (RQF). Photo ID i.e. Passport or driving licence will be required to attend the course.
#Cooling #Tower #Water #Treatment #Chlorination #Legionella #Training #AWT
At Advanced Water Technologies, we want to make sure that you are fully conversant and compliant with the latest legislation relating to water quality and water safety so that your premises are 100% safe and you are 100% compliant.
Useful Links Use these links to download the latest HSE information, codes of practice and guidance on workplace health and safety issues. To download the latest HSE recommendations, codes of practice and guidance on workplace health and safety issues, simply click on the relevant hyperlinks on this page https://www.advanced-water.co.uk/keeping-you-informed
Water sources and potential Pseudomonas aeruginosa contamination of taps and water systems - Advice for augmented care unit:Pseudomonas aeruginosa
#Cooling #Tower #Water #Treatment #Chlorination #Legionella #Training #AWT
Why do you need wastewater treatment? Without effective wastewater treatment your waste water will remain contaminated, meaning you will experience higher running costs (including water and disposal), efficiency problems and of course possible environmental problems. Find out more about our waste water treatment at https://www.advanced-water.co.uk/waste-water-treatment
Wastewater in the UK is treated in three main ways:
Want to discuss this service further? Call our experienced team on Call 01925 713273. At Advanced Water Technologies we want to keep you informed and we want to make sure that you have access to all the information you need. You can view all of our accreditations, find out about our services and view important links and legislation information. You can also call or email us by visiting our contact us page.
#Cooling #Tower #Water #Treatment #Chlorination #Legionella #Training #AWT
AWT Training course on 1st February 2024 at our training academy next door to Junction 30 on the M1 in Barlborough, Derbyshire. More details can be found at www.advanced-water.co.uk/training-academy or to confirm your booking please contact us at training@advanced-water.co.uk.
Is this course for you or your staff?
This Ofqual accredited course is aimed at staff involved in managing, supervising, and monitoring cooling towers and evaporative condensers to ensure the risk presented by Legionella bacteria is minimised and compliance is achieved.
Why should I attend?
This course is designed to raise awareness and reduce the risk associated with the waterborne bacteria that cause Legionnaires’ Disease. Delegates who attend this course will leave with an understanding of how to apply relevant legislation within their day-to-day duties, with a particular focus on the Health and Safety Executive’s Approved Code of Practice L8 and accompanying Technical Guidance HSG 274 documents.
On the completion of the course candidates will:
Course duration and accreditation:
This is a one-day course. Successful delegates will achieve a formal Level 2 qualification awarded by Highfield Qualifications Ltd. The qualification is accredited by Ofqual (the Qualifications and Examinations regulator for England and Northern Ireland) and sits on the Regulated Qualifications Framework (RQF). Photo ID i.e. Passport or driving licence will be required to attend the course. A webcam which is on during the whole of the training if it is an on-line course. *Online courses only
#Cooling #Tower #Water #Treatment #Chlorination #Legionella #Training #AWT
Season’s greetings from all of us and we wish you a Merry Christmas and a Happy New Year. We are taking orders throughout December and will be operational offering products and services as normal. Our last working day before Christmas will be Friday 22nd December 2023, reopening on Tuesday 2nd January 2024. We would like to thank everyone involved with our company including our employees, customers, suppliers and people who have been involved in projects and related activities.
Advanced Water Technologies offer a wide range of water treatment services and management programmes. We have over 200 years of practical experience, comprehensive industry accreditations and a vast knowledge of water treatment products and services. This means we can provide a comprehensive range of water treatment programmes designed to meet customer’s exact needs and conforming to the latest legislation requirements.
We have locations in the North West, East Midlands and the South East delivering flexible water treatment products and services nationally throughout the UK. Covering a range of industrial and commercial sectors, we consistently deliver quality water treatment solutions that are financially, technically and environmentally sustainable. We look forward to working with you in 2024.
#Cooling #Tower #Water #Treatment #Chlorination #Legionella #Training #AWT
Once again Advanced Water technologies has chosen to support Earthly.org (Earthly | Invest in nature) by investing in Nature projects here in the UK, Seaweed Farming in Cornwall and Tree sponsorship in Central Scotland.
These, we considered as worthwhile projects, one that will benefit the environment through high volume carbon absorption - seaweed, but it has additional benefits across many industry sectors, and tree planting in Central Scotland that is one part of a complex mosaic landscape of peatlands, ancient woodland and degraded wildflower meadows. Through holistic restoration of the project area, the aim is to turn the area into a thriving landscape with active ecosystem services and provide a haven for biodiversity.
#Cooling #Tower #Water #Treatment #Chlorination #Legionella #Training #AWT
The Health and Safety Committee (HSC) Approved Code of Practice (ACOP L8) Fourth Edition places particular importance on the training of personnel at all levels within a company. The need for training is explained in paragraph 50 of the Approved Code of Practice L8, which states: “Inadequate management, lack of training and poor communication are all contributory factors in outbreaks of legionnaires’ disease. It is therefore important that those people involved in assessing risk and applying precautions are competent, trained and aware of their responsibilities”. You can see the full list of courses at https://www.advanced-water.co.uk/training-academy
It is seen that those individuals having active roles in the safe management of water need to have the correct level of knowledge and understanding to carry out their roles and responsibilities adequately. The Advanced Water Technologies Training Academy therefore offers a wide range of training through its fully accredited Ofqual courses, as well as non-accredited courses, online toolbox courses, seminars and webinars. This wide and varied range helps cater for all levels of business requirements, as well as providing flexible learning settings to suit each individual attendee.
Advanced Water Technologies Training Academy offers a wide range of targeted courses.
AWT have various courses currently being offered across the UK by Advanced Water Technologies Training Academy; all being delivered by our highly experienced subject-matter experts:
The Advanced Water Technologies Training Academy Can deliver these courses where and when you want them. We understand it’s not always convenient to travel away from your place of work, this is why each course listed above can be delivered exclusively to your company at your site, or remotely via Teams/Zoom. With up to ten candidates per course this makes it the most cost effective way of funding your training needs. To arrange a date, please contact us at training@advanced-water.co.uk
If you do have a number of candidates wishing to take any of the courses the Training Academy operates Open Courses; where you can join with other candidates from other companies/organisations. Open Courses are delivered at either our Barlborough Training Academy venue or remotely via Teams/Zoom. Please see the booking section for available dates and booking form.
#Cooling #Tower #Water #Treatment #Chlorination #Legionella #Training #AWT
Advanced Water Technologies are pleased to announce the successful acquisition of SPES Water Compliance, Cannock. A warm welcome is offered to all the SPES staff who are joining the ‘AWT family’, and that is extended to all SPES clients.
This signals a positive move for the future for both SPES and AWT, strengthening the range of services and capabilities that can be offered to all of our combined clients. Additionally, it provides an established base for all of our staff to operate from in the Midlands region. Through expansion and acquisition AWT now has offices located in Warrington, Barlborough, Cannock and Bexley with teams of Sales and Account Managers, and Service Technicians working from each. With warehousing and distribution focused at Barlborough and Warrington.
AWT can assist you with all your Water Treatment needs including Legionella Control in domestic water systems, Evaporative Cooling Systems, Steam Boilers, Heating and Chilled water systems, mains water and building chlorination, training, and other process water systems of your business, for more information www.advanced-water.co.uk.
#Cooling #Tower #Water #Treatment #Steam #Boilers #Chlorination #Legionella #Training #AWT
Advanced Water Technologies have worked closely with one of their long standing clients to improve, and develop, a safer and more efficient dosing system that is linked to their Steam Boilers, which further provides for a greater level of control in their plant and equipment. Contact Advanced Water Technologies to see how we can help you with your plant and equipment.
#Cooling #Tower #Water #Treatment #Steam #Boilers #Chlorination #Legionella #Training #AWT
Why do you need a closed system treatment? Without effective water treatment, your closed system for central heating and/or air conditioning can suffer from corrosion, scale formulation, fouling and microbiological activity.
Without effective water treatment, your closed system for central heating and/or air conditioning can suffer from:
These four key factors reduce efficiency, put your system at risk, shorten plant life, and waste energy, chemicals and water charges. It’s a well-known fact that poor control of your closed system can not only put your processes at risk, but can also squander £1,000s in wasted energy, chemicals and water charges.
Welcome to the AWT solution
At Advanced Water Technologies, we have developed a comprehensive closed system treatment programme for effective management, improved performance and to keep your system operating safely and efficiently. These services include:
Because we are compliant with the latest legislation and regulations, particularly in the areas of health, safety and the environment, you can be sure that the solution we deliver will be high quality, reliable, cost effective and tailored to meet your exact requirements.
Chemicals we use in our cooling system treatment
#Cooling #Tower #Water #Treatment #Chlorination #Legionella #Training #AWT
Service Technicians undergo Cooling Tower Training, undertaking the Highfield Level 2 training package, along with practical sessions on cooling water testing at the Advanced Water Technologies Training Academy, Barlborough, improving and consolidating knowledge. This was a recent well attended course provided by AWT.
Want to discuss this service further? Call our experienced team on 01925 713273. At Advanced Water Technologies we want to keep you informed and we want to make sure that you have access to all the information you need. You can view all of our accreditations, find out about our services and view important links and legislation information. You can also call or email us by visiting our contact us page.
#AdvancedWaterTechnologies #WasteWaterTreatment #MetalworkingFluidsTreatment #WaterHygieneTreatment #SteamBoilerWaterTreatment #PaintBoothTreatment #LegionellaRiskAssessment #TrainingAcademy #CoolingTowerWaterTreatment #ClosedSystemTreatment #ChlorinationTreatment #WaterTreatmentChemicals
Advanced Water Technologies invests in new vans and a new look. After 21 years of trading Advanced Water Technologies have adopted a new logo and are starting a rebranding process. We present three of six new vans showing the new look Advanced Water Technologies logo.
Want to discuss this service further? Call our experienced team on 01925 713273. At Advanced Water Technologies we want to keep you informed and we want to make sure that you have access to all the information you need. You can view all of our accreditations, find out about our services and view important links and legislation information. You can also call or email us by visiting our contact us page.
#AdvancedWaterTechnologies #WasteWaterTreatment #MetalworkingFluidsTreatment #WaterHygieneTreatment #SteamBoilerWaterTreatment #PaintBoothTreatment #LegionellaRiskAssessment #TrainingAcademy #CoolingTowerWaterTreatment #ClosedSystemTreatment #ChlorinationTreatment #WaterTreatmentChemicals
Cleaning and Chlorination of water systems is essential to control water hygiene. Different water systems require different treatment and Advanced Water Technologies are experts in the disinfection of all types of water systems from new mains supplies to water storage tanks. Advanced Water Technologies uses directly employed, highly trained staff with relevant qualifications, such as the "Water Hygiene Blue Card", to ensure you have the confidence in our services. Find out more at https://www.advanced-water.co.uk/chlorination-treatment
Want to discuss this service further? Call our experienced team on 01925 713273. At Advanced Water Technologies we want to keep you informed and we want to make sure that you have access to all the information you need. You can view all of our accreditations, find out about our services and view important links and legislation information. You can also call or email us by visiting our contact us page.
#Legionella #Training #AWT
On Monday 23rd January 2023, the Home Office laid out the Control of Explosives Precursors and Poisons Regulations 2023 which make a number of additions to the Poisons Act to strengthen the framework in place for controlling the use of precursors and poisons.
These new measures will come into force on 1st October 2023 and include new requirements for reporting suspicious transactions, additional obligations on online marketplaces, and new requirements for businesses to pass information about restricted chemicals along the supply chain.
Advanced Water Technologies Ltd have taken steps with our suppliers but we must now look at you and our customers and advise you of your legal obligations. We have included links below which are clear and informative, helping you understand your legal duties. Please do take some time to familiarise yourselves with these, we are trying to keep you informed and compliant.
Therefore, if you are a business and use, or intend to use, any of the ‘Regulated Substances’ we require the attached statement to be signed and returned with a form of ID which is available here at https://www.advanced-water.co.uk/pdf/form-for-customers-the-control-of-explosives-precursors-and-poisons-regulations-2023.pdf
Validity: the statement will be valid for 12 months from date completed, or if the designated signatory changes we will require an updated statement. We will review this statement during the Annual contract review that is undertaken with your Account Manager. The outline list of products affected by this legislation is shown here at https://www.advanced-water.co.uk/pdf/product-list-control-of-explosives-precursors-and-poisons-regulations-2023.pdf
Please complete and send form and proof of identification to info@advanced-water.co.uk.co.uk by 30th September 2023.
#Legionella #Training #AWT
AWT Training course on 16th November 2023 at our training academy next door to Junction 30 on the M1 in Barlborough, Derbyshire. More details can be found at www.advanced-water.co.uk/training-academy or to confirm your booking please contact us at training@advanced-water.co.uk.
Is this course for you or your staff?
This Ofqual accredited course is aimed at staff involved in managing, supervising, and monitoring cooling towers and evaporative condensers to ensure the risk presented by Legionella bacteria is minimised and compliance is achieved.
Why should I attend?
This course is designed to raise awareness and reduce the risk associated with the waterborne bacteria that cause Legionnaires’ Disease. Delegates who attend this course will leave with an understanding of how to apply relevant legislation within their day-to-day duties, with a particular focus on the Health and Safety Executive’s Approved Code of Practice L8 and accompanying Technical Guidance HSG 274 documents.
On the completion of the course candidates will:
Course duration and accreditation:
This is a one-day course. Successful delegates will achieve a formal Level 2 qualification awarded by Highfield Qualifications Ltd. The qualification is accredited by Ofqual (the Qualifications and Examinations regulator for England and Northern Ireland) and sits on the Regulated Qualifications Framework (RQF).
#Legionella #Training #AWT
AWT Training course on 5th October 2023 at our training academy next door to Junction 30 on the M1 in Barlborough, Derbyshire. More details can be found at www.advanced-water.co.uk/training-academy or to confirm your booking please contact us at training@advanced-water.co.uk.
Is this course for you or your staff?
This Ofqual accredited course is aimed at staff involved in managing, supervising, and monitoring hot and cold systems to ensure the risk presented by Legionella bacteria is minimised and compliance is achieved.
Why should I attend?
This course is designed to raise awareness and reduce the risk associated with the waterborne bacteria that cause Legionnaires’ Disease. Delegates who attend this course will leave with an understanding of how to apply relevant legislation within their day-to-day duties, with a particular focus on the Health and Safety Executive’s Approved Code of Practice L8 and accompanying Technical Guidance HSG 274 documents.
On the completion of the course candidates will:
Course duration and accreditation:
This is a one-day course. Successful delegates will achieve a formal Level 2 qualification awarded by Highfield Qualifications Ltd. The qualification is accredited by Ofqual (the Qualifications and Examinations regulator for England and Northern Ireland) and sits on the Regulated Qualifications Framework (RQF).
#Legionella #Training #AWT
Advanced Water Technologies have partnered with a Rail Maintenance Company and have successfully had a number of Service Technicians complete and pass their Personal Trackside Safety Training course. This now enables AWT Staff to work on Trackside Facilities, as required, to support and deliver services on behalf of the partner company maintaining water systems.
#Legionella #Training #AWT
AWT Training course on 21st September 2023 at our training academy next door to Junction 30 on the M1 in Barlborough, Derbyshire. More details can be found at www.advanced-water.co.uk/training-academy or to confirm your booking please contact us at training@advanced-water.co.uk.
Is this course for you or your staff?
This Ofqual accredited course is aimed at staff involved in managing, supervising, and monitoring cooling towers and evaporative condensers to ensure the risk presented by Legionella bacteria is minimised and compliance is achieved.
Why should I attend?
This course is designed to raise awareness and reduce the risk associated with the waterborne bacteria that cause Legionnaires’ Disease. Delegates who attend this course will leave with an understanding of how to apply relevant legislation within their day-to-day duties, with a particular focus on the Health and Safety Executive’s Approved Code of Practice L8 and accompanying Technical Guidance HSG 274 documents.
On the completion of the course candidates will:
Course duration and accreditation:
This is a one-day course. Successful delegates will achieve a formal Level 2 qualification awarded by Highfield Qualifications Ltd. The qualification is accredited by Ofqual (the Qualifications and Examinations regulator for England and Northern Ireland) and sits on the Regulated Qualifications Framework (RQF).
#Legionella #Training #AWT
Advanced Water Technologies Ltd continued growth and success with 3 very positive acquisitions that have been completed in the past 3 months.
Advanced Water Technologies are pleased that they have been able to acquire DMAC Water Services through which it will continue to deliver services to a broad range of clients nationally, Pennine Water brings in a number of national clients and an ability to improve upon a number of services offered already, and finally the acquisition of CERTIFACT, a southern based water treatment company that will allow AWT to build upon its present successes in the South, South East and West, and home counties. Providing the AWT Southern Team with a base and support of a dedicated team of support staff. All 3 acquisitions confirm that Advanced Water Technologies ltd are a growing force within the industry, specializing in Water Treatment and all ACOPL8 services.
The Managing Director of AWT, Peter Barratt, welcomes those staff who have joined us through these acquisitions and is “looking forward to working with each and everyone of you”.
#AWT #Growth #Success
AWT Training course on 6th June 2023 at our training academy next door to Junction 30 on the M1 in Barlborough, Derbyshire. More details can be found at www.advanced-water.co.uk/training-academy or to confirm your booking please contact us at training@advanced-water.co.uk.
Is this course for you or your staff?
This Ofqual accredited course is aimed at staff involved in managing, supervising, and monitoring cooling towers and evaporative condensers to ensure the risk presented by Legionella bacteria is minimised and compliance is achieved.
Why should I attend?
This course is designed to raise awareness and reduce the risk associated with the waterborne bacteria that cause Legionnaires’ Disease. Delegates who attend this course will leave with an understanding of how to apply relevant legislation within their day-to-day duties, with a particular focus on the Health and Safety Executive’s Approved Code of Practice L8 and accompanying Technical Guidance HSG 274 documents.
On the completion of the course candidates will:
Course duration and accreditation:
This is a one-day course. Successful delegates will achieve a formal Level 2 qualification awarded by Highfield Qualifications Ltd. The qualification is accredited by Ofqual (the Qualifications and Examinations regulator for England and Northern Ireland) and sits on the Regulated Qualifications Framework (RQF).
#Legionella #Training #AWT
Advanced Water Technologies have worked with their partners to ensure a smooth project has been completed within an assisted living complex, replacing a leaking sectional cold water storage tank for a new one.
Receiving praise from the client on how the project ran from start to finish with minimal disruption, polite and courteous service from the team. A job well done.
#Legionella #Training #AWT
AWT Training course on 18th May 2023 at our training academy next door to Junction 30 on the M1 in Barlborough, Derbyshire. More details can be found at www.advanced-water.co.uk/training-academy or to confirm your booking please contact us at training@advanced-water.co.uk.
Is this course for you or your staff?
This Ofqual accredited course is aimed at staff involved in managing, supervising, and monitoring cooling towers and evaporative condensers to ensure the risk presented by Legionella bacteria is minimised and compliance is achieved.
Why should I attend?
This course is designed to raise awareness and reduce the risk associated with the waterborne bacteria that cause Legionnaires’ Disease. Delegates who attend this course will leave with an understanding of how to apply relevant legislation within their day-to-day duties, with a particular focus on the Health and Safety Executive’s Approved Code of Practice L8 and accompanying Technical Guidance HSG 274 documents. On the completion of the course candidates will:
Course duration and accreditation:
This is a one-day course. Successful delegates will achieve a formal Level 2 qualification awarded by Highfield Qualifications Ltd. The qualification is accredited by Ofqual (the Qualifications and Examinations regulator for England and Northern Ireland) and sits on the Regulated Qualifications Framework (RQF).
#Legionella #Training #AWT
AWT Training course on 20th April 2023 at our training academy next door to Junction 30 on the M1 in Barlborough, Derbyshire. More details can be found at www.advanced-water.co.uk/training-academy or to confirm your booking please contact us at training@advanced-water.co.uk.
Is this course for you or your staff?
This Ofqual accredited course is aimed at staff involved in managing, supervising, and monitoring hot and cold systems to ensure the risk presented by Legionella bacteria is minimised and compliance is achieved.
Why should I attend?
This course is designed to raise awareness and reduce the risk associated with the waterborne bacteria that cause Legionnaires’ Disease. Delegates who attend this course will leave with an understanding of how to apply relevant legislation within their day-to-day duties, with a particular focus on the Health and Safety Executive’s Approved Code of Practice L8 and accompanying Technical Guidance HSG 274 documents. On the completion of the course candidates will:
Course duration and accreditation:
This is a one-day course. Successful delegates will achieve a formal Level 2 qualification awarded by Highfield Qualifications Ltd. The qualification is accredited by Ofqual (the Qualifications and Examinations regulator for England and Northern Ireland) and sits on the Regulated Qualifications Framework (RQF).
#Legionella #Training #AWT
AWT Training course on 7th March 2023 at our training academy next door to Junction 30 on the M1 in Barlborough, Derbyshire. More details can be found at https://www.advanced-water.co.uk/training-academy or to confirm your booking please contact us at training@advanced-water.co.uk.
Is this course for you or your staff?
This Ofqual accredited course is aimed at staff involved in managing, supervising, and monitoring cooling towers and evaporative condensers to ensure the risk presented by Legionella bacteria is minimised and compliance is achieved.
Why should I attend?
This course is designed to raise awareness and reduce the risk associated with the waterborne bacteria that cause Legionnaires’ Disease. Delegates who attend this course will leave with an understanding of how to apply relevant legislation within their day-to-day duties, with a particular focus on the Health and Safety Executive’s Approved Code of Practice L8 and accompanying Technical Guidance HSG 274 documents.
On the completion of the course candidates will:
Course duration and accreditation:
This is a one-day course. Successful delegates will achieve a formal Level 2 qualification awarded by Highfield Qualifications Ltd. The qualification is accredited by Ofqual (the Qualifications and Examinations regulator for England and Northern Ireland) and sits on the Regulated Qualifications Framework (RQF).
#Legionella #Training #AWT
Advanced Water Technologies Training Academy is holding its next open legionella awareness course for hot and cold domestic systems on February 7 2023 at our Barlborough Training Academy close to the M1 motorway. Find out more at www.advanced-water.co.uk/training-academy where you can also book your place.
All our legionella courses are Ofqual accredited which is recognised by the HSE as demonstrating understanding and competence. Please see our website for further details of this and other courses and registration form.
Downloads:
Highfield Level 2 Award in Legionella FAQs
Hightfield Level 2 Award in Legionella Awareness Pathway 2023
#AWT #Training #Legionella
New air conditioning at our Head Offices as a precaution to avoid an environmental issue. Like many businesses we have continued to work with the AC that was first installed in our premises some 15 years ago and while it gets serviced and cleaned on a regular basis, we overlooked the environmental time bomb that was sitting adjacent to the premises – the system's gas.
Should the old system have leaked at any time we would have released up to 8 tonnes of CO2e into the atmosphere from one unit alone (we have 2). Therefore, this week we have installed new split AC units that, should things go wrong from a leak of gas, the CO2e release will be less than 3 tonnes. Additionally, the units will use less electricity which will impact overall Scope 2 emissions. Just another step in our ongoing journey for Carbon Neutrality.
#Legionella #Training #AWT
In its push for a greater level of sustainability and contribution to reduction of Greenhouse Gasses, Advanced Water Technologies are encouraging its staff to adopt ECOSIA as their default web browser. Starting in 2009 ECOSIA set out to build a platform that would allow users to contribute to their [Ecosia] vision to plant trees across the World. To date they have committed to and planted 166million trees, that’s an estimated 4.1billion tonnes of CO2 per annum. We are an SME doing our part to help the environment.
#Legionella #Training #AWT
AWT Training course on 7th February 2023 at our training academy next door to Junction 30 on the M1 in Barlborough, Derbyshire. More details can be found at https://www.advanced-water.co.uk/training-academy or to confirm your booking please contact us at training@advanced-water.co.uk.
Is this course for you or your staff?
This Ofqual accredited course is aimed at staff involved in managing, supervising, and monitoring hot and cold systems to ensure the risk presented by Legionella bacteria is minimised and compliance is achieved.
Why should I attend?
This course is designed to raise awareness and reduce the risk associated with the waterborne bacteria that cause Legionnaires’ Disease. Delegates who attend this course will leave with an understanding of how to apply relevant legislation within their day-to-day duties, with a particular focus on the Health and Safety Executive’s Approved Code of Practice L8 and accompanying Technical Guidance HSG 274 documents. On the completion of the course candidates will:
Course duration and accreditation:
This is a one-day course. Successful delegates will achieve a formal Level 2 qualification awarded by Highfield Qualifications Ltd. The qualification is accredited by Ofqual (the Qualifications and Examinations regulator for England and Northern Ireland) and sits on the Regulated Qualifications Framework (RQF).
#Legionella #Training #AWT
Season’s greetings from all of us and we wish you a Merry Christmas and a Happy New Year. We are taking orders throughout December and will be operational offering cover for all of our Water Treatment Services. We would like to thank everyone involved with our company including our employees, customers, suppliers and people who have been involved in projects and related activities.
At Advanced Water Technologies, we provide you with the highest standards in water safety and hygiene services for heating and cooling systems and other process water systems. Thanks to our comprehensive range of water chemical treatments and management programmes we are totally committed to creating safe working environments for our customers and their employees.We look forward to working with you in 2023. #AdvancedWater
This paper starts with direct quotes from two of the UK’s leading organisations in construction and building services. These quotes send a real message as to why it is so vitally important that we can start to understand how critical control of bacteria and biofilm is in closed circuits:
Indeed, during the late 1990s, some bacteria (particularly Pseudomonas) were linked to a series of damaging contamination problems. “It is much easier and more cost-effective to maintain microbiological control within a closed heating and cooling system than to clean up a badly fouled system containing the heavy build-up of biofilm”. - BSRIA BG29/ 2012. CIBSE in reference to the BSRIA guidance above goes on to state:
The symptoms of microbiological fouling included blockages at valves and strainers, sludge formation, and severe gassing affecting flow measurements and commissioning results. We all have a level of understanding as to what bacteria are; that they are ubiquitous, and we typically associate such things with living creatures and the effect we associate they have on them. To start understanding how bacteria can compromise closed circuits, we first need to understand what bacteria are to then be able to control their behaviour.
Bacteria are microscopic single-celled organisms and as such can live without a host, they can generate energy and make their own food, move freely and have the ability to reproduce themselves (binary fission) capable of doubling every 20 minutes. This set of attributes and what is key here allows bacteria to live in a multitude of environments: soil, water, plants and other living beings. It should be noted here that less than 1% of bacteria cause diseases in humans. We can split bacteria into two simple groups: Hereterotropic Bacteria and Autotrophic Bacteria.
Hereterotropic Bacteria
The group we need to focus on when considering controlling bacteriological activity is the Hereterotropic group as they include yeast, and moulds as well as bacteria in their categorisation. The main reason we need to consider this group primarily is their ability to use organic carbon as food (as opposed to autotrophs as they rely on sunlight for theirs (photosynthesis)). Finally, we do need to further understand how bacteria respirate as this is key in the creation of biofilm and the damaging effect they can bring. Here we can split groups into Aerobic Bacteria (requiring oxygen presence) and Anaerobic Bacteria (absence of oxygen (Hererotrophic bacteria).
These two respiratory processes follow as aerobic bacteria (typically *pseudomonas) colonise pipework surfaces and proliferate those parts of the system where dissolved oxygen is found. Once *pseudomonas starts to cover an area of pipework depleted oxygen level manifests; anaerobic bacteria, (which include such influential bacteria as Nitrite Reducing Bacteria (NRB) and Sulphite Reducing Bacteria (SRB)) themselves become a threat to pipework infrastructure where they can thrive. These bacteria are further discussed below in the section Biofilm and Pipework Failure.
Biofilm
We can now consider the behaviour of these bacteria in our closed system circuits. The most common process bacteria undertake is the production of biofilm. As we understand the ubiquitous nature of bacteria, we need to make assumptions that there is every likelihood that a number of bacteria are going to be introduced into our water systems including closed system circuits. Once introduced one of the most common bacteria that is likely to be introduced is a group of bacteria called Pseudomonads which are cited as initiating most biofilms identified within closed systems. There is no evidence to confirm that Pseudomonas is directly responsible for the issues listed in the sections below – other bacteria may be to blame. However, it has been found that where levels of Pseudomonas-like bacteria (pseudomonads) are high, the risk of these problems is increased. Pseudomonad levels are, therefore, increasingly used as an indicator of the biological quality of system water.
Such bacteria adhere to pipe walls and create a protective layer of ‘slime’ (Extracellular Polymeric Substances (EPSs) composed mainly of polysaccharides)) or biofilm as seen in the images below.
Note: Pseudomonads are more likely to grow in chilled water systems where no biocide has been dosed and can significantly reduce the efficiency of the cooling coil. Pseudomonads along with other species known as Psychrophiles actually prefer cooler waters at 0°C and below, hence here at ICS controlling and treating their presence we see as so important in the systems we manage. From the growth profile above we can see the vast spread of bacteria groups and their various growth profiles in different temperature settings. BSRIA BG 50/2021 states “All systems are therefore at risk of biofouling and should not be operated without the presence of a biocide”.
Such biofilms can harbour and allow the growth of multitude, numerous individual micro-organisms as well as capturing system debris. The challenge here is that Pseudomonads had been considered an aerobic organism, however, recent studies have shown that we are dealing with a highly adaptive bacteria that can also survive without the presence of oxygen. With a build-up of biofilm which can be rapid (given all the right conditions) we can expect a number of costly issues to occur:
1. Reduction In Efficiency
Biofilm is recognised as a thermal insulator; consider it similar to scale. However, the effect of biofilm versus scale is dramatic, having a fourfold increase; in simple terms 1mm of biofilm is equivalent to having 4mm of scale on heat transfer surface, with that the impact of approximately 4mm of scale increases fuel costs up to circa 50%.
As with any insulation material present, when a process’s basic function is to ‘lose’ heat, any disturbance to that process means a loss of performance and with that additional energy is needed to counter the thermal retention. This is why it is critical for the management of running an efficient system so that closed system circuits are protected from the formation and growth of biofilms and avoidable increases in energy costs. The illustration above (fig.3.) clearly highlights the significant impact the presence of biofilm has on the process of heat exchange against other recognised insulators.
2. Flow Restrictions
The formation of biofilms can become several millimetres thick and as a result (particularly in microbore pipework) significate compromise of flow rates; that is the ability to pass liquid in a system over a set period. This in turn affects the overall efficiency of a system and requires circulating pumps to increase their turnover (increasing energy costs) to be able to match the designed rates of flow. Further costly issues surrounding the impact on flow rates (due to biofilm ingress) are observed within strainers and control valves. Once biofilm(s) are allowed to become established within a closed system their removal is labour-intensive, time-consuming and costly.
3. Biofilm And Pipework Failure
The three pathways that biofilm and associated bacteria are seen to manifest corrosion in closed systems, which then leads to reduced performance and often premature system failure are:
4. Specific Detrimental Bacteria
Nitrite Reducing Bacteria – Nitrite is the main component of one of the most commonly used corrosion inhibitors for closed systems found in the water treatment market. Nitrite-based inhibitors are seen as a cost-effective way to protect closed circuits from electrolytic corrosion. However, the presence of NRBs leads to the nitrite component being broken down as NRB uses nitrite as an energy source, digesting it using the various enzymes it possesses. Due to the susceptibility to NRBs, it is therefore vital that should nitrite be a component of the water treatment inhibitor chemistry programme both microbiological, as well as water chemistry are regularly tested. Note: Some species of Pseudomonads are classed as NRBs therefore among these as having the potential to break down nitrite chemistry. Sulphite Reducing Bacteria – Unlike NRBs where the reduction of inhibitor chemistry is seen; SRBs metabolise sulphur found in water as their source of energy, and with that resulting hydrogen sulphide is produced in large quantities which in turn directly attacks iron, steel brass and copper. It’s to be noted that the presence of SRBs will also have albeit to a lesser effect on nitrite levels should it be used to protect the system.
Pitting effect of SRB on pipework
ICS Cool Energy has covered the biological and chemical processes in Bulletin #1 document: Chiller & Closed-Circuit Corrosion where the effect of biofilm build-up, NRB and SRB are discussed in relation to corrosion. In summary the main problematic micro-organisms found in closed circuit systems are bacteria, which can lead to the rapid build-up of biofilms in pipework and on heat exchanger surfaces causing a reduction in efficiency, flow restrictions and under deposit corrosion.
The Solution To Bacteria And Associated Biofilm: Treatment And Testing
As this paper has highlighted the potentially damaging and costly presence of biofilm (and bacteria) in closed circuits if not addressed. Evaluating the status of both protective chemistry and microbiological presence is fundamental to help ensure we have clean, efficient and protected systems, anything other is going to be costly. This is why proactive testing and where required, appropriate corrective treatment are undertaken. ICS Cool Energy follows all the latest standards and guidance helping to ensure best practices are assured. These best practices include, but are not limited to:
The issues that this paper has emphasised can all be avoided by deploying the correct water monitoring schedule and chemical programme.
The Advanced Water Technologies Training Academy launches the 2023 accredited Ofqual Legionella open course dates.
Please see our website www.advanced-water.co.uk/training-academy for further details of the available courses and booking form.
In need of legionella responsible persons training? Well the next Highfield Level 3 Award in Legionella Control for Responsible Persons (RQF) course is taking place at our Training Academy in Barlborough Derbyshire.
Please see the Training Academy pages on the Advanced water Technologies website www.advanced-water.co.uk/training-academy.
The build-up of biofilm within the closed circuit systems is one of the few key problems encountered during the maintenance. The build-up of biofilm and other detritus will not only affect water flow, but also prevent (film forming) corrosion inhibitors from working effectively with possibly catastrophic results. The key to the effectiveness of a corrosion inhibitor within a closed circuit system is ensuring complete contact of the inhibitor with the metal surfaces.
Cleaning out any “dirt & debris” from pipework can be difficult, however, it is made much easier using online cleaning products like the Multitreat SF XTRA. Although the UK market is already familiar with dispersants within most current inhibitors, the Multitreat SF XTRA has been specifically developed to work in synergy with existing inhibitors to mobilise both the “normal” detritus and biofilm within a system.
You can benefit both financially and environmentally by cleaning out any “dirt & debris” from the pipework. Especially you will:
The blend of cleaning and dispersing agents within Multitreat SF XTRA works to lift and mobilise system contaminants, enabling to effectively remove them when working in conjunction with a suitable side stream filtration unit.
ICS Cool Energy and AWT recommend a unique combined stainless steel magnetic bag filter housing known as ‘Greenlife’. The Greenlife effectively removes these contaminants on a two-stage approach, with all ferrous deposits attracted to a strong magnetic rod and the remaining dirt & debris collected via a bag filter.
The long-term effect of a build-up of biofilm, scale, or general deposits within a closed circuit should not be underestimated, as anaerobic bacteria will grow under the deposits. Their actions and metabolic byproducts, such as sulphuric acid, can cause rapid pin holing and failure - as shown in this example below:
Extensive pin-holing of this particular system occurred within days and the system required a complete replacement. Multitreat SF XTRA can not only prolong the life of closed circuit pipework, but also increase the efficiency of the systems in which it is used. For example, Multitreat SF XTRA can revitalise both chilled and heating systems. Partially blocked Fan Coils, Evaporators and Radiators that were not operating to their designed specification will begin to produce the desired heat exchange again as water will once again flow through them at optimal rates.
Multitreat SF XTRA is simple to use. The product should be added to the system through a suitable dosing pot, a dosing pump or manually into an area of high flow at a dose rate of 1% - 2% VV. The Multitreat SF Extra can be left within the system to circulate and allow a suitable side stream filtration unit to gradually remove contaminants. Initially a 50 micron gauge filter is recommended, reducing to 5 micron for finer filtration as the system is gradually cleaned.
After the Multitreat SF XTRA has been circulated, a suitable system inhibitor must be dosed to give continuing corrosion inhibitor protection throughout the closed system. All our closed circuit inhibitor products are compatible with Multitreat SF XTRA and contain polymers, which inhibit the formation of future deposits.
Advanced Water Technologies Ltd are proud to have demonstrated compliance with all standards required to obtain Kosher certification for their Boiler Water products.
Our certification covers the full 100% of the Kosher market including the Mehadrin strictly orthodox market. Please contact us if you would like to know more about these products and services.
Kosher certification joins our other accreditations and registrations supporting our operations.
Advanced Water Technologies Training Academy is proud to announce that from today you can now view all its new web pages here.
In the Training Academy section of the website, you can find details of our accredited and non-accredited legionella and water treatment/hygiene courses, look the course content of each course , available dates and book your place on line.

Advanced Water Technologies is a Highfield approved training centre.
Advanced Water Technologies Service Technicians have gone above and beyond this week while, undertaking Cleaning and Chlorination of water systems for a client across 3 sites, ensuring that the premises remain safe and bacteria free for the occupants, receiving praise from the client for their pragmatism and enthusiasm to complete the works despite a number of challenges along the way. If you need your premises water systems disinfecting please get in touch with Advanced Water technologies info@advanced-water.co.uk.co.uk
The widower of a gran who died of legionnaires’ disease while on holiday in the Caribbean to celebrate her 70th birthday has launched legal action against a tour operator. Lynn Stigwood caught the deadly bug during a 10-day stay at the Grand Sirenis resort in Punta Cana, Dominican Republic, in 2019 with her husband Melvyn. She started vomiting and suffering from diarrhoea and was struggling to breathe before being taken to a local hospital. She was placed in an induced coma before being transferred to Florida in the US for further treatment.
She spent the next month in a coma but never regained consciousness. She died on September 29, 2019, six days after her 70th birthday. Now, almost three years on from her death, lawyers have issued High Court proceedings against their tour operator TUI.
Source = www.walesonline.co.uk
Some showers in Parliament and a tea point area have been closed following the discovery of legionella bacteria, the House of Commons authorities have said. They have been shut as a ‘precautionary measure’ after ‘low levels’ of the bacteria were discovered during routine monitoring by maintenance staff. Some ‘isolated areas’ of the building are affected and a disinfection of the water system in those parts of the building has been carried out, according to a spokesperson.
Other water sources in the building remain safe to use. Legionella bacteria is naturally present in water systems and it can cause legionnaires’ disease, which is fatal in 10% of cases. It causes serious illnesses in people over the age of 50, those with underlying health conditions and smokers. The House of Commons spokesperson said: ‘As part of our routine proactive monitoring, our maintenance team have identified low levels of legionella bacteria in some isolated areas in Portcullis House.
Source = www.metro.co.uk
Inspectors found there was no effective oversight of risks, such as protecting staff and patients from legionella and fire safety. They said the practice did not stock all the required emergency medication. The temperature of the vaccine fridge was not properly monitored. The infection prevention and control policy and the privacy screens in the branch site were not properly maintained, raising "concerns".
As well as general services, the surgery offers maternity and midwifery services, family planning, diagnostic and screening procedures, surgical procedures and treatment of diseases, disorders or injuries. Inspectors said the surgery had recently undergone a merger with Queens Avenue Practice, resulting in the patient list size increasing from 7,000 to 11,000.
Source = www.hamhigh.co.uk
Advanced Water Technologies Ltd has demonstrated compliance with the CHAS standards in line with SSIP Core Criteria and UK H&S Legislation and has been awarded accreditation to the requirements of the CDM Regulations 2015, Membership No.: CHAS-153267, Contractor - Non-Construction.
CHAS joins our other accreditations and registrations supporting our operations. CHAS is the UK's leading provider of compliance and risk management solutions. Find out more at https://www.advanced-water.co.uk/accreditations.
Advanced Water Technologies have worked in partnership with a Refrigeration Company to ensure that a client has been able to get their new cooling systems running fully. Advanced Water Technologies have worked to install a full dosing system and provide passivation, clean and chlorination services on this project.
Advanced Water Technologies, in partnership with their client, have recently installed a new containerised control and dosing system for a cooling system. This is in support of a high-tech project linked to aerospace industry. For more information on our systems please contact Advanced Water technologies Ltd – info@advanced-water.co.uk.co.uk
BS 7592 - 2022 Sampling for Legionella updated version on how to take water samples has been released. The new standard brings BS 7592 in line with HSG 274 pts 1 – 3. Three new annexes, two of which are normative, include sampling to investigate incidents and outbreaks in hotels and other multi-occupancy buildings, and sampling to investigate incidents and outbreaks in hospitals and healthcare. The Informative annexe includes guidance on when to use respiratory protective equipment (RPE) and there have also been extensive updates to the guidance surrounding sampling plans.
Advanced Water Technologies take on another new site and are starting to address a number of issues with a dosing station. Clearly identifying the chemicals in use, providing MSDS sheets and COSHH Assessments at the point of use. New individual bunds are to follow on this week ensuring separation of products and reducing the risks to the site staff and AWT Staff. Safety is first in everything that AWT delivers.

Advanced Water Technologies are now offering a number of new training packages for the control and management of Legionella in Water Systems. They cover; The Principles of Legionella Control, Duty Holder and Responsible Person, Hot and Cold Water systems and Evaporative Cooling Systems. All of the packages are approved by Highfield Training Ltd and are OFQUAL/SCOTQual and WJEC approved. For more information on dates and prices, please contact us on 01923 713273, or email training@advanced-water.co.uk
More successful Dosing and Control system updates and improvements for some of our valued clients. AWT will specify, install, and manage requirements to make sure the best possible quality results are consistently delivered.
Watch out for more of our ‘Before’ and ‘After’ success stories from some of our new client sites. Exciting times at AWT.
The bike has been out for a few months now ready for the start of this season's cycling. This year, AWT Operations Manager, Mike Myers, has chosen two very worthwhile charities to support, both of which are close to him because of his former career in the Military and seeing first hand how these organisations support our veterans and injured service personnel.
Mike will be completing a ride for the RAF Benevolent Fund on 14th May 2022 and one for the Royal British Legion on 19th June 2022. All the sponsorship raised will be welcomed and provide valuable support to the work of both organisations. Please support Mike if you can by clicking one of the links below..
RAF Benevolent Fund - https://www.justgiving.com/fundraising/michael-myers6
Royal British Legion - https://www.justgiving.com/fundraising/poppyride2022-michaelmyers
A Wolverhampton hospital which closed after "increased levels of Legionella bacteria" were discovered has now reopened. Penn Hospital was closed and patients moved early last month after the bacteria was found and it has since been resolved.
All patients have returned to the hospital since the issue was resolved and it reopened again in April, hospital bosses said. The bacteria was found in the water system after routine testing at the hospital which has one inpatient ward for 24-hour care for older people with mental health needs.
Legionnaires' disease is contracted by breathing in contaminated water with bacteria then multiplying in the lungs - but it is not contagious. Deaths occur in 10 to 15 percent of the general population, but could be higher in some groups of patients, such as those with compromised immune systems, Public Health England (PHE) said.
Source = www.birminghammail.co.uk
Lessons have been learned about the health risks of legionella in empty buildings, Falkirk Council has promised. The council learned the hard way during the pandemic when tests showed high levels of bacteria including legionella and pseudomonas, following the initial full lockdown.
Councillors agreed to approve updated guidance on Legionnaires Disease at a meeting of Falkirk Council’s executive on Tuesday. Members heard that the council’s legionnaires disease policy has been in place since 2013 but this has now been made clearer in a “how to” guide. While the risk is low, the new document highlights the need to monitor water systems to ensure Legionella management control measures are effective.
Source = www.falkirkherald.co.uk
Yet another fantastic appointment for Advanced Water, this time for our North East/Scotland Region. We are delighted to have Dave McCarron join our growing team of highly experienced Account Managers. Dave will be a fantastic addition and is already strengthening and supporting our rapidly expanding operations, particularly across Yorkshire and further north, bringing years of experience in Water Treatment. He will be working closely with Simon Weaver and the rest of his team to ensure both our existing and new customer base receive the service and support they deserve. Welcome on-board Dave.
#awt #welcome #appointments #growth
Advanced Water Service Technicians undergo a refresher training session with Simon Jessop, Training Manager, using Highfield Training packages, at the Advanced Water Technologies Training Academy. Training included the delivery of level 2 award for legionella hot and cold systems for the EST's of the North of the UK. Nine staff members took part in the training day. Online/onsite training will be provided from an external perspective with real practical face to face later in 2022.
Highfield Qualifications is a global leader in compliance and work-based learning and apprenticeship qualifications and one of the UK’s most recognisable awarding organisations. They are regulated by Ofqual, Qualifications Wales, SQA Accreditation, the Council for the Curriculum, Examinations and Assessment (CCEA), and the Security Industry Authority (SIA). In addition to this they are also a government-regulated end-point assessment organisation (EPAO).
#awt #training #development
Our Advanced Water Technologies engineers have been busy refurbishing four cooling towers at commercial offices in Hampshire. Here they’ve installed replacement high efficiency drift eliminators in stainless steel frames and a new replacement Cooling Tower circulation pump.
Our cellular drift eliminators are constructed of an alternating series of corrugated and wave PVC sheets, assembled to form closed cells. The closed cell structure provides the greatest surface area for droplet capture in a given volume. The drift eliminators are engineered to maximise drift removal efficiency and minimise pressure drop. Benefits include:
#awt #cooling #towers #refurbished
We are delighted to announce yet another significant appointment to our Southern Regional Team. Dan Franco will be a fantastic addition and is already strengthening and supporting our rapidly expanding operations across Central and Southern England.
Dan brings a wealth of experience and invaluable technical knowledge to our clients. He will be working closely with Ian Moore and the rest of his team to ensure both our existing and new customer base receive the service and support they deserve. Welcome on-board Dan. #awt #welcome #appointments #growth
More exciting times for AWT - we are very happy to announce the recent arrival of Simon Weaver as AWT’s North East England and Scotland Regional Manager. This is an important appointment in ensuring that our rapidly growing customer base across this region is given the best possible care and service whilst also supporting our growth plans and the rest of the business.
Simon brings 20 years of valuable experience in the industry and will bring focus into the Industrial, FM and Building service sectors. He will be entrusted with overseeing the successful implementation of our expansion plans in Scotland and the North East and we are excited to have Simon with us as we grow and nurture our team and better support our amazing customers
A water supply colonised by bacteria is driving a £10.5million project to move mental health services across Bristol. Facing a £2million bill after legionella was detected at older buildings at Southmead Hospital in 2016, staff have fit costly micro-filters on every tap, frequently flushed them and rigorously monitored water temperatures, but it is not sustainable, according to a business case.
The issue affects all of Avon and Wiltshire Mental Health Partnership (AWP)’s wards at the hospital but is limited to its estate there, which also suffers from a £3.3million maintenance backlog and risks to patients from potential ligature points and poor sight lines that mean issues escalate before they can be addressed.
Source = www.bristolpost.co.uk
Lessons have been learned about the health risks of legionella in empty buildings, Falkirk Council has promised. The council learned the hard way during the pandemic when tests showed high levels of bacteria including legionella and pseudomonas, following the initial full lockdown. The bacteria - which can cause Legionnaires disease from stagnant water lying in empty buildings.
The discovery led to the temporary closure of all early learning and additional support needs child care hubs at the height of the pandemic, when only key workers' children were attending school in person. Councillors agreed to approve updated guidance on Legionnaires Disease at a meeting of Falkirk Council's executive on Tuesday. Members heard that the council’s legionnaires disease policy has been in place since 2013 but this has now been made clearer in a "how to" guide. While the risk is low, the new document highlights the need to monitor water systems to ensure Legionella management control measures are effective. It also gives detailed guidance on responsibilities and arrangements for monitoring legionella if the premises manager is not available.
Source = www.dailyrecord.co.uk
Users of Penrith Leisure Centre have been unable to use showers or washbasins after traces of legionella were found recently. The bacteria, which can cause Legionnaires’ Disease if left to develop, was found as part of the regular checks carried out by GLL, which runs the leisure centre on behalf of Eden Council. There have been no cases of Legionnaires’ Disease at the Southend Road centre, GLL said.
The company said it immediately isolated the water supply to the showers and sinks, following guidance from the Health and Safety Executive. A spokesman added: “Legionella is a natural bacteria found in water - so we would occasionally expect to find it during the regular sampling that’s part of our water management plan. There have been no cases of Legionnaires’ Disease at the centre".
Source = Cumberland & Westmorland Herald
A surgery has been vacated into temporary cabins for several months after bacteria that can cause lung problems was found in its water supply. Amersham Health Centre has moved its services into temporary buildings in its car park after Legionella bacteria was identified in its water system. Legionella is known to cause the pneumonia-type illness Legionnaires’ disease and a mild flu-like illness called Pontiac fever.
It is understood the discovery was made following “routine and precautionary testing” of the centre’s water system. People can get Legionnaires’ disease or Pontiac fever by inhaling droplets of water in the air containing the bacteria. Less commonly, by aspiration of drinking water containing Legionella (when water accidently goes into the lungs while drinking). The centre announced that essential works are underway to deal with the problem and that operations from the temporary buildings are expected to last eight to 12 weeks.
Source = Bucks Free Press
A Derbyshire GP practice has been rated as "inadequate" and placed in special measures over concerns about patient safety including delays in referrals for potential cancer and possible missed diagnoses. The service has been told it will be inspected again within six months and kept under review and if improvements are not made, action could be taken to close the service. The practice was told that it needed to submit an action plan to detail how the "serious concerns that put patients at risk would be addressed".
An action plan was submitted and the inspector's report said: "Special measures will give people who use the service the reassurance that the care they get should improve." A spokesman for the Village Surgery, at The Hub in Shiners Way, has said that the practice has "responded quickly and effectively to improve the experience and safety of our patients" with a number of changes and has welcomed the newly-published CQC report. A total of 13 concerns were highlighted in the report leading the inspectors to decide that the practice was "inadequate for providing safe care and treatment. It was unclear if the recommendations in the legionella risk assessment and facet surveys had been actioned.
Source = Derby Telegraph
Testing kit detects extremely low levels and multiple species of Legionella in single test. Problems with contaminated water are often assumed to be confined to developing countries. In fact, Legionnaire’s poses a potential threat wherever there is natural water or artificial water systems. This can include rivers and lakes and manmade structures such as swimming pools, jacuzzis, ice machines and water coolers. The risk rises where large numbers of people are present, in hospitals and hotels for example.
There are already strict regulations in place around regular water testing in public buildings. The problem is that current testing methods are slow and during this time the risk to public health grows and Legionella bacteria can cause potentially fatal pneumonia.
Source = Irish Times
A new recommendation to the Dutch government suggests a hybrid risk approach on Legionella bacteria monitoring in implementing the new EU’s tap water rules at member state levels. Detecting bacterial cultures of Legionella was one of the prominent bones of contention during interinstitutional negotiations on the revision of the Drinking Water Directive (DWD), which updated parameters of water quality set more than 20 years ago.
Among the updated parameters, European lawmakers decided to extend Legionella bacteria monitoring to every potable water system in the EU as part of a new risk assessment analysis. Cultures of Legionella bacteria can proliferate in warmer parts of water systems and cooling towers and then spread through the mist emitted by air-conditioning units in large buildings. There are more than 60 known Legionella species; however, according to leading health bodies, roughly 96% of Legionnaires’ disease is caused by just one specific species, Legionella pneumophila, which is also responsible for the deadly form of pneumonia.
Source = Euractiv
As part of DfE risk management support they are hosting a webinar on legionella management. This workshop will focus on a background in respect to legionella risk, including details on the virus and the law: The management arrangements encompassing a case study, outlining the consequences of failing to comply with the law.
As part of the risk management support RPA members are invited to a workshop covering:
Course style and format:
Both sessions will start at 10am, but delegates should log onto the webinar at least 15 minutes before the start. The sessions will be approximately 75 minutes in duration and will be delivered through a PowerPoint presentation, which includes a case study. We will also be including an opportunity for questions, where we can; we will answer at the time or take these away and e-mail you a response within 2 days.
Please also note that these workshops are free to attend with more information at https://www.eventbrite.co.uk/e/rpa-legionella-management-webinar-13th-january-2022-registration-186497528127
Advanced Water Technologies has dedicated 485 native broadleaf trees in Horse Pasture Wood, Ilkley. The trees will be planted in the Yorkshire Dales in partnership with Yorkshire Dales Millennium Trust. Since 2020, Advanced Water Technologies have dedicated 897 trees in the Yorkshire Dales.
Over the next 50 years these will offset approximately 150 tonnes of carbon.
Advanced Water Technologies are launching, for 2022, an exciting Graduate Training Scheme. As an established and expanding Water Treatment Company we are seeking to recruit a recently qualified graduate, or a person graduating in 2022, with a Science based Degree (Chemistry preferred but not essential) to fulfil the role of Graduate Trainee Water Treatment Technician. The aim of this position is to expose the successful applicant(s) to all aspects of the business and across a 2-year training programme, developing the direction for the trainee appropriate to their skills and attributes: – Chemist, Account Management, Product Development. This is a full time role and permanent position.
Applications can be made by sending CVs to info@advanced-water.co.uk.co.uk
Season’s greetings from all of us and we wish you a Merry Christmas and a Happy New Year. We are taking orders throughout December into 2022 and will be operational offering cover for all of our Water Treatment Services. We would like to thank everyone involved with our company including our employees, customers, suppliers and people who have been involved in projects and related activities.
At Advanced Water Technologies we provide you with the highest standards in water safety and hygiene services for heating and cooling systems and other process water systems. And thanks to our comprehensive range of water chemical treatments and management programmes we are totally committed to creating safe working environments for our customers and their employees.
A cosmetic surgery in Reading's town centre which failed to adequately check for legionella bacteria risks has been told it must make improvements following an inspection. A recent Care Quality Commission (CQC) inspection found Chiltern Medical on Broad Street requires improvement. This follows an inspection from the CQC last year which found the company’s Goring site also requires improvement.
Although the CQC found the surgery “largely performed well”, it said it did not meet legal requirements relating to safe care and treatment and good governance. It said the service did not ensure all risks were assessed by a person with relevant skills and did not have effective governance processes to assess, monitor and improve the service. The surgery also did not always assess patients’ individual needs prior to attending an appointment. A key area of concern was the risk of legionella bacteria spreading due to the lack of risk assessments.
Source = Reading Chronicle
Hospital chiefs are predicting a £1.5m overspend as a result of "unforeseen" spending on Legionella works at Watford General. Legionnaires' disease is a lung infection people can get from inhaling droplets of water from things like air conditioning or hot tubs. It's uncommon but it can be very serious and is usually caught in places like hotels, hospitals or offices where the bacteria have got into the water supply. There is work ongoing at the Watford hospital to reduce the risk of patients catching Legionnaires' disease - but it is proving to be costly than first thought.
In a report to the West Hertfordshire Hospitals Trust board, chief financial officer Don Richards said the trust had been committed to deliver a break-even position on its spending for the financial year. But he pointed to the "unforeseen cost pressure" relating to Legionella works. He said that this was driving the forecast deficit position – expected to be £1.5m by the end of the 2021/22 financial year.
Source = Watford Observer
Advanced Water Technologies are supporting a large Automotive client through a number of upgrades to their systems which is now providing full telemetry with automatic corrosion monitoring. Filtration is undertaken using a Greenlife unit that has a multi-magnet filter with a final polish using a range of ‘bag filters’ 10 / 5 / 1 micron filtration. This development has provided a more stable system with a greater level of overall control.
Advanced Water Technologies would be pleased to be able to replicate this process with any client who is experiencing issues in the control and supply of the quality of process water in manufacturing environments. www.advanced-water.co.uk/latest-news #awt #water #teachnologies #treatment.
Advanced Water Technologies are proud to have increased the number of EVs on their fleet this year, and the availability of Charging points at their premises - supporting World ULEV Day fully. The Company plans to change the whole car fleet to a mix of full EV and Hybrid by 2023.
The fleet presently consists of 5 EVs and 2 PHEV's representing 39% of the fleet which will increase to 45% in October 2021. #awt #carbon #footprint #ulev
The latest addition to our rapidly expanding Southern Team. Natasha will be a fantastic asset within our expanding operations in the South of England and will be working with Ian Moore and the rest of the team to support the rapid growth of our customer base in that Region. We are delighted to have you join us Natasha. #awt #welcome #appointments #growth
RMT union calls for urgent meeting after ‘potentially lethal’ bacteria found in Thameslink trains. A union has declared a dispute with a rail operator, claiming there has been a “potentially lethal” legionella outbreak on its trains. The National Union of Rail, Maritime and Transport Workers (RMT) said it has prepared its members on Thameslink for strikes if urgent action is not taken to resolve the issue.
The company said a low level of legionella had been found in a small number of toilets, which had been drained and bleached. The RMT said seven toilets on four trains had actionable traces of the bacteria, which can cause legionnaires’ disease. The union claimed that, after the latest discovery, toilets were isolated, describing it as a “half-hearted and inadequate” approach, and called for an urgent meeting of the company’s safety committee.
Source = The Guardian
We are delighted and excited to welcome Shane Rawcliffe to the Advanced Water Technologies Southern Team. Shane will be a great addition to our expanding operations in the South of England. Shane will be mainly operating in Central London and working with Ian Moore and the rest of his team to support our existing and rapidly growing customer base in that region.
Welcome on board Shane.
We are very happy and excited to announce the arrival of Ian Moore as AWT's new Southern Regional Manager. This is a crucial appointment in ensuring that our rapidly growing customer base across the South of England is given the best possible care and service whilst also supporting our growth plans and the rest of the business.
Ian brings over 20 years of experience in the industry and will bring focus into FM, Building services and the Industrial sectors. He will be entrusted with overseeing the successful implementation of our expansion in the south and we are excited to have Ian with us as we grow and nurture our team and better support our amazing customers.
AWT has recently built, and installed, a multiple dosing system feeding 5 water storage tanks that works in tandem with the site's UV plant to ensure that the highest quality of water can be delivered constantly. A successful project from start to finish by Peter Nicholson of AWT working in partnership with the client’s team. AWT, working in partnership with you to find bespoke solutions that will meet your needs and keep you compliant with ACOPL8 and HSG 274 pts 1 – 3.
A school maintenance manager was unfairly constructively dismissed after he raised concerns about “exceptionally serious failures” in the management of a potentially deadly bacteria. Bev Parkinson, a former employee of Mears Facilities Management, was forced to resign after he was disciplined for highlighting problems with legionella bacteria at a group of schools within Highland Council.
The bug, which can cause Legionnaires’ disease if not properly handled, was discovered in five schools in the council area in 2019, with Mr Parkinson writing a report stating that Mears did not have proper risk assessments or testing regimes in place. The firm disciplined Mr Parkinson after he flagged his concerns and claimed he had brought the company into disrepute. He decided to resign and took his case to an employment tribunal and has now been awarded almost £9000 for constructive dismissal, with employment judge James Hendry finding that he was dismissed because he made a protected disclosure.
Judge Hendry said: “Given the clear public interest involved in ensuring safe water supplies in schools, it is apparent that the report contained public interest disclosures made by the claimant to his employers.”
Source = Herald Scotland
The showers on a hospital's maternity unit will not be in use for weeks after special equipment was installed to stop legionella from entering its water system. The filtering equipment had to be installed at Darlington Memorial Hospital after elevated levels of legionella was discovered during routine testing of water samples on the site.

A spokeswoman for County Durham and Darlington NHS Foundation Trust said no infections linked to the bacteria – which can cause Legionnaires' disease – had been identified in either current or recently discharged patients, adding that the situation was being monitored. But as a result, the trust has had to install filters connected to all showers and cold water taps to maintain the hospital's drinking supply. It means there is not sufficient water pressure on the maternity unit, which is at the top of the hospital, to allow women to have showers on either the labour or ante-natal ward.
Source = Northern Echo
Precautionary testing for Legionnaires’ disease in the water system at the Alderney Manor in Dartmouth is underway, after a family raised concerns following the deaths of two people who were living at the residential home owned and operated by Housing Nova Scotia. Candy Webber and Jennifer Crocker came forward with a complaint to the province after their father and brother died from pneumonia within the last month.

“Our father lived in the building on Alderney there and our brother Mark was living there and taking care of him,” said Webber. Their father Bill, who was 66 years old, was rushed to hospital on June 12 with difficulty breathing and died the next day from complications related to pneumonia and liver failure, said the family.
Source = Global News
Chlorine dioxide is an excellent biocide and disinfectant for a wide range of applications. We have recently implemented a Chlorine Dioxide system at a customer facility in the UK.

Applications can also include Chlorine Dioxide systems being installed at swimming pools and spas, whirlpools and hot tubs, drinking water, food and beverage production, water sterilisation, disinfection, environmental hygiene and industrial activity.
Summer weather sees a surge in the purchase and use of hot tubs - but there are health risks if you don't follow strict hygiene and safety guidance. Taking to a hot tub in the back garden with family or friends has become a popular warm weather pastime for thousands of Brits. But a seemingly harmless dip in the heated water can produce some very unpleasant side-effects and serious illnesses if you don't follow the proper advice for keeping the tub completely clean and germ-free.

There has been a renewed surge of interest in hot tubs as householders take advantage of the hot spell. So whether you are buying a hot tub or have one already, they need to be carefully looked after or they can turn into a breeding ground for bacteria and parasites. A number of germs causing illness and disease - in some cases life-threatening - have been linked to the ordinary hot tubs we see in back gardens across the country.
Source = Birmingham Mail
Aberdeenshire Council has been forced to close its city headquarters after a potentially deadly bacteria was found in the water supply. The local authority detected what is suspected to be legionella at Woodhill House during routine testing.

Aberdeenshire Council‘s main administrative base (the only in Scotland to be seated outside of its local authority area) will remain closed until bacteria experts give the all clear. A spokesman confirmed the find, emphasising no one had taken ill in connection. If inhaled in water droplets, the legionella bacteria can cause Legionnaires’ disease, a potentially fatal pneumonia-type lung infection. The bug can also cause a more mild flu-like illness called Pontiac fever. Numbers of employees working in the Aberdeenshire Council offices are still understood to be limited, due to the pandemic.
Source = The Press & Journal
Highland Council chiefs are on the look-out for a company that can check its water supplies for deadly Legionnaires’ disease. With many businesses and buildings closed for months, the chances of bacteria forming in the water systems is more likely.

Legionnaires’ disease is a lung infection you can get from inhaling droplets of water from things like air conditioning or hot tubs. It is uncommon but it can be very serious. The council is now re-letting its contract for the service, which has since 2018 been delivered by its own staff in-house with support from contractors as required. A spokesman said: “Due to the workload that the pandemic has created and the subsequent additional duties undertaken by the team, the council has now decided to re-let this contract".
Source = The Press & Journal
As Britain looks to return to the workplace, employees should be aware of a nasty surprise potentially waiting for them when they turn the taps on. Leading public health organisation, NSF International is urging vigilance from building managers to be aware of the legionella risk associated with their water supply.

With vaccines being widely deployed across the UK and the first easing of lockdown restrictions underway, businesses are beginning to prepare for the return to the office. However, COVID-19 has highlighted that buildings are not designed to be left alone for months at a time, and many were not prepared for the emptiness that followed. The reopening of such offices comes with the invisible threat of another lung infection, Legionnaires’ disease. On average, there are approximately 200-250 reported confirmed cases of Legionnaires’ disease each year in England and Wales but it is widely thought that the number of cases is underestimated. Low building occupancy has changed water use patterns, creating stagnant conditions favourable for Legionella growth. If inhaled, Legionella bacteria can lead to the potentially deadly Legionnaires’ disease.
Source = HR News
The final residents at Mary Feilding Guild are set to be moved out next week, despite the owner’s claims of unsafe levels of Legionella being disputed by health experts. Highgate Care said it had been advised by Public Health England that the most recent sample scores of bacteria at the home (over 100) were “of concern” and that the safe level for a care home is zero.

But Public Health England told this newspaper no samples above 100 have been reported in recent water sample testing at the care home. Highgate Care has come under fire for announcing its closure of the home (now renamed Highgate House) when it took over in March. It told 16 residents aged between 85 and 104 they had to find a new home by the end of May.
Source = Ham High
Advanced Water Technologies takes delivery of 2 fully electric vehicles in its bid to continually reduce CO2 outputs. We selected the Audi e-tron as a fully-electric mid-size luxury crossover SUV which was unveiled as a concept car at the 2015 Frankfurt Motor Show. It is the company's first electric mass production car, and was first delivered in May 2019. It has an EPA range of 204 miles (328 km), or 222 miles (357 km) in the updated model. We are looking forward to using these vehicles to service our customers across the UK.

The aim of this bulletin is to highlight water hygiene considerations in buildings and on sites where reduced occupancy has significantly decreased water consumption with the potential to have a negative impact upon water hygiene (quality).
The aim of the course is to fully equip people, with responsibilities for properties and sites that contain Hot and Cold-Water Systems, with the necessary skills and competence to understand their legal requirements and duties. You can book your training course here https://bookwhen.com/advanced-water#focus=ev-st9p-20210331000000

It will focus on the appreciation of risk posed by Legionella bacteria within these types of environments and how to successfully identify, risk assess and control them. The course will also briefly cover HSG274 Part 3, focusing on other types of Water-based Applications and delegate’s requirements for carrying out risk assessment and establishing control of these. (Please note - This course is not designed for people with responsibilities of Cooling Towers, Evaporative Condensers, or other similar Applications. These are covered in our 2-day Legionella Management for Responsible Persons Course).
Two written assessments will ensure that participants leave the course with the ability to control Legionella growth in these types of systems effectively. The course is accredited and certificated by IOSH.
The aim of this bulletin is to highlight water hygiene considerations in buildings and on sites where reduced occupancy has significantly decreased water consumption with the potential to have a negative impact upon water hygiene (quality).

All buildings and sites with reduced occupancy due to personnel working from home or furloughed during the COVID-19 emergency measures. The following legislation, Standards and ACoPs place a duty of care on the Employer to ensure a safe working environment for employees and visitors:
Legionella bacteria occur naturally in the environment, usually in water. Legionella can cause a type of pneumonia called Legionnaires’ disease, and a flu-like illness without pneumonia called Pontiac Fever. People are exposed by breathing tiny water droplets contaminated with Legionella from water fixtures such as showers, hot tubs, and decorative fountains. Building users may be at higher risk of exposure because of stagnant water conditions during the COVID-19 related shutdown and when full use resumes.

There are ways to safely resume water service in buildings that were closed or underused during the pandemic. When owners and maintenance staff reopen buildings, they should follow safety guidance to prevent Legionella and other opportunistic waterborne infections like:
Advanced Water Technologies are pleased to announce that we are now offering the following IOSH Accredited Training Courses for the Management and Control of Legionella, for all levels: Responsible Persons, Duty Holders, Property Managers and site personnel who have a role in this area. AWT strengthens their Training Courses for clients and can now offer:

For more details sales@advanced-water.co.uk
Advanced Water Technologies are pleased to announce that we will very shortly be offering a range of IOSH Accredited Training Courses for the Management and Control of Legionella, for all levels: Responsible Persons, Duty Holders, Property Managers and site personnel who have a role in this area. More information will follow but you can find out more in the meantime through your Account Manager.

At Advanced Water Technologies we provide you with the highest standards in water safety and hygiene services for heating and cooling systems and other process water systems. And thanks to our comprehensive range of water chemical treatments and management programmes we are totally committed to creating safe working environments for our customers and their employees.
A Facebook post shared hundreds of times has claimed that a woman who thought she had Covid-19 actually had actually contracted Legionnaires’ disease from her mask. The post reads: 'Mask wearers beware... Worth checking it out.'

A caller to a radio talk show recently shared that his wife was hospitalised and told she had COVID and only a couple of days left to live. A doctor friend suggested she be tested for legionnaires disease because she wore the same mask every day all day long. Turns out it WAS legionnaires disease from the moisture and bacteria in her mask. She was given antibiotics and within two days was better. WHAT IF these "spikes" in COVID are really something else due to mask wearing??”
This is incorrect. You cannot catch Legionnaires’ disease from wearing a mask. A US non-profit, Legionella, that raises awareness about the disease says, “You cannot contract Legionnaires' disease from wearing face masks. Legionella bacteria is transmitted by aspirating drinking water or breathing in water droplets. Legionella is not spread from person-to-person in respiratory droplets nor does the bacteria survive on dry surfaces. Your mask would not be a source of transmission for the Legionella bacteria.”
What is true is that Legionnaires’ disease and Covid-19 have some similar symptoms, high temperature and coughing. So it could be possible for one to be confused for the other, but Legionnaires’ disease is relatively uncommon and someone could not catch it from wearing a mask or face covering.
In a follow-up on the Legionnaires’ disease outbreak in the North Region of Portugal, health authorities have declared the outbreak over, according to the European Centre for Disease Prevention and Control (ECDC).

The outbreak in Póvoa de Varzim, Vila do Conde and Matosinhos counties, which began in late October, resulted in a total of 88 cases, including 15 deaths. The source of exposure has not been identified. Legionella bacteria occur naturally in the environment. Water containing Legionella can be aerosolized through cooling towers, showers, hot tubs, and decorative fountains, and can cause Legionnaire’s disease, a serious lung infection (pneumonia) when inhaled. Legionnaires’ disease is not passed from person to person.
Illnesses are most commonly associated with buildings or structures that have complex water systems like hotels, hospitals, long-term care facilities, and cruise ships. The bacteria can become a health concern when they grow and spread in human-made water systems, like hot tubs, cooling towers, hot water tanks, large plumbing systems, and decorative fountains. Most healthy people do not get Legionnaires’ disease after being exposed to Legionella bacteria.
Advanced Water Technologies provides specialist water treatment services and water treatment systems to customers across the UK. As such, we will continue to support our industry in any way we can. We are open for business across all aspects of our products and services for our customers. All employees, contractors and suppliers are operating within hands, face and space guidelines allowing us to process enquiries and fulfil orders. We are available to process any requests so please contact us for more information.

At Advanced Water Technologies we provide you with the highest standards in water safety and hygiene services for heating and cooling systems and other process water systems. And thanks to our comprehensive range of water chemical treatments and management programmes we are totally committed to creating safe working environments for our customers and their employees.
A secondary school has been ordered to close until the new year amid fears a busted boiler has increased the risk of pupils contracting Legionnaire's disease. Bosses from Simon Langton Girls' School in Canterbury was forced to shut for the rest of term following a visit to the site by officers from Kent County Council (KCC). The inspection by the local authority was carried out to check how the building's water system was working after one of its three boilers broke down last week, forcing children to remain at home.

It was ruled the current set-up increases the risk of Legionella developing. The bacteria can cause Legionnaire's disease, a severe form of pneumonia typically caught by inhaling Legionella from water. In a letter sent to parents, school head teacher Angela Scully confirms that the building had been ordered to remain closed for the rest of term. She stated: "Our hot water boiler is beyond short-term repair and we are currently running our heating and hot water off the two remaining boilers."
Source = Outbreak News Today
Season’s greetings from all of us and we wish you a Merry Christmas and a Happy New Year. We are taking orders throughout December into 2021 and will be operational offering cover for all of our Water Treatment Services. We would like to thank everyone involved with our company including our employees, customers, suppliers and people who have been involved in projects and related activities.

At Advanced Water Technologies we provide you with the highest standards in water safety and hygiene services for heating and cooling systems and other process water systems. And thanks to our comprehensive range of water chemical treatments and management programmes we are totally committed to creating safe working environments for our customers and their employees.
As part of Advanced Water Technologies drive to reduce our carbon footprint we have been very busy in other areas of our business and operations. Initial works have seen the introduction of solar panels, lighting changes, developments in Smart Internet technologies, hybrid cars (2 ordered 2019 & 1 in 2020), electric cars (2 ordered for 2021).

We started recording in Jan 2020 and year to date we have achieved:
The introduction of 2 electric vehicles will see fuel use drop by C2t of Carbon next year. No paper Christmas Gratuities removes 230kg of carbon from our footprint and they are replaced by 412 trees which is a 10-fold offset over the life of the trees; 1 sheet of printed of A4 paper produces 0.092kg of CO2, we estimated our Christmas diary giveaway amounted to 2500 sheets of paper = 230kg.
Advanced Water Technologies has dedicated 412 native broadleaf trees in Chapel Beck, Chapel-le-Dale in the Yorkshire Dales. The trees will be planted in partnership with Yorkshire Dales Millennium Trust and over the next 50 years these will offset approximately 2,400 tonnes of carbon.

Yorkshire Dales Millennium Trust is a small charity doing big things in the Yorkshire Dales. They help to look after the spectacular Dales landscape and support rural communities. Planting trees helps to reduce the impact of climate warming and biodiversity loss, creating more diverse and resilient landscapes where people can connect with nature. Together we have planted around 1.5 million trees in and around the Yorkshire Dales.
Paediatric patients have had to be transferred. Hull Royal Infirmary has closed a ward with the hospital after a Legionella was detected in the water supply. The bacteria, commonly found in water and can cause coughs, shortness of breath and fever, was detected in the hot water system of the 13th floor at the hospital. As a result, paediatric patients have been transferred to a different ward as treatment to the water system gets underway and new equipment is installed.

A spokesperson for Hull University Teaching Hospitals NHS Trust said: During routine testing our Estates team detected Legionella bacteria in the hot water system on the 13th floor of the Hull Royal Infirmary tower block. “Legionella are environmental bacteria commonly found in water, which may rarely cause lung infections if inhaled in high numbers. No patients or staff are ill as a result of this situation but as a precaution the water system is undergoing additional treatments and we are installing some new equipment.
Source = Hull Daily Mail
Lessons have been learned after the re-opening of several schools in Blaenau Gwent was delayed due to legionella bacteria in water supplies, council officials have said. An independent review carried out after the issue affected seven schools in the borough found “significant gaps” in the council’s legionella management plans. An online system of gathering information, more training of staff and improvements to flushing of water systems will be carried out after a review by Integrated Water Services said the council’s practices did not meet current guidance.

At a special community services scrutiny meeting on Tuesday, Cllr Lisa Winnett said the review was “very damning” and claimed the authority had been ‘failing’ students and staff. “Why have we not learned the lessons from what has happened?” she said. “If we have another lockdown with closures we could end up with legionella in our schools again." But council officer, Lynn Phillips, defended the council’s approach to school re-openings.
Source = South Wales Argus
Advanced Water Technologies is pleased to announce that it has won the Safety Contractor Of The Year Award for Toyota Motors located in Deeside. General Manager, Mairi Gordon from Toyota Deeside presented the award to Charlotte Brennan who is the account manager for Toyota UK representing Advanced Water Technologies.

Work in progress update for the Cooling Tower at RAF Odiham in Hampshire, England. The container is now complete and painted in NATO green. The cooling tower is fully assembled for with the hot/cold well tank connected (still to be painted). The images also show the cooling tower support structure with access ladders and platforms.

Photos showing the foldable mobile crane to be used for lifting out pump motors if needed. Royal Air Force Odiham or more simply RAF Odiham is a Royal Air Force station situated a little to the south of the historic village of Odiham in Hampshire, England. It is the home of the Royal Air Force's heavy lift helicopter, the Chinook.



Action has been taken after legionella bacteria was found in water supplies at a hospital in Stafford. Hospital bosses have confirmed a species of legionella bacteria has been found in St George's Hospital water supplies, but said it is not at a harmful level and no one has contracted Legionnaires' disease. Specialist advisers and water engineers have been monitoring the situation and have installed water treatment systems to reduce the risk.

Legionnaire's disease is a form of pneumonia caused by legionella bacteria. A spokesman for Stafford and Surrounds CCG said: “Legionalla is a bacteria that is common in many environments (in stagnant water) and a number of different types are evident. "Most people exposed to the species do not become ill but certain types are more harmful. The species identified in low flow water supplies at St Georges are not within a harmful level or a type of serious concern. No one has contracted legionnaires’ disease on the St George’s site and the water is safe for patients and staff. Water quality is monitored on a regular basis and action taken to improve it, if necessary."
Source = BBC
Part of the Royal Navy's headquarters has been shut after Legionella was found in the water system. Leach building, part of Navy Command headquarters in Portsmouth Harbour, has closed temporarily while the bacteria is treated and flushed out. It causes Legionnaires' disease, which is fatal in 10% of cases.

The First Sea Lord - the professional head of the Navy - is among the staff based at the building in HMS Excellent on Whale Island, Hampshire. There are no reports of staff with symptoms so far. A Royal Navy spokeswoman said there had been "no impact" on operations. Legionnaires' disease is a type of pneumonia, contracted by inhaling airborne water droplets containing Legionella bacteria. The droplets can be created by things such as hot and cold water outlets, atomisers, whirlpools or hydrotherapy baths. In May, Public Health England urged businesses to flush out the the hot and cold water supply in their buildings before reopening to prevent the bacteria from spreading.
Source = BBC
As COVID-19 stay-at-home orders lift in many parts of the country, people are tiptoeing back into everyday life. But office workers heading back to their cubicles may face a new danger hidden within air-conditioning cooling towers and other plumbing systems: water contaminated with the Legionella bacteria that cause Legionnaires’ disease — a serious type of pneumonia.

In May, the Centers for Disease Control and Prevention (CDC) warned that a period of inactivity in buildings could spur the growth of Legionella. When plumbing systems shut down, water becomes stagnant and chlorine and other disinfectants dissipate. The CDC cautions that when water isn’t in regular use, its temperature can range between 77 and 108 degrees F, which is an ideal breeding condition for bacteria. Large buildings may pose the greatest danger of Legionnaires’ disease. “Their extensive plumbing creates a great deal of surface area for biofilms to form,” says Amy Pruden, PhD, a professor of environmental and water resources engineering at Virginia Tech in Blacksburg. Biofilms are slimy layers of accumulated microorganisms, including bacteria.
Source = Everyday Health
Solihull businesses reopening after lockdown have been reminded of the risks of a waterborne bacteria which can cause a life-threatening pneumonia. Diane Hunt, who leads the council's food and safety team, said there had been a local drive to make outlets aware of legionella. Public health officials around the country have warned that water systems which had been out of use could provide a breeding ground for the germ, which can cause outbreaks of legionnaire's disease. Ms Hunt said that there had been a specific campaign to make borough businesses aware of the issue as they returned to buildings which may have been empty for months.
"Legionella is quite a high risk if water systems have been stagnant," she said. The Health and Safety Executive (HSE) said last month that risk assessments were needed when starting to use water systems again and also when restarting certain types of air conditioning units. The bacteria can cause legionnaire's disease if people breathe in droplets containing the micro-organism. "Employers, the self-employed and people in control of premises, such as landlords, have a duty to protect people by identifying and controlling risks associated with legionella," said a spokesman. Aside from possible problems arising in buildings which have been mothballed since March, there are also concerns that people who have recovered from Covid-19 could be at greater risk from an outbreak.
Source = Birmingham Mail
AWT operates out of 2 Office locations – Warrington is a purpose built 2 storey modern office facility within a business park, Barlborough is a warehouse and Office facility located on a mixed industrial/business park, the offices are spaced over 2 floors. Each building additionally has welfare facilities (toilets and kitchen areas). The normal 'static' staffing levels at each site are Warrington – 6, and Barlborough 3. Those levels will increase as field staff attend the respective offices. Warrington, additionally, has a 'lock-up' Warehouse that is unmanned and attended by field staff as required.
All AWT Staff undergo job specific training of which none covers COVID 19 Activities, however staff have received a Staff Briefing regarding the need for Hand Cleansing and Social Distancing in line with current Government Guideline's that are available from www.gov.uk/coronavirus>.
All AWT staff are issued with approved PPE that meets the requirements of the Personal Protective Equipment Regulations 2002 (SI 2002/1144). All PPE issued is marked with the appropriate EN standard. Personal Protective Equipment (PPE) in relation to COVID 19 is available to all staff and consists of: Face Coverings and Nitrile Gloves. Field staff, have in their vehicles additional PPE: Safety Boots/Hard Hat/Hi Vis/Chemical Resistant Gloves [Nitrile or PVC], Eye protection [glasses or goggles], half or full face mask [RPE].
Commercial insurers are scrutinising building managers’ efforts to avoid outbreaks of Legionnaires’ disease as they reopen movie theaters, gyms, schools and offices that had been closed for months due to the coronavirus pandemic, industry sources told Reuters. The pandemic shutdown of businesses and schools has led to an unprecedented amount of stagnant water in dormant buildings. It becomes a breeding ground for Legionella bacteria, which can be spread from toilets, sinks, showers and air-conditioning systems.

Some insurers are intensifying Legionnaire’s precautions before adding new clients or renewing coverage, insurers and brokers said. For instance, they may ask customers to document how they maintain plumbing and cooling systems. Large commercial office buildings and manufacturing plants have professional maintenance staff who likely kept water flowing throughout the crisis. Smaller buildings that insurers cover are at higher risk, experts said. To avoid contamination, they must flush and sanitize pipes and disinfect cooling towers that use water to lower air temperature.
Source = Insurance Journal
Hot tubs are becoming a more common feature in gardens around the North East but they can pose a danger to families. Hot tubs have become incredibly popular during lockdown as more people are forced to spend time at home and in their garden. It is a popular way to relax with your family, especially on a warm summer evening and sales have recently rocketed with eBay reporting hot tub orders rising by 1,080% in April, and 276% year-on-year from 22 March to 6 June. However there is a hidden danger that new hot tub owners may not be aware of - Legionnaires' disease.

Why is the hot tub a danger? The legionella bacteria can live in hot tubs, spa baths and even garden hoses. Kevin Wellman, CEO of the CIPHE commented, “While all man-made hot and cold water systems can provide an environment ripe for the Legionella bacteria to multiply, not everyone realises it can also thrive in places such as hot tubs, whirlpool baths, compost heaps and even garden hoses. The growing popularity in hot tubs means that many more families now have a potential source of an outbreak within their own gardens.”
Figures from Public Health England show a seasonal rise in cases from June to October.
Source = Chronicle Live
The Health and Safety Executive (HSE) has warned that commercial premises closed during the COVID-19 coronavirus lockdown are at an increased risk from Legionnaires’ disease. As car retailers prepare their showrooms ready for the June 1 reopening, the HSE has issued a warning that buildings closed or subject to reduced occupancy during the COVID-19 outbreak can suffer water system stagnation due to lack of use, increasing the risk of the potentially fatal disease.

The issue may affect hot and cold-water systems, cooling towers and evaporative condensers, commercial spa pools and hot tubs, it said. The HSE said that employers, the self-employed and people in control of premises, such as landlords, "have a duty to identify and control risks associated with legionella". Car retailers are among the businesses that have been told to review their risk assessment and manage the legionella risks to protect people when the water system is reinstated or returned to use.
Source = AM Online
During the unprecedented situation resulting from the Covid-19 crisis, many premises have faced complete closure or reduced occupancy. With businesses having to turn their mind to new and sometimes unexpected health and safety challenges, the Health and Safety Executive (HSE) has recently published guidance on managing legionella risks during the coronavirus outbreak. In this article, we consider the increased risks of Legionnaires' disease during lockdown, the HSE guidance and the measures that need to be put in place to control those risks to ensure safe re-opening.

Legionnaires' disease is caused by the growth of legionella bacteria in water supplies that are not adequately managed. The disease manifests as a type of pneumonia causing individuals to become seriously ill. Those most susceptible are over 50, smokers or have underlying health conditions. It has been estimated in Europe that Legionnaires' disease proves fatal in at least 10%of people. It therefore comes as no surprise that those who have been infected with the Covid-19 virus, or who are recovering and have a compromised respiratory system, are at increased risk of contracting Legionnaires' disease.
Source = Lexology
Hydrosense have developed a new on-site testing method for detecting deadly Legionella bacteria in water and biofilm. Hydrosense is the world’s only rapid testing kit for Legionella bacteria that can be fully conducted on-site, and requires no training or experience to carry out. As commercial buildings all over the world close up shop during the COVID-19 pandemic, many water systems will experience low flow or total system stagnation. This could result in an explosion of Legionella growth and unprecedented, widespread Legionnaires’ disease risk in the near future.

Legionella thrives in temperatures ranging between 20°C and 45°C. As nations move into lockdown, with populations working more from home and non-essential outlets being asked to close, the demand for water in commercial buildings will drop significantly. This in turn can lead to stagnation and can allow water in the pipes to reach ambient temperatures. This is especially true where boilers have been turned off.
Source = Envirotech Online
The focus of most organisations during this coronavirus pandemic has rightly been on the health and safety of employees and the general public in tackling the spread of the virus. As the ‘new normal’ settles in, and questions are asked about when we might return to work, organisations are advised to shift their focus from fire-fighting to business continuity planning and developing a strategy for the restart of operations. This will ensure organisations are best placed to tackle current concerns, as well as to respond when the Government restrictions are lifted.

It is anticipated by Public Health England (who undertake the national surveillance scheme) that there will be an increase in reported cases of Legionnaires’ disease from the 539 cases recorded in 2019 as a result of the current UK-wide lockdown. Organisations are encouraged to review their current water hygiene risk assessments to ensure the serious implications that arise from water stagnation are carefully reviewed and managed.
Source = SHP Online
Advanced Water Technologies ltd, like many other companies during these unprecedented times are continuing to monitor, and follow, the Government advice and guidelines to ensure the safety of our staff and clients alike with regard to COVID 19/Coronavirus. As a result we have introduced changes to our working practices; more home working, ceasing the number of client review meetings and any other meetings or travel.

Notwithstanding that, we would like to reassure all of clients and suppliers that as an Accredited LCA Company, we remain committed to delivering our services in the coming months to ensure compliancy, and the continued management of the risks associated with Legionella Bacteria, and other water borne pathogens. Operationally, we will respond to whatever adjustments our clients ask for to maintain this continuity of service and compliancy.
If clients must close their sites, we will be on hand upon the re-opening of those sites to carry out whatever work is required to ensure that bacteria have not proliferated during the closure period in water systems. Please, if you need advice during this period on how to continue the management of your water systems (whatever they may be), our staff are on hand to help. Working together as Service Provider and Client during these uncertain times we can manage the risks and continue to safeguard your staff, the general public and our staff.
HSENI WARNS of the risk from legionella bacteria associated with the operation of wet cooling plant. Legionnaires Disease can affect anyone and is of particular danger to the frail and elderly and those people who may have reduced or suppressed immune systems. It requires hospitalisation for treatment and can be fatal. In the current coronavirus crisis it is imperative that our health service is not put under any additional strain. Please ensure your wet cooling plant is maintained and operated safely at all times.

In this time of uncertainty where workers with responsibility for safety critical tasks and checks may be absent from work at short notice for long periods due to coronavirus it is vital that employers have the necessary measures and resources in place to ensure the continuity of safe systems. This will include adequately trained deputies and engineers to carry out checks and sampling as well as ensuring chemical supplies are maintained and dosed appropriately. Drift eliminators and fill packs must be in place and operating effectively.
Source = Health & Safety Matters
COVID-19 is a new illness that can affect your lungs and airways. It's caused by a virus called coronavirus. Please visit the official NHS website at https://www.nhs.uk/ for ongoing and updated information.

Source = NHS
Surrey and Borders NHS Trust says full tests and a deep clean were carried out at the Redhill mental health clinic. A mental health clinic had to be closed after an outbreak of Legionnaires’ disease among the staff. Three staff members at Gatton Place in Redhill are known to have been diagnosed with the bacterial illness. The community mental health hub in St Matthew’s Road was closed for five days while tests and a deep clean of the clinic were carried out.

Experts from Public Health England were brought in immediately. All services and health visitor teams were sent to alternative locations in the county and made different arrangements to see patients and people using the services. No source of the harmful bacteria was found and it was reopened on Tuesday (February 11). Surrey and Borders NHS Foundation Trust (SABP) runs the community hub, which offers services for adults in the Reigate and Banstead area with severe and enduring mental health problems. Fiona Edwards, chief executive, told a board meeting on Wednesday (February 12) that closing the site was a precautionary measure to check if the source of the disease was at the clinic.
Source = Get Surrey
Britain is facing a huge increase in Legionnaires’ disease fuelled by climate change, two water hygiene experts have warned. Water hygiene engineer Joe Finn and technology expert Florin Mangu, whose company Remote Tech develops smart systems to monitor the risk of legionella, believe that climate change represents a potential increasing hazard. The potentially fatal illness is spread via the legionella bacteria, which thrives within a specific temperature range in water systems.

Legionella can survive within a temperature range broadly between 20 and 50 degrees centigrade and proliferate in just 24 hours if water temperatures are around 37.5 degrees C. If inhaled into the lungs via water droplets, it causes Legionnaires’ disease. During a major outbreak, around 10% of cases can be fatal.
Source = Twin FM
One person has now been diagnosed with Legionnaires' disease after an investigation was launched at a Sandown hotel. The Isle of Wight Council confirmed last week high levels of Legionella bacteria, which causes the potentially-fatal water-borne disease, had been found at the Melville Hall Hotel and Utopia Spa.
The council's environmental health team ordered the Melville Road hotel to close its swimming pool and spa facilities. One man was swimming when environmental health officers descended on the hotel and told him to get out of the pool immediately.
Source = The County Press
The Central Florida federal prison in the midst of a Legionnaires’ Disease outbreak has five more cases, and at least one case of scabies, too. But state health officials won’t talk about what they’re doing to alleviate the public health issue.

Over the past few weeks, officials with the Coleman Federal Correctional Institution complex near Wildwood issued incremental responses to scores of health complaints, eventually illuminating an outbreak of Legionnaires’ Disease, a lung infection caused by breathing in water that contains legionella bacteria.
Source = Miami Herald
A newborn baby is believed to have been the first victim of an outbreak of Legionnaires’ disease at a Pimlico apartment block last year. Three people in three months are known to have contacted the potentially deadly lung infection at Dolphin Square. It has emerged that a five-day-old boy fell ill in a one-bedroom rented flat in Beatty House, part of the Dolphin Square complex, on 8th February last year.

The boy’s parents, who have asked to remain anonymous, have launched legal action against Dolphin Square alleging breach of the duty of care. He spent almost two months in hospital, where his condition became critical and he was transferred to Great Ormond Street. For several weeks it was not known whether he would survive. While receiving treatment at GOSH, it was found that legionella bacteria was causing his illness.
Source = The Standard
Complex hospital settings pose challenges to preventing Legionella growth. The number of Legionnaires' disease cases reported to the U.S. Centers for Disease Control and Prevention (CDC) increased more than eight fold between 2000 and 2018 to a record 9,933 cases. Further, we know the disease is largely underreported. In its extensive report, Management of Legionella in Water Systems, published Aug. 14, 2019, the National Academies of Sciences, Engineering, and Medicine conservatively estimated 52,000 to 70,000 people contract Legionnaires' disease annually in the U.S.

When evaluating where Legionella outbreaks occur, the CDC found 33% of all building-associated Legionella outbreaks occurred in a healthcare setting, 25% of healthcare-acquired Legionnaires’ disease cases are fatal and nine out of 10 outbreaks could have been prevented had a properly designed water management plan been implemented.
Source = Water Quality Products
We would like to take this opportunity to say thank you to everyone involved with our company including customers, staff, suppliers and partners for your support during the year. We are looking forward to 2020 and working with all of you again next year. Season’s greetings from all of us and we wish you a Merry Christmas and a Happy New Year.

We would like to wish our customers & suppliers the best wishes for the festive season. We have had an excellent year and are pleased to be moving into next year with a positive outlook. We have significant expansion plans and projects planned for 2020 and more news will be made available in this area over the first months of the year.
A bereaved partner has been left devastated on being told no firm will be prosecuted over the Capital’s Legionnaires outbreak of 2012. The deadly disease claimed four lives including labourer Bert Air and left 92 ill yet the source remains a mystery despite a seven-year probe.

Mr Air’s partner of 12 years, Catherine McDonald, has been notified that proceedings against two firms scheduled to start this month have been dropped by the Crown. “People keep saying it’s about the money - it’s not the money. I want an apology,” said a furious Ms McDonald, 61. “I want somebody to put their hand up and say ‘sorry, it was us, we apologise for what’s happened. To my knowledge, there’s a young lad out there in his 30s who’s still suffering from the actual after effects of legionnaires. Give the money to him, he needs it, not us. I’ve lost my partner, I can’t bring him back but he does, he needs a life." Mr Air, 56, came home ill from a building site in Gorgie with a suspected chest infection but was rushed to hospital by his frantic partner as fear gripped the city over the outbreak.
Source = The Scotsman
We recently carried out an installation of high level access doors (for accessing the drift eliminators) and installed fixed ladders and hand railing for safe access to the fan housings to three cooling towers in Scotland. Following on from a safety audit on one of our customers site, we identified access and safety improvements to three cooling towers. These improvements came in the form of; 1) High level access door for accessing the drift eliminators 2) Fixed ladder and hand railing for accessing the top of the cooling tower and fan housing.

AWT entered into planning discussions with a leading specialists in the repair and maintenance of Cooling Towers and Evaporative Condensers and formulated a schedule for the installations and worked with site to ensure we were able to complete the tasks ahead of schedule within a tight shutdown period.

Cases of Legionnaires' disease reached a record high in 2018 across the USA. This represents a more than eight-fold increase since the numbers began to climb nearly two decades ago. The Centers for Disease Control and Prevention reported this week 9,933 cases in 2018 of Legionellosis, which includes both Legionnaires' disease and Pontiac fever. Legionnaires' disease made up the vast majority of cases, according to the CDC.

The problem may be exponentially larger than what's reported to public health officials. The National Academies of Sciences, Engineering, and Medicine estimates that as many as 70,000 people may suffer from the disease each year, according to a report released in August. National news has been transfixed by the sometimes deadly cases around the country, from the four fairgoers killed and nearly 150 sickened by a hot tub exhibit at a North Carolina state fair in September to multiple hotel guests struck ill at the Sheraton Atlanta Hotel this summer.
Source = Medical Express
With legionella once again making headlines in England and Wales, HVP spoke with industry experts to discuss the causes of Legionnaires’ disease and what can be done in domestic and commercial properties to prevent its rise. Legionella is a hot topic in the heating and plumbing industry. But what is it, and what risks does it pose? According to the Health and Safety Executive (HSE), “Legionnaires’ disease is a potentially fatal form of pneumonia and everyone is susceptible to infection”.

It is caused by the growth of legionella bacteria in natural water sources such as rivers and lakes, and in purpose-built water systems. For instance, legionella bacteria can grow in spa pools, shower heads, and evaporative condensers. People can contract the potentially fatal disease by breathing in small water droplets (aerosols), which are suspended in the air and carry the bacteria. There are certain conditions which make the growth of legionella bacteria more likely. For example, it thrives in temperatures between 20-45°C. There are also certain deposits such as rust, sludge, and scale which can support bacterial growth by providing a source of nutrients. Additionally, where water is stored and/or recirculated, the bacteria has the potential to grow.
Source = Heating Ventilating & Plumbing
Any bacterium's ability to infect a person depends on its survival in the host (aka its victim). For Legionella pneumophila, which causes Legionnaires' disease -- a type of lung infection that spreads often though water systems in buildings -- commandeering host genes is one key to its survival. "Legionella is not the most widespread or deadly pathogen," said Michael Bassik, PhD, assistant professor of genetics. "But what makes it interesting is that this bacterium harnesses many of the same biological tactics to infect its host as a number of more serious pathogens. It also has unique characteristics that mimic more serious defects in the infected cell which look like other diseases, such as neurodegeneration."

Bassik and a team of researchers have tapped into Legionella's mechanism of infection with the help of prominent gene-editing tool CRISPR-Cas9, uncovering new genetic clues -- from the host -- that reveal how the bacteria takes hold. A paper detailing their findings appears in Cell Host & Microbe. Bassik and Shaeri Mukherjee, PhD, associate professor of microbiology and immunology at the University of California, San Francisco, share senior authorship.
Source = Stanford Medicine
Advanced Water Technologies Ltd have recently attained a grand slam of quality with our updated ISO 9001, ISO 14001 and ISO 45001. Achieving the upgrades and adding the ISO 45001 accreditation demonstrates our commitment to working within controlled Quality Management and Environmental systems whilst maintaining an excellent Health and Safety standard. All of which demonstrate our abilities to deliver a range of quality services and products to our customers.
ISO 45001 is an ISO standard for management systems of occupational health and safety, published in March 2018. The goal of ISO 45001 is the reduction of occupational injuries and diseases.
ISO 14001 is related to environmental management that exists to help organisations minimise how their operations negatively affect the environment; comply with applicable laws, regulations, and other environmentally oriented requirements; and continually improve.
ISO 9000 quality management systems standards are designed to help organisations ensure that they meet the needs of customers and other stakeholders while meeting statutory and regulatory requirements related to a product or service.
Bosses at a Leeds care home said they have "reassured residents and their families" after the bacteria legionella was found in water samples. The bacteria - which when inhaled is the most common cause of Legionnaires' disease - was recently found in samples taken at Donisthorpe Hall on Shadwell Lane but managers say there is no risk to residents. Legionnaires' disease is a type of pneumonia usually caused by breathing in mist from water that contains legionella.

Donisthorpe Hall is a nursing home that is currently classed as requiring improvement, following an August 2018 inspection by the Care Quality Commission (CQC) health watchdog. Managers say they have reassured residents and their families that there is no risk to residents or visitors following a health and safety check on its water system. Sue Cawthray, a trustee for the home, said: "During these checks, the bacteria legionella was found in some of the water samples. "The management team took immediate expert advice from the council and Infection Control experts, and all necessary steps have been taken both to address the weaknesses in the water heating systems and to keep residents safe while this is happening."
Source = Yorkshire Evening Post
People have been asked to flush taps, drain unused garden hoses and put commercial screen wash in cars to stop the spread of Legionnaires' disease. The warning from Public Health Wales comes as a cluster of 11 cases has been identified in the Vale of Glamorgan in the past 12 months. Legionnaires' disease is a lung infection caught by inhaling droplets of water that contain the bacteria.

Officials say there is "no evidence" the cases around Barry are linked. "Although Legionnaires' disease is rare, it can be a potentially life-threatening illness," said Dr Gwen Lowe, of Public Health Wales. "The disease is caught through inhaling Legionella bacteria, which are spread through the air in the form of vapours or droplets from a contaminated water source. Most cases of Legionnaires' disease notified to us are sporadic cases, but unexplained clustering does occur from time to time."
Source = BBC
The family of a man who died after contracting Legionnaires disease on holiday are taking legal action against tour operator Jet2. John Cowan - who would have turned 44 tomorrow - passed away on June 19 after falling ill while staying at the the Hotel Kalofer in Bulgaria. Now John's heartbroken family are launching a civil action against Jet2 after it emerged others are believed to have been struck with the same virus at the hotel. His brother Barry Cowan, 41, said: "We are all devastated."

Legionnaires' disease is contracted by inhaling small droplets of water in the air that contain legionella bacteria. Jet2 said it has been investigating and has transferred all customers and bookings for the summer to other hotels. The tour operator said two customers died while a third person affected was not a customer.
Source = Glasgow Live
Eleven former guests at a prominent Atlanta hotel have now been diagnosed with Legionnaires' disease while an additional 55 probable cases have also been linked to the same outbreak, officials said. "Probable cases" are people who have symptoms of the disease, including diagnosed pneumonia for some, but without laboratory confirmation. Medical investigators have not yet found the source of the bacterial infection that causes Legionnaires' a serious form of noncontagious pneumonia, said Nancy Nydam, director of communications at Georgia Department of Public Health.

"Based on epidemiological evidence we have an outbreak among people who stayed at the (Sheraton Atlanta) during the same time period," she said. Guests who complained of lung problems and were later diagnosed with Legionnaires' had attended a convention at the Atlanta hotel a couple of weeks ago. All 11 cases of Legionnaires' disease have been confirmed by testing and no deaths have been reported, said Nydam.
Source = CNN
Tests have returned positive for a Legionella bacteria at Greenfield Elementary School in Chesterfield County. The bacteria found on a cooling tower is from “a strain known to potentially cause illness. Though the LP1 strain was present in the cooling tower at Greenfield, it has not been confirmed that the bacteria at Greenfield is responsible for making anyone sick,” Chesterfield officials said in a news release Friday. The news is still alarming for parents.

The positive tests from the Centers for Disease Control and Prevention come after 10 cases of Legionnaires disease, a type of pneumonia, were confirmed in northeastern Chesterfield. “The county understands that the school division is working diligently to remediate the situation at Greenfield Elementary,” county officials said. “Moreover, subsequent tests at Greenfield will ensure the school is safe when reopened.” The school was closed this week and summer programs were moved to Weaver Elementary School.
Source = NBC
A warning has been issued over the high number of confirmed Legionnaires' disease cases in the Vale of Glamorgan over the last ten months. The source of the disease is unknown and there is no evidence that shows the nine cases are linked but the number is highly unusual for one area. On average, there are around 30 cases of legionnaires' disease in the whole of Wales each year.

Legionnaires disease is a rare but potentially life threatening lung infection that you can catch by inhaling droplets of water from things like air conditioning, hot tubs, and spa pools. Deaths may occur in approximately 10-15% of otherwise healthy individuals. You may also inhale the bacteria from other sources of water like showers, taps and toilets. Symptoms include a 'flu-like' illness with a rapid fever, muscle aches, tiredness, headache, loss of appetite, breathlessness and chest pain. Nausea, vomiting and diarrhoea may also occur.
Source = Wales Online
Health inspectors were called to The Bridge Secondary School which is part of a multi-academy trust in Carleton Road, London recently due to "low levels of Legionella bacteria" being found in the school's water. Legionella have also been found in water at a sports facilities managed by The Bridge and used by Beacon High secondary school (until recently called Holloway School), and at The Zone Youth Club in Carleton Road.

Unison's branch secretary in Islington Jane Doolan told the Gazette yesterday: "This is terrible. If there is Legionnaires' disease the building should be evacuated and the students and staff should all be tested. They all need medical advice at the least." She later added: "I talked to our rep at The Bridge and said there was suspected Legionnaires' disease and health and safety are there at the moment putting in some temporary measures; doing risk assessments and tests." A spokesperson for the Health and Safety Executive (HSE) said: "HSE is aware and is making initial inquiries."
Source = Islington Gazette
One person has died from legionella at Evergem, near Ghent, after health authorities declared an outbreak of the bacteria in the region which accelerated over a weekend. The patient died in Ghent’s University Hospital during May 2019, the Flanders Agency for Care and Health announced in a statement. The agency has currently identified at least 16 cases after it was reported that eleven infected people had been admitted to the hospital late last month. The most recently reported cases have prompted authorities to warn that the source of the infection was a paper mill.

A paper mill has been identified as a “probable source” of infection in a Legionella epidemic that broke out near Ghent and which has already claimed the lives of two people and infected dozens more. The Stora Enso company, which owns the paper mill, said that the Flemish Care and Health Agency had identified their paper factory as the possible source of the outbreak. “The Flemish Care and Health Agency in Belgium has identified Langerbrugge Mill as one possible source of the Legionella bacteria infection in the local community,” a company spokesperson said in a statement.
Source = Brussels Times
A patient died Sunday during an outbreak of Legionnaires disease, a severe type of pneumonia, at Grove City, Mount Carmel Health System, the Associated Press reported. Dr. Richard Streck, the hospital's chief clinical operations officer told the AP that it's too soon to know exactly what the patient died from.

The first patient to come down with Legionnaires had been admitted to the hospital April 29, the day after the facility opened. Legionnaires is caused by the Legionella bacteria, which can grow in water in building cooling systems. It's spread as people inhale contaminated water droplets, according to the CDC. Those most at risk are people with weakened immune systems or chronic lung disease, the agency says. The hospital is working with county health personnel to determine the cause of the Legionnaires outbreak. The Ohio Department of Health ordered the hospital to test its ice making machines and clean them. It's also been ordered to test and clean the building's cooling towers and give the test results to the department.
Source = Web MD
Reducing the risk: a 15-point plan for reducing the risk from Legionella. The risk of Legionnaires’ disease can be minimised. Hoteliers and other accommodation owners are recommended to follow the 15-point plan for reducing the risk from Legionella found on the Hotel Owner website.

With the Summer approaching, many people will be thinking of getting away for a few days. However, European statistics indicate that more than 1000 travellers contract the disease each year and according to the official statistics published by Public Health England, travel associated Legionnaires’ disease accounted for approximately 43% of all confirmed cases reported in England and Wales over the three year period from 2014 to 2016.
This level is typical of what can be observed year on year and is a matter that has not gone unnoticed by the authorities. In December 2017, the European Centre for Disease Prevention & Control (ECDC) published a leaflet entitled ‘Information about Legionnaires’ disease for managers of tourist accommodation', which offers guidance specifically for tourist accommodation including hotels, apartments and camping sites.
Source = Hotel Owner
Fatal Legionnaires’ disease has escalated 550 percent in the past 15 years. A new analysis model reported in AIHA’s The Synergist offers help for facility owners and operators who, due to new standards, are now responsible for preventing this 'quiet killer'.

A groundbreaking hazard analysis formula showcased in the April 2019 issue of The Synergist, the magazine of the American Industrial Hygiene Association, is expected to significantly aid users in preventing Legionella growth in buildings’ water systems. Designed by J. David Krause, Ph.D., MSPH, CIH, vice chair of AIHA’s Indoor Air Quality Committee and a nationally known expert in toxicology, public health and risk assessment, the tool evaluates the combined effectiveness of control measures used to prevent Legionella and other waterborne pathogens.
Recommendations to prevent Legionella growth in buildings’ water systems involve periodically measuring water temperatures, disinfectant or chlorine levels and other parameters. But the amount of data that water management programs generate can be overwhelming, and few tools are available to analyze the numerous variables used to assess these water systems.
Source = Globe Newswire
A woman died after contracting Legionnaires’ disease at a Ludlow hotel while on holiday, an inquest jury has concluded during March 2019. Elaine Esther Brown, 69, picked up the fatal infection at the Feathers Hotel where she stayed with her husband Graham on July 30, 2017. She died on August 26 at Royal Liverpool University Hospital from a stroke contributed to by legionella pneumonia.

Senior coroner for Shropshire, Telford and Wrekin, John Ellery, asked a panel of 10 jury members to decide from the evidence whether Mrs Brown contracted the disease at the Feathers Hotel or not. The jury unanimously decided on a narrative conclusion which was read out by Mr Ellery.
He said: “Mr and Mrs Brown stayed at the Feathers Hotel, Ludlow, where she contracted legionella pneumonia which contributed to her stroke and subsequently killer her. She died at the Royal Liverpool University Hospital on August 26 at 11.15pm.”
Source = Shropshire Star
Dire warning as deadly Legionnaires' disease is found lurking in nearly 80 per cent of household showers. Potentially fatal Legionnaires' disease has been lurking in household showers. 68 samples of domestic shows across Adelaide found 75 per cent had traces. Elderly residents, smokers and heavy smokers are most at risk of the disease.

The potentially deadly Legionnaires' disease is lurking in many household showers, a new study has found. Researchers took 68 samples from domestic showers across Adelaide and found 75 per cent were colonised with Legionella. Flinders University microbiologist and lead author Harriet Whiley says elderly residents, lung disease sufferers, and heavy smokers are most at risk of contracting the disease.
Source = Daily Mail
BSI, the business standards company, has released British Standard BS 8580-1:2019 Water quality, risk assessments for Legionella control – Code of practice. This is a significant revision to the 2010 British Standard providing further guidelines for assessing water quality and the risk of Legionnaires disease.
The standard gives recommendations and guidance on the assessment of the risk of Legionellosis presented by artificial water systems. Legionellosis is a collective term for diseases caused by bacteria of the genus Legionella, an opportunist pathogen which normally inhabits warm, moist or aquatic environments. The most serious and potentially fatal is Legionnaires’ disease.

David Fatscher, head of sustainability at BSI, said: “We shouldn’t underestimate the risk Legionnaires’ disease poses to society today, therefore having updated guidance and recommendations for its prevention is as important as ever. This revised standard aims to enable anyone with responsibility for the health and safety of others in public premises, across the spectrum from the workplace to hospitals, to undertake the necessary risk assessments and adopt adequate prevention measures.”
Source = Laundry & Cleaning News
The son of a woman who died after contracting Legionnaires' disease said the saddest thing is that his daughters will not get to know who she was. Elaine Brown, 69, died of a stroke after contracting legionella pneumonia from The Feathers Hotel in Ludlow. Tests found the same strain of the legionella bacteria in samples taken from a sink in the room in which she stayed, an inquest heard. A narrative verdict was given at the inquest in Shrewsbury. Son Neil Edwards said he needed time to take stock before deciding what action, if any, to take next.

Mrs Brown's death came months after another guest caught the disease but Public Health England did not tell anyone. The hotel subsequently closed but is due to reopen under new management following a refit. The coroner recorded that Mrs Brown died of a stroke at the Royal Liverpool Hospital on 26 August 2017. A key contributing factor of death was the contracting of legionella pneumonia at the hotel on 30 July.
Source = BBC
Part of a Devon hospital has been closed following the discovery of the potentially lethal bacteria Legionella. The Minor Injuries Unit at Totnes Community Hospital has been temporarily closed - following the discovery in taps and showers on the site.

The rest of the site - including inpatient wards and outpatient clinics - is continuing to operate as normal. The Hospital’s Minor Injury Unit (MIU), which is run by Torbay and South Devon NHS Foundation Trust, is being closed because it uses a lot of water and the site’s water system is currently being disinfected. Legionella is usually not a risk to people - but it can cause Legionnaires' disease, a form of atypical pneumonia, that in severe cases can be fatal.
Source = Devon Live
With many elderly residents suffering from various ailments they are especially vulnerable to Legionnaires’ disease. Legionnaires’ disease continues to pose a threat to public health in Essex.
In 2018, two cases involving Legionella outbreaks were resolved in court, the BUPA Care Home Case and the Tendring District Council Case. Investigations revealed that the care home administrators, despite being aware of the presence of Legionella, did little to address the problem. As a result of constituted negligence, the judge ordered that the care home paid fines and damages.

Meanwhile, Health and Safety Executive (HSE) officials found that Tendring District Council was negligent in a Legionella incident that happened last November 2016. At that time, a regular patron of the leisure centre took a shower but didn’t know the water was infected with Legionella bacteria. He was near death at the hospital, but doctors managed to save him.
During the investigation, staff working at the Tendring Leisure Centre were found to lack any proper training with regards to Legionella. Both employees and customers were also not aware that they were in danger of contracting the bacteria. The district court found the Council guilty of negligence and it was ordered to pay a £27,000 fine.
Source = In Your Area
Legionella Testing Market report offers leading manufacturers all around the world with challenges facing by them and their achievements through the several limits. The Legionella Testing market report provides a 5-year forecast (2018-2023) assessed based on how the market is predicted to grow in major regions. Top Regions in Legionella Testing Market include US, Canada, Mexico, UK, France, Germany, Italy, Spain, India, China, Japan, Australia, South Korea, GCC, South Africa, Brazil and Argentina.

Legionella Testing market analyse the market by countries, type, application, and manufacturers, with sales, revenue and market share by key countries in these regions. The Legionella Testing market includes regions, with sales and it Introduces product scope, market overview, market opportunities, market risk, market driving force. The cost of the report is $4250 per licence available from industryresearch.co/purchase/13104502.
Source = Dacca Times
A council has been fined £27,000 after an outbreak of Legionnaires' disease left a man fighting for life. Tendring District Council was investigated by the Health and Safety Executive (HSE) after a "catastrophic failure" at the Lifestyles leisure centre in Walton-on-the-Naze, Essex. Graham Leach contracted the disease in November 2016 after using the showers, Colchester Magistrates' Court heard. The council said it had since improved processes for managing legionella risk.

District Judge John Woollard said the council's fine would have been 10 times higher had it not been a public body. He said:
"This was a fairly catastrophic failure on their part to manage council facilities, in particular in the prevention of legionella in their leisure facilities. "I see from the hospital that treated Mr Leach that he was close to death, had they not treated him in time."
Source = BBC
We would like to take this opportunity to say a thank you to everyone involved with our company including customers, staff, suppliers and partners for your support during the year. We are looking forward to 2019 and working with all of you again next year. Season’s greetings from all of us and we wish you a Merry Christmas and a Happy New Year. Our last working day before Christmas will be Friday 21st December, which makes our last day for despatch of stock items Thursday 20th. We are open on Wednesday 2nd January. We would like to wish our customers & suppliers the best wishes for the festive season.

We have had an excellent year and are pleased to be moving into the next year with a positive outlook. We have significant expansion plans and projects planned for 2019 and more news will be made available in this area over the first months of the year.
A “cluster” of legionnaires’ disease cases in September left at least seven people hospitalised with pneumonia-like symptoms in the Guildford area of Surrey, British Columbia. Fraser Health Authority confirmed the “cluster” of cases on Saturday, September 01, and immediately began an investigation.

Legionnaires’ disease is a serious respiratory illness that results in pneumonia. It’s caused by the bacteria legionella, which is commonly found in freshwater, groundwater, and soil. Legionella can also spread in human-made water systems like cooling towers, hot tubs, fountains and large plumbing systems. When water contaminated with larger quantities of the bacteria is released into air in the form of droplets or mist, people may be exposed to the bacteria by breathing in contaminated air.
Source = Insurance Business Magazine
Legionella bacteria has been found in the Morris County jail water system, making it the third county-owned building to test positive since July, officials said Monday. The bacteria that can lead to Legionnaires' disease was also detected in water systems at the 283-bed Morris View Healthcare Center and at Homeless Solutions, a non-profit homeless shelter housed in a county-owned structure in Morris Township.

No one at the county correctional facility that averages a daily population of 200 inmates has been diagnosed with the disease, a severe form of pneumonia, county Administrator John Bonanni said. Tests showed no presence of Legionella at the county juvenile detention center and juvenile shelter, Bonanni said. The Southeast Morris County Municipal Utilities Authority supplies water to all the buildings that were tested.
Source = Daily Record
A fully automated testing device can now be deployed at water sites suspected of contamination by Legionella bacteria. The device promises more reliable results in less than two hours, with no human intervention. Between 5,000 and 8,000 cases of Legionella pneumonia – most known as Legionnaire's disease – are diagnosed each year in the European Union. There is no vaccine available and, in 12 percent of cases, extreme symptoms such as respiratory or multi-organ failure will result in the patient's death.

There are, of course, a set of available methods to detect Legionella in water – its main vector – before it risks infecting EU citizens. But these methods are not without drawbacks. Culture-based techniques, for starters, can lead to contamination risks being underestimated due to overgrowing competing microbiota and, in up to 20 percent of cases, they produce inconclusive results. Polymerase chain reaction (PCR)-based techniques – the only existing solution to monitor Legionella in environmental systems – also fail to deliver.
Source = Phys Org
OSHA has revised its safety and health topics page about Legionellosis to include updated information on preventing, identifying and managing workplace exposure to Legionella bacteria hazards. Legionellosis comprises Legionnaires’ disease, a potentially life-threatening type of bacteria-induced pneumonia, and Pontiac fever, a less serious affliction. About 6,000 cases of Legionnaires’ disease are reported annually, according to OSHA. The disease is not contagious and is treatable with antibiotics.

The National Institutes of Health states that Legionnaires’ disease typically is contracted by ingesting mist from water that contains Legionella bacteria. The water may originate from hot tubs, showers or air conditioning units in large buildings. OSHA updated both Chapter 7 of the OSHA Technical Manual and its Legionella eTool, a device intended to assist employers, health care providers, and safety and health professionals when inspecting jobsites for Legionellosis.
Source = Safety & Health Magazine
Legionella, the bacteria that causes Legionnaires' disease and other illnesses, has been confirmed in at least 12 of around 200 cases of pneumonia in Brescia, northern Italy, authorities said on Tuesday.
The bacteria, which is typically transmitted to humans by inhaling contaminated water, was present in one of two people who have died of pneumonia-like symptoms in the northern province in little over a week, according to regional councillor Giulio Gallera.

A 29-year-old man with legionella in his system is currently in intensive care, Gallera said. As of Monday night 235 people had sought emergency treatment for suspected pneumonia, and 196 were in hospital. Another 12 refused admission or have been discharged. Separately, a suspected legionella infection was reported on Tuesday in Turin, where a woman in her 60s and suffering from other health problems died in hospital with symptoms of pneumonia. Health authorities are investigating, according to Ansa, which reports that she may have picked up the bacteria while on holiday at the coast.
Source = The Local IT
Legionella can be fatal if it enters a building’s water system or other water-related areas. Six employees of an electrical company came down with flu-like symptoms after working in a client facility by the pier. The building’s sprinkler system had accidentally discharged while the employees were working inside.
Three went to their primary care provider where they were diagnosed with Legionnaires’ disease or Pontiac fever. However, none of the employees were diagnosed with pneumonia. All six employees fully recovered after three to five days.

The landlord of the building was notified and Legionella sampling was performed. The results showed Legionella Pneumophila Serogroup 1 (LP1) in a majority of potable water taps tested. This is the same strain that may cause Legionella Disease (LD), a potentially fatal pneumonia. The information was shared with the employer, who chose not to accept any future work involving this worksite due to the client’s lack of proper remediation of the worksite and the risk of exposing employees to LD with potentially fatal consequences.
Source = Property Casualty 360°
France/USA-based Infection Control Solutions expert aqua-tools has said that cruise ship and ferry operators must do more to protect passengers from contracting Legionnaires’’ disease and other infections from waterborne pathogens.

Concerned with the results from research that found higher levels of Legionella contamination in local ferries and cruise ships, aqua-tools’ CEO Marc Raymond said: “While larger, newer passenger ferries and cruise ships have been built with preventive measures aimed at curbing the spread of Legionella, little has been done to protect passengers aboard smaller, older ships which, in many cases, are not well maintained.”
The research paper to which Raymond refers is Legionella Risk Assessment in Cruise ships and Ferries, published in June 2017 by the US National Institutes of Health’s National Library of Medicine.
Source = Maritime Executive
An outbreak of Legionella bacterial infections in the Lombardy region of Italy has claimed three lives and affected a total of 26 people so far. Three elderly people have died in Bresso, a town 20 minutes north of Milan in the Lombardy region, from infection by Legionella pneumophila bacteria, local authorities have said. "The latest data tells us that 26 people living in Bresso in the last 12-13 days have contracted the bacteria, of which three unfortunately have lost their lives,” the local authority announced.

The mayor of Bresso, Simone Cairo, stated at a press conference today that "cases have a prevalent but not exclusive geographical distribution" in the area. "The situation is under my control. All the authorities that had to take action have been activated": Cairo said.
Source = The Local IT
Scientists at Porton Down found that 95% of water butts in Britain are contaminated with legionella bacteria. Homeowners who follow government advice to use water butts to hose their gardens and wash their cars risk exposing themselves to a dose of deadly legionella bacteria, scientists at Porton Down have warned.

They found that 95% of Britain’s 11m water butts were contaminated. Spraying such water from a hose or sprinkler could spread the microbes into the air over a garden, allowing them to be inhaled and to trigger an infection. “The presence of legionellae in collected rainwater and their aerosolisation through gardening activities like hosepipe use may have important public health consequences,” warned the researchers in a scientific paper.
Source = The Times
Eight lessons learned in the US from ANSI/ASHRAE Standard 188-2015, New York City cooling tower regulations, and the Centers for Medicare & Medicaid Services (CMS) Legionella requirement point to a strategy for preventing Legionnaires’ disease in the United States that is profoundly simple and almost entirely dependent on state health officials. Legionella is a borderless problem!

Despite government and industry warnings since the 1990s that building water systems must be properly managed to reduce the risk of Legionnaires’ disease and guidelines to explain how, only a small percentage of facilities have implemented preventive measures voluntarily. The anticipated spike in prevention from the release of ANSI/ASHRAE Standard 188-2015 in June 2015 turned out to be only a blip, even after the Centers for Disease Control and Prevention (CDC) urged compliance with the standard.
Source = Facility Executive
Bupa has been fined £3m after an elderly resident died from Legionnaires’ disease at Hutton Village Nursing Home in Brentwood, Essex. Ipswich Crown Court heard that Kenneth Ibbetson, 86, died three months after moving into the home in March 2015. A Health and Safety Executive (HSE) investigation found Bupa had failed to implement the necessary control and monitoring measures required to safely manage the home’s hot and cold water system for more than a year during refurbishment works.

It also found those responsible for overseeing Legionella controls and for taking crucial water temperature measurements had not been trained to the required standard. HSE principal inspector Vicky Fletcher said: “It is heart-breaking to think Kenneth contracted Legionnaires’ a matter of weeks after moving into the Hutton Village Care Home. His family have been left devastated by his sudden death.
“Mr Ibbetson and other residents were exposed to the risk of contracting Legionnaires’ disease because adequate controls were not in place. The risk is more acute in care home settings because residents are more susceptible due to their underlying health conditions. We would expect those who have a duty of care to understand this and have the necessary controls in place to manage the risk.”
Joan Elliott, managing director for Bupa Care Services, said: “Our thoughts are with Mr Ibbetson’s family and friends, and we are deeply sorry.
Source = Care Home Professional
Antimicrobial resistance (AMR) is a major medical problem worldwide, impacting both human health and economic well-being. A new strategy for fighting bacteria has now been reported in the latest online issue of Nature by a research group headed by Prof. Ivan Dikic at the Goethe University Frankfurt. The scientists revealed the molecular action mechanism of a Legionella toxin and developed a first inhibitor.

As resistance continues to spread, common infections such as pneumonia and salmonellosis are becoming increasingly harder to treat. Two factors drive the AMR crisis: human negligence in the use of antibiotics and a lack of truly novel antibiotics for more than 30 years. According to a recent report by the World Bank, by 2050, AMR may reduce the global gross domestic product by 1.1 percent to 3.8 percent, depending on which scenario plays out.
Source = Phys Org
A manufacturer has been fined £1.6 million after a Legionnaires’ disease outbreak and an explosion occurred at the same plant within a year. The Health and Safety Executive investigated and prosecuted car parts maker Faltec Europe Limited in relation to both incidents. Five people fell seriously ill following the Legionnaires’ disease outbreak and one worker suffered serious burns from the explosion incident.

On May 17, Newcastle Crown Court heard that between October 2014 and June 2015, two employees, two agency workers and a local resident fell seriously ill with Legionnaires Disease. The HSE found the illness was caused by Faltec’s failure to effectively manage its water cooling systems within the factory, causing the legionella bacteria within the water supply to grow to potentially lethal levels.
Source = FM.com
This past month Advanced Water Technologies has welcomed onboard their new Operations Manager – Mike Myers MBIFM M.W.M.Soc. Mike joins the business from another water treatment company, prior to that he was the Facilities Manager for a private school, and he served for 18 years as a Commissioned Officer in the Royal Air Force.
Advanced Water Technologies works hard to ensure that the services it delivers are compliant to ACOPL8 and associated HSG’s, and HTM04/01; supporting clients in the prevention and control of legionella and other water bacteria. To ensure this is the case, it is Mike’s aim to visit and audit every site managed by AWT in the coming 12 - 14 months. Additionally, ensuring that day to day operations of the Company are run smoothly and in accordance with company policies and procedures.

Mike is a keen cyclist and uses that passion to raise money for several charities each year. Most recently completing the Maserati Tour De Yorkshire event, raising funds for Maggi’s Cancer Care (his just giving page remains open!). His next challenge will be in July, when he will ‘Pedal for Parkinson’s’ – aiming to complete 500 miles during July.
The Royal United Hospital admitted health and safety failings following the death of a man in 2015. The family of a man who died in hospital in Bath after contracting a water borne disease say they hope no other family will suffer as they have, following an investigation which exposed risks to other patients. When Terence Brooks, 68, died from Legionnaires’ disease in July 2015 a breach in health and safety at the Royal United Hospital was exposed.

The Health and Safety Executive has warned the hospital’s failings are “concerning” today (April 20) after a sentencing hearing at Bristol Crown Court ended with a hefty £300,000 fine for the Royal United Hospitals Bath NHS Foundation Trust. An earlier inquest found Mr Brooks contracted the deadly legionella bacteria while on the William Budd ward, where he was a cancer inpatient.
Source = Somerset Live
Legionnaires’ disease has been on the rise in the United States since 2000, according to the US Centers for Disease Control and Prevention (CDC); although upwards of 6000 cases were reported in 2016, the CDC stressed that this may, in fact, be an underestimation. The reason behind this increase in cases remains to be determined; however, it is safe to say that the answer is multifactorial. One such factor is that there has been an increase in the susceptibility of people in the United States; the populating is aging, and there is an increasing number of individuals on immunosuppressive medications.

As the disease receives more media attention—with outbreaks constantly making headlines—Legionnaires’ has become a public health priority, and, as such, efforts to prevent the disease are expanding. Guidelines on controlling the disease have been developed, and regulations focused on improving clinical surveillance of the disease and water management in health care facilities have been put into place in certain jurisdictions.
Source = Contagion Live
A DNA test method called polymerase chain reaction (PCR) allowed New York City health officials to identify the source of a Legionnaires' disease outbreak within hours of specimen collection and should be considered in all Legionnaires' outbreak investigations, researchers say in the April issue of the Journal of Environmental Health.

Their study describes the outbreak response and innovative use of PCR rather than the standard method of bacterial culture, which generally takes five to 10 days for a lab to detect the presence of Legionella bacteria, said co-author Christopher Boyd, who led the city's response to the 2014 Legionnaires' outbreak as then-assistant commissioner of environmental sciences and engineering.
"In an outbreak investigation, the ability to identify and mitigate possible sources of exposure is critical to preventing more people from becoming infected. By using PCR, we were able to mitigate risks days earlier than if we had relied on traditional culture methods," said Boyd, who is now general manager of Building Water Health at NSF International, an independent, not-for-profit public health and safety organization.
"Our approach likely helped prevent more people from getting sick, because we were responding much sooner."
Source = Science Daily
Microarray rapid test speeds up detection in case of a Legionella pneumophila outbreak. In an outbreak of Legionnaires' disease, finding the exact source as quickly as possible is essential to preventing further infections. To date, a standard analysis takes days. Researchers at the Technical University of Munich have now developed a rapid test that achieves the same result in about 35 minutes.

Legionella are rod-shaped bacteria that can cause life-threatening pneumonia in humans. They multiply in warm water and can be dispersed into the air via cooling towers, evaporative re-cooling systems and hot water systems.
The most dangerous among the almost 50 species of Legionella is Legionella pneumophila. It is responsible for 80 percent of all infections. When an outbreak occurs, the source of the germs must be identified as soon as possible to prevent further infections.
Similar to a paternity test, the origin of the outbreak is confirmed when the germs in the process water of a technical system exactly match those identified in the patient. However, often numerous systems must be tested in the process, and the requisite cultivation for the test takes around ten days.
Source = Daily Mail
NSF International, a global public health and safety organisation, is hosting Legionella Conference 2018 - Managing Legionella and Other Pathogens in Building Water Systems on May 9-11, 2018, in Baltimore, Maryland. The three-day conference is sponsored by the National Science Foundation and marks the first time experts from industry, academia, public health, medicine and government will meet to discuss Legionella and other pathogens found in water distribution systems, building water plumbing systems and cooling towers.

Legionella Conference attendees will discuss and learn the latest monitoring, treatment and management approaches for successfully preventing the spread of Legionella in buildings, hospitals and other at-risk facilities.
Source = Outbreak News Today
The incidents occurred in Italy, but could also take place in the UK. Legionella bacteria thrive in warm, stagnant water, found at car washes. Legionnaires' disease affects around 500 people a year in England alone. People are choosing showers over baths and bacteria gather on the heads. Showers in 1.5 million homes across the UK could be harbouring such bacteria.

Visiting a car wash could be life-threatening, new research suggests. Two men became seriously ill with Legionnaires' disease after inhaling infected water droplets from separate car washes in Italy, a study found. According to microbiologist Dr Tom Makin, a senior consultant at Legionella control, the same risk applies in the UK.
Source = Daily Mail
A strain of legionella bacteria has been found in the plumbing system of a County Antrim nursing home.
It was discovered at Broadways Nursing Home in Larne in November. The Regulation and Quality Improvement Authority (RQIA) said, that while the bacteria is present, there has not been an outbreak of legionnaire's disease.

The entire water system at the home is being replaced to address the issue. The home said the issue would be resolved in the coming weeks. The RQIA said use of some taps in the home have been withdrawn and others restricted as a precaution. Tap filters and bottled water have also been provided to residents. The regulatory body has also notified the Health and Safety Executive.
Source = BBC
Lisbon, Portugal, the number of people infected in the latest Legionella outbreak in Portugal climbed to 13 in January 2018, the country's Directorate-General of Health (DGS) announced.

The outbreak was first reported on Sunday, with 4 cases detected at the CUF Descobertas Hospital in Lisbon. The number of infected has since risen to 13, of whom 9 are female and 3 are in intensive care.
The hospital's shower system is thought to be the most likely cause, with sink taps being investigated too. Legionella is a bacteria that lives in water. It is best known as the bacteria that causes Legionnaire's disease, a serious form of pneumonia.
In 2017, 233 cases of Legionella were detected in Portugal. In 2014, a Legionella outbreak in Vila Franca de Xira, a region in the east of Lisbon district, infected 375 and killed 12.
Source = Xin HuaNet
Legionella can plague marine vessels but an effective Water Safety Plan can help to mitigate the risk, says John Chillingworth, senior marine principal at Lucion Marine.
Initial symptoms of Legionella usually include flu-like symptoms such as headaches, muscle pain and fever, with symptoms of pneumonia once bacteria begin to infect the lungs. There are different degrees of Legionella: the worst can cause death but there is a lesser known form called Pontiac, which can often be misdiagnosed as flu and can only be accurately verified by having a urine test. While the Pontiac strain is like a severe five-day flu for fit people, it can be worse for older people or those with breathing difficulties.

The disease, which isn't contagious and can't be spread directly from person-to-person, is usually caught by breathing-in small droplets of contaminated water, usually in showers - it’s transmitted by an air-borne mist and can develop in still water between 20°C and 50°C. It can also lie dormant in otherwise ‘safe’ water systems for years, protecting itself in other matter available in the water system biofilm. It is therefore important that water supplies are kept below 20°C for cold water and 50°C for the hot supply.
Over the years there have been a number of high profile cases that have hit the headlines highlighting the risk of the disease in the marine environment, particularly among cruise ship passengers. Showers that have not been used for several days or weeks, along with poorly managed whirlpools, jacuzzis, spray from decorative fountains or water features, can all be sources for contracting Legionella-related illnesses. There have also been cases of shipyard fitters dying from Legionella after stripping down equipment such as pumps and being exposed to contaminated water.
However, all types of ships are at risk including off-shore accommodation vessels, which are known to have had several cases of the disease after being laid up and re-commissioned without the proper attention to potable (drinking) water safety. Container vessels have large potable storage tanks that are used infrequently, while skin tanks may prevent a ship’s water system from maintaining the cold-water temperature below 25°C.
Although there is far more awareness today of the risks of onboard Legionella and its effects, there’s a perceived lack of knowledge at both vessel management and crew level. There’s also a significant corporate risk with the potential damage to reputation, and operator integrity on the line, for anyone whose vessel is affected by the disease.
This all reinforces the need for a thorough Legionella risk assessment to be included as part of a preventative ship repair and maintenance programme and yards should be alerted to any potential risks before a vessel arrives in dock. A proper Water Safety Plan (WSP), as recommended by WHO Water Safety Guidelines, should be implemented and based on an individual vessel risk assessment, and not, as is usually the case, a generic set of broad guidelines. This must also be ‘owned’ by the vessel’s management.
Source = Maritime Executive
Bacteria responsible for the deadliest waterborne disease in the United States are frequent residents of the cooling towers that are a part of heating and air conditioning systems in apartments, hospitals, nursing homes, hotels, and other large buildings, according to a study from the U.S. Centers for Disease Control and Prevention.
Legionnaires’ disease, the pneumonia-like illness spread by Legionella bacteria, sickens thousands annually in the United States and kills hundreds. Cooling towers, because they can disperse contaminated droplets over many miles, are implicated in numerous outbreaks of the disease.
It’s a scenario that should concern building managers throughout the country, the study authors argue.

“Finding the bacteria in all regions that we studied makes us aware that Legionella outbreaks are a possibility everywhere,” Brian Raphael, a CDC microbiologist and study co-author, told Circle of Blue.
The bacteria, which grow in warm waters in plumbing systems, target the lungs. Infection occurs when people inhale bacteria, having become airborne in the spray from a cooling tower, fountain, showerhead, or faucet. The ill and the elderly are most at risk — and that risk appears to be growing. Reported cases of Legionnaires’ disease have risen sharply, showing a four-fold increase in the United States since the year 2000, according to the CDC.
The study’s publication comes as the National Academy of Sciences begins an investigation next month of how to reduce the risk of Legionnaires’ disease and as a series of infections at a state-run veterans home in Illinois has brought the disease to the attention of the governor and one of the state’s U.S. senators.
Source = Circle of Blue
The worst care homes in England for decent standards of care can be found right under MPs’ noses in Westminster, according to a new investigation by consumer champion Which?.
The lack of good quality care is by far the worst in the central London borough where almost seven in 10 beds (69 per cent) were found in care homes rated as below standard, analysis of Care Quality Commission (CQC) data found. Parts of the country have more than half of their care home beds in homes rated as requiring improvement or inadequate, the investigation reveals. In Manchester and Wakefield, three in five beds (58 per cent) are in below-standard homes, closely followed by Kirklees (57 per cent), in West Yorkshire, Portsmouth (56 per cent) and Tameside (55 per cent). A lack of quality care and increase in Legionella are directly linked.
In total, nearly a third of local authority areas, or 45 councils, have one in three beds or more in poor-quality care homes. Nine of these are in the capital with the wealth of the borough not seeming to play a role in outcomes: and Chelsea, one of the wealthiest areas, had almost exactly the same number of inadequate beds as Tower Hamlets, one of the most deprived areas of London. At least nine in 10 care home beds are in homes rated as good or outstanding in a small number of areas, including the Isles of Scilly, which had a perfect 100 per cent score, Richmond upon Thames (94 per cent), Rutland (91 per cent) and Blackburn with Darwen (90 per cent).
Source = iNews
Stainless steel sinks and kitchen taps could increase the risk of contracting deadly Legionnaires' disease, new research reveals.

Legionnaires' bacteria is found in highest concentrations in stainless steel taps. Such taps may encourage bacterial growth as their protective coating degrades. Legionnaires', which causes headaches and fever, has been linked to rust before
Researchers believe taps should be tested for their bacterial safety before sale. The growth of bacteria responsible for Legionnaires', which has previously been linked to rust, is highest in stainless steel taps, a study found. Such taps are thought to encourage bacterial growth as their protective coating typically degrades over time, promoting rusting, according to the researchers.
The European Centre for Disease Prevention and Control (ECDC) recommends people avoid Legionnaires' by keeping hot-water systems heated to between 50 and 60°C, as well as running taps regularly to avoid water standing for too long. Legionnaires’ disease, which causes headaches, muscle pain, fever and confusion, affected around 7,000 people in Europe in 2015, however, the ECDC believes there may have been many more unreported incidences.
Source = Daily Mail
The waterborne bacterial infection kills 1 in 10 patients who contract it. And fighting outbreaks is a multi-front battle.
Health officials are increasingly concerned about the continuous uptick of Legionnaires’ disease cases, which have risen steadily since 2000.
While the waterborne bacterial disease is relatively rare ― with 6,238 cases nationwide so far this year ― there has been a 13.6 percent increase in cases since this time last year. That’s nearly double the increase of 7.8 percent from 2015 to 2016 in the same time period.
The disease is not contagious. It’s contracted when people breathe in water droplets contaminated with Legionella pneumophilia bacteria.
“A person acquires Legionnaires’ disease from mist, ”Julien Martinez, assistant press secretary at the New York City Department of Health and Mental Hygiene, told HuffPost in October. “Most cases of Legionnaires’ disease can be traced to plumbing systems where conditions are favourable for Legionella growth, such as cooling towers, whirlpool spas, hot tubs, humidifiers, hot water tanks and evaporative condensers of large air-conditioning systems.”
Source = Huffington Post
Global public health organization NSF International has published a new protocol, which outlines proper maintenance and safety practices associated with evaporative cooling systems.

NSF P453: Cooling Towers – Treatment, Operation, and Maintenance to Prevent Legionellosis also addresses health concerns associated with commercial buildings, including health care facilities, whose residents may experience health issues such as Legionellosis from improperly maintained water systems. It can also be can be used by facilities to establish a management plan for the treatment, operation and maintenance of cooling tower water systems.
The protocol can be applied in Canada and references follow local regulations from the Authority Having Jurisdiction. It uses the water safety plan approach recommended by the World Health Organization to assemble a team, identify potential hazards and establish control measures to prevent the growth of Legionella bacteria. According to the Public Health Agency of Canada, fewer than 100 cases of Legionnaires’ disease are reported each year, but the actual number of infections could be much higher. Statistics are also worrisome in other parts of the world. In the U.S., 5,000 cases of Legionnaires’ disease are reported each year.
Source = Capitol Fax
Back in 2015, more than 50 residents of Quincy’s Illinois Veterans Home came down with Legionnaires’ Disease and nine veterans died.
The state spent almost $5 million upgrading the home’s water treatment system in 2016. But not long after that unveiling, two more veterans contracted the disease. And here we go again, two cases of Legionnaires’ disease have been confirmed at the Illinois Veterans Home Wednesday morning.

David MacDonna, a Public Information Officer with the Illinois Department of Veterans Affairs says Legionella tests came back positive for two residents. One of those residents is now deceased, however, the Illinois Veterans Home says the individual had a complex medical issue aside from Legionnaires’. The second individual is being treated for the disease. “We work continuously with the Adams County Health Department to identify any potential sources. We’ve done an extensive renovation, including a brand new water treatment plant to provide higher quality water,” said MacDonna.
Source = Capitol Fax
Spanish health chiefs are investigating the cases on Palmanova, the neighbouring resort of Magaluf, after positive samples of Legionnaires’ were found at an unnamed hotel.
An outbreak of Legionnaires’ disease has killed one tourist and left another 17 seriously ill on a Majorcan island popular with British holidaymakers. Spanish health chiefs are investigating the cases on Palmanova, the neighbouring resort of Magaluf.
Positive samples of Legionnaires’ have been found at an unnamed hotel where eight of the 18 people affected were staying. Experts are currently awaiting the results of tests at other hotels in the area, as well as fountains, beach showers and a local water park. Today it emerged one of the 18 people known to have been diagnosed with Legionnaires’ had died in Son Espases Hospital in Majorca’s capital Palma a week ago.
Source = Daily Mirror
In light of the recent threat posed by Legionnaires' disease to the UK water supplies, the HSE have implemented an Intervention Programme to protect cooling towers from becoming infected with this potentially fatal bacteria.
Legionnaires' disease is a serious form of pneumonia that devolves from the Legionella bacteria, known to reproduce most efficiently in stagnant water. In 2011, there were 235 reported cases of the disease in England and Wales alone. The HSE hopes that by auditing the UK's cooling towers, this number should be set to fall between 2012 and 2014, when the Intervention Programme will run.
The HSE has adopted the powers to take interventional action should they conclude that a tower's records/actions are not in compliance with ACoP L8. The audit looks for compliance in four main areas:
1. Risk Assessment
Ensuring that risk assessments are carried out every two years, or more frequently where changes occur. These should be able to effectively identify any potential sources of risk in order to eliminate them from the system.
2. Written Scheme
This should identify the accountability of each responsibility, setting out a clear 'who does what' procedure for dealing with potential risks. Details on site operation, risk assessments, cleaning and reviews should also be listed for the cooling tower.
3. Implementing and Controlling the System
This should detail system monitoring procedures, control parameters for water treatment and titles such as membership of the LCA for the water treatment company.
4. Record Keeping
Water treatment companies should have extensive and accurate record keeping detailing reports, external visits, log sheets and any relevant information relating to the site's cooling tower(s).
The HSE aims to effectively target the outbreak of legionnaires’ disease to prevent infection around the UK, by enforcing these standards with a combination of assessment and action.
For more information about Legionnaires' disease and for practical advice regarding its prevention visit the HSE site.
Alternatively, feel free to email us at info@advanced-water.co.uk.co.uk
Non oxidising biocides are used alongside oxidising biocides to ensure a low population of microbes such as legionella. Two non-oxidising biocides can also be used in an alternating programme as in certain circumstances a reduced efficiency can develop . Using them, one should monitor the microbiological activity in the cooling water on a regular basis by dip slide analysis and specific Legionella analysis on a quarterly basis.
Non oxidising biocides are chemicals that attack certain organs of the micro-organism. This may be the cell wall or reproductive system. Non oxidising biocides include Ammonium salts, Glutaraldehyde, DBNPH and Isothiazolinones.
All are very toxic so should be used usually in low doses to prevent damage to the environment when the cooling system is bled. They all have differing half lives and persistence so it is essential that the system volume and bleed rate of a cooling system are known so that a killing dose level is held in the system for the requisite time.
Relatively small doses are usually used. Between 50 and 300 ppm depending on the type of biocide and the cleanliness of the system water. It is usual to add them to the water using a suitable pump and timer system.
Addition to the cooling system should be based on the known half life. Essentially you should top up as soon as the dose concentration falls to below the killing concentration. Your Water Treatment contractor would be able to help with this.
In order to maintain an effective toxicity the cooling water should be monitored regularly for chemical and microbiological composition. This will ensure that microbial levels are kept at safe levels at all times.
To find out more about this subject please call our specialist team on 01925 713273, or email us info@advanced-water.co.uk.co.uk.
Through exposure to ultraviolet light, and copper and silver ionisation techniques, you can reduce microbial growth in your cooling system. This blog will discuss the processes involved in using the two techniques.
Both electromagnetic and ionisation techniques have maintenance issues but choosing the right antimicrobial system will ensure a safe cooling water supply.
By exposing micro-organisms to certain wavelengths of electromagnetic radiation you can maintain their populations at safe levels. This process is used to render drinking water safe and can also be used in process water systems. It is rarely used in cooling water systems.
Using wavelengths of 250 - 270 nanometres you can deactivate most harmful bacteria. Being light, it needs relatively clear water with low levels of suspended material to work. As such it is recommended that the water is filtered upstream of the light source to ensure that the light can reach the whole area being treated.
Dosages of UV light radiation are measured in milliwatt seconds per square centimetre (mW/s cm2). The minimum effective exposure is recognised as 20mW/s cm2. In order to maintain this rate it is important to regularly monitor the system and keep the light source clean.
This system can be used in conjunction with a free chlorine oxidising biocide. Copper and silver ions persist better in water systems in the presence of chlorine levels of around 0.2mg/kg.
Copper and silver ions kill bacteria by interfering with their cell walls. The best concentrations of copper and silver ions is between 15-20 microgrammes per litre.
This system is not recommended in hard water areas as limescale can cover the electrodes that release the ions into the water supply. pH levels are important in such treatment systems as silver ions won’t be maintained at a suitable level at pH 7.6 or above.
Legionnaire's Disease can be fatal. Making sure your cooling tower is correctly maintained is the best way to prevent an outbreak of the illness among the users of your building.
There are three factors to be aware of in cooling tower maintenance.
Many cooling systems are made of mild steel. Legionella bacteria love rust and use the Iron as nutrient in order to grow in numbers . Preventing corrosion of the pipes will reduce risks of Legionella reaching dangerous levels.
You will have run into limescale in your kettle or washing machine at home. This is an accretion of deposits from the water supply. As with rust, Legionella will form colonies on limescale deposits and from there may increase the risk of causing an outbreak.
Apart from rust and limescale there are other deposits that can form in the pipes of a cooling system. These include:
As with the rust and limescale these deposits will form a nice place for Legionella to colonise and become a risk. Keeping your cooling tower clean wherever possible will ensure that there is no build up of these deposits.
Considering the serious risks of a Legionnaire's Disease outbreak it is vital to maintain your cooling tower correctly to prevent serious illness or death.
Legionnaire's Disease can be a killer - it is very important you prevent a build up of Legionella bacteria to prevent such an outbreak of the disease. Routine monitoring will ensure a safe environment for everyone in the building where your cooling system operates.
You should monitor the environment in which the bacteria live in order to make it as unsuitable as possible for a build up to occur. You should also monitor overall and specific Legionella bacterial levels so you can prevent an outbreak as soon as possible before anyone is harmed.
Monitoring the environment includes pH testing, dissolved and suspended solids levels, dissolved and soluble Iron levels and water hardness. In monitoring these levels you can help minimise the bacteria from growing in significant numbers in the first place.
It is difficult to directly measure non-oxidising biocide levels in the cooling system so this must be done by calculating the volume of the system, the bleed off rate and half life of the biocides - the time it takes to reduce to a non-effective “killing“ dose.
It is possible to measure oxidising biocide levels, typically Chlorine, Bromine or Chlorine dioxide. This is done with a simple test and should be done regularly, the frequency depending on the type of system.
Bacterial levels themselves should also be monitored on a regular basis. In the next section we will discuss how to do this.
It is important that you have not recently given the system a biocide treatment just before as you will get false results.
Monitoring overall bacterial levels is done with a dip slide that has an Agar gel on it. The dip slide should be dipped in the water supply for approx.10 seconds, allowed to drain and then incubated for 48 hrs at 30*C. The slide is then evaluated by comparing it with a coloured chart. The level of overall bacterial activity should be less than 10,000 cfu/ml.
Monitoring overall levels of Legionella bacteria is done by taking a one litre sample and submitting it to an independent laboratory for a specific and involved test. Initial results will be available from 3 days after submission of the sample. The full test will be completed in 10-14 days. If a Legionella positive is confirmed then further action is needed. To be decided in conjunction with your Water Treatment supplier.
Legionnaire's Disease can be a killer - it is very important you prevent a build up of Legionella bacteria to prevent such an outbreak of the disease. Routine monitoring will ensure a safe environment for everyone in the building where your cooling system operates.
You should monitor the environment in which the bacteria live in order to make it as unsuitable as possible for a build up to occur. You should also monitor overall and specific Legionella bacterial levels so you can prevent an outbreak as soon as possible before anyone is harmed.
Monitoring the environment includes pH testing, dissolved and suspended solids levels, dissolved and soluble Iron levels and water hardness. In monitoring these levels you can help minimise the bacteria from growing in significant numbers in the first place.
It is difficult to directly measure non-oxidising biocide levels in the cooling system so this must be done by calculating the volume of the system, the bleed off rate and half life of the biocides - the time it takes to reduce to a non-effective “killing“ dose.
It is possible to measure oxidising biocide levels, typically Chlorine, Bromine or Chlorine dioxide. This is done with a simple test and should be done regularly, the frequency depending on the type of system.
Bacterial levels themselves should also be monitored on a regular basis. In the next section we will discuss how to do this.
It is important that you have not recently given the system a biocide treatment just before as you will get false results.
Monitoring overall bacterial levels is done with a dip slide that has an Agar gel on it. The dip slide should be dipped in the water supply for approx.10 seconds, allowed to drain and then incubated for 48 hrs at 30*C. The slide is then evaluated by comparing it with a coloured chart. The level of overall bacterial activity should be less than 10,000 cfu/ml.
Monitoring overall levels of Legionella bacteria is done by taking a one litre sample and submitting it to an independent laboratory for a specific and involved test. Initial results will be available from 3 days after submission of the sample. The full test will be completed in 10-14 days. If a Legionella positive is confirmed then further action is needed. To be decided in conjunction with your Water Treatment supplier.
To find out more about Legionella please visit the following links:
You can contact our experienced team on 01925 713273.
Almost all water systems in the UK are at risk of being contaminated with Legionella, the bacteria which causes Legionnaires Disease. And to this day, the disease itself remains a considerable threat to the lives of people across the country.
It is therefore vital that anyone responsible for managing a water system in the UK not only installs a Legionella Monitoring System, but also ensures that the approach they choose is effective.
Under HSE regulations it is required that the people you choose to carry out the Legionella risk assessment on your water system are fully competent to do the job. However it is possible for providers to go much further.
The best Legionella monitoring system providers will not only assess the risk that is currently in your water system, but will also provide advice and support to create a standard operating procedure that will minimise future risk as well.
Legionella bacteria are most prevalent in water that is held between 20 and 45 centigrade and cannot survive in temperatures above 60 centigrade. In many cases, it is therefore possible to reduce the risk of Legionella simply by adjusting the thermostat.
The speed of flow within the water system can also influence the risk of infection as can the types of materials used to create the equipment and its on going cleanliness.
Any fully competent Legionella assessor will be able to identify areas within the system that are prone to contamination and provide the resources to resolve any potential issues.
Though a professional assessor should carry out your Legionella monitoring, it is also essential that your employees are aware of the risks and how to reduce them.
Choose a service provider that offers awareness training to the relevant staff. This will ensure the risk of Legionnaire's disease developing in your water system can be minimised by those that work with it every day but also that the relevant personnel are aware of the their responsibilities should an outbreak occur.
When using an industrial steam boiler, one of the biggest potential hazards comes from the impurities in the water itself. These manifest themselves in four key forms that, without effective treatment, can lead to considerable damage within the entire system.
The main offenders of dissolved solids in steam boilers are calcium and magnesium. Both sulphates are scale forming when they are heated and can therefore leave hazardous deposits within the boiler and pipe network. Such deposits can lead to a reduction in the overall flow of the boiler and ultimately to blockages, corrosion, or total equipment failure.
Unlike dissolved solids, suspended solids remain in the water system in their original form, which makes them more likely to cause blockages or create areas of contamination. Thankfully, most solids of this nature can be filtered out of the water system before they enter the boiler. However, regular checks are required to ensure no such materials have been deposited.
Dissolved gasses such as oxygen and carbon dioxide are one of the major causes of corrosion within the standard industrial steam boiler. They cause weaknesses within the system that can result in a shorter lifespan for the effected equipment.
As such, impurities occur naturally in the water and it is very difficult to effectively reduce the levels of these solutions within contained water. However, effective steam boiler treatment will dilute the level of dissolved gasses and introduce corrosion resistant practices into the boiler that will combat their effect.
When scum or foam forms on the top of any water surface, it is a key indication that impurities exist that could harm the productivity or lifespan of the equipment involved. When scum or foam is discovered, detailed testing is required to identify the specific substance causing the scum and to identify the treatment required.
Whenever you employ a company to treat your industrial boiler, ask them how they combat each type of water impurity within their steam boiler treatment to ensure your service is going to be fully effective.
Find out more about our steam boiler treatment service.
Legionnaires Disease is a potentially fatal form of pneumonia. It is developed by inhaling air born particles of water that contain the Legionella bacteria, which attack the lungs and other internal organs of the body.

Though Legionella is naturally found in the waters and environment in which we live, the bacteria can rapidly develop to dangerous levels when they enter any man-made water system.
In Europe alone, more than 32,000 cases of Legionnaires Disease were reported in the ten years up to 2005, with forecasts of cases expected to rise over the coming years.
Though not all cases are terminal, with fatality rates ranging from 5% up to 50% for the most severe infections, Legionnaires Disease remains a significant threat.
In 2010 38 people died in England and Wales due to Legionaires Disease with symptoms ranging from organ failure to sceptic shock brought on by the infection.
The Legionella bacteria is potentially fatal to any victim, even if the person in question has been in good health. This means everyone who comes into contact with infected water vapour is vulnerable.
Furthermore, it is possible for this bacteria to remain active within the air for long periods of time. During one case in the French region of Pas-de-Calais, it was discovered that victims had been infected at a distance of over 6 kilometres away from the original infected water source, resulting in a total of 21 of the 86 people involved loosing their lives.
It is therefore essential that all commercial water systems are effectively monitored and managed to reduce the chances of Legionnaires Disease becoming an issue.
When carried out effectively, Legionnaires Disease monitoring can manage the level of Legionella bacteria within the water system to reduce the risk of an outbreak occurring.
All companies that work with artificial water supplies are legally required to comply to strict health and safety regulations which govern the monitoring and control of the Legionella bacteria.
In the UK, duties required to comply with this legislation are defined by the Health and Safety Executive. They state that any individual who manages a commercial water system is not only responsible for ensuring regular risk assessments are carried out in relation to the threat of legionnaires’ disease within their water, but also that they have responsibility for preventing and managing any risks as they occur.
To find out more about how we can help you with your Legionalla Monitoring, please call us on 01925 713273.
The key to preventing Legionnaires Disease is to ensure that any water contained within an artificial system is effectively managed to ensure it complies to health and safety limits.
As the Legionella bacteria thrives in warm stagnant water, all liquids should be kept at a temperature below 20°C or above 60°C wherever possible and kept moving to ensure that it the liquid remains fresh.
This means that water systems should be regularly cleaned and maintained to reduce the chances of the bacteria being able to form in slow moving or stagnant water, and that regular checks for the levels of Legionella bacteria are crucial.
For further information on the responsibilities of the actions that must be carried out when working with water systems refer to the Health and Safety Executive website to ensure your workplace complies.
To find out more about the services we can offer you please visit our services pages on Legionella:
If you would like to talk to one of our experienced team members please call us on 01925 713273. We look forward to hearing from you.
As the steam evaporates within the heat exchange process in a cooling tower, the concentration of water left behind rises. This can cause problems of contamination, corrosion, scale formation and fouling. Only with comprehensive cooling tower water treatments is it possible to avoid the long term costs associated with the reduced efficiency, equipment failure and health and safety risks that can result.

The Public Health Laboratory Service recently discovered that 60% of all man-made water systems in the UK contain legionella, the bacteria which causes the potentially fatal Legionnaires Disease. In fact, the risk of bacterial build up leading to such diseases is so real that the Government have now implemented their own legislation governing the treatment of the water used in cooling towers to ensure that all such systems are managing the threat effectively.
Regular assessment and control at a microbiological level with the use of biocides, is essential to inhibit the development of a range of harmful bacteria within cooling towers. Not only to maintain the health and safety of those living and working near the units, but also to extend the long term efficiency of the system and the operation it supports.
In a cooling tower, corrosion can be caused by standard oxidisation and galvanisation, as well as chloride and microbiatic sources which attack the structure of the system.
To avoid the threat of corrosion in cooling towers, it is essential to regulate the chemical content of the water and implement corrosion inhibitors to control the acidic concentration within the system.
Unfortunately, the less corrosive water becomes, the more prone it becomes to limescale. Therefore, effective corrosion management is only possible when carried out alongside scale formation treatment in order to maintain the lifespan of the cooling tower without impeding efficiency.
Limescale is an inevitable by-product of any heat exchange process, even in the softest of water. Yet high levels of scale formation within a cooling tower can have a significant impact on operational effectiveness.
Without effective treatment, it is estimated that the average cooling tower would have to discard 15 gallons of water for every 5 gallons that evaporate, just to maintain suitable concentration levels.
If concentration is too high, solid deposits of limescale reduce the flow of water and severely inhibit the efficiency of the heat exchange. Furthermore, these deposits create an environment ripe for corrosion and the build up of potentially harmful contaminants which can have immediate and severe results.
Introducing water softeners and limescale inhibitors within a full water treatment program can manage scale formation, while managing the overall system concentration can avoid further deposits occurring.
Even when it is possible to reduce the sediment produced by contamination, corrosion and scale formation, a cooling tower can still be subject to fouling, especially if the water does not come directly from a mains source.
Particles from the air and surrounding atmosphere all find their way into the system which then collects in low-velocity areas. Such deposits lead to the increased possibility of bacterial build-up and corrosion as well as a reduction in the flow of water throughout the system.
If the source of the fouling can be located it is possible to install filtration systems to via either a pre-filtration system, targeting the water entering the system, or a core filtration system within the unit itself.
When combined with regular treatments of polymer dispersant and periodic intensive cleaning, these treatments can improve the overall efficiency of the system and continue the productivity of the cooling tower well into the future.
Legionnaires disease is a potentially fatal infectious disease that affects the respiratory system. Symptoms include a fever, chills, coughing, tiredness, vomiting and confusion. The illness can be fatal. Those aged from 45 years upwards are more at risk from death.
The bacteria that causes it, Legionella, is found in any water system be it natural or man made. Therefore, under the Health & Safety at Work Act 1974 and the Control of Substances Hazardous to Health regulations, all owners of premises with water systems must carry out a Legionella risk assessment regularly.
Legionella bacteria does not spread through person to person contact. It is carried on airborne water droplets which must be inhaled. Such water droplets are produced by hot-water tanks, evaporative condensers, cooling towers or air conditioning systems. This is because this industrial equipment stores hot and cold water in its systems which provides the perfect environment for Legionella to thrive.
Moreover, a risk assessment takes into account your type of water system and weather or not the people who could be exposed are within the high risk age group.
So it really will be worthwhile looking into whether or not your company needs a risk assessment. In many cases it may seem like it doesn't apply when in fact it is required.
Waste water treatment is a vital process for businesses and companies. Without a waste treatment plan, running costs go up and up. Untreated water causes industrial equipment to scale up and corrode meaning replacements are needed.
Corroded, scaled machinery needs more fuel to operate. Warm dirty water encourages bacteria to grow and fatal diseases like Legionnaires can spread. Where water contacts the manufactured product, a lack of treatment can damage those products. Not to mention the harmful effects of dirty water on the environment.
It is important to find an effective and professional company to treat your commercial waste water for you as pollutants must be at a regulated level before entering community treatment plants.
At the waste water treatment plant, water is treated using chemical, physical or biological methods. Each of these has an important role to play and it is best practice to use a combination of all of them at different stages.
Commonly, physical methods are used first. Next come physical and chemical processes combined. Biological treatment is the next phase. Final advanced stages often utilise physical and chemical methods. However, a programme should be tailored to your individual needs.
The water is passed through a filter or screen so that any large objects are captured. Sedimentation is also used. Here the water is left to settle so that solids sink to the bottom by way of gravity. The clean water left at the top can then be taken off.
With chemical methods a great range of specialist and highly regulated chemicals are used. This aspect of waste treatment is potentially a risk to health or the environment. By choosing a waste water treatment company that is up to date and in compliance with health and safety laws you can ensure that there is no danger. The chemicals act by killing bacteria and any pathogens and slowing the rate of decomposition.
With biological methods bacterial and other micro-organisms are used to attack and kill harmful, unwanted micro-organisms.
Cooling Towers are used by many companies to reduce the heat caused by industrial processes. Small units are commonly found on rooftops or attached to walls which dispel heat from air conditioning systems.
Any cooling tower, big or small, can pose a risk of Legionnaires disease. Studies have shown that 40 to 60 percent of cooling towers tested harbour it. If left unchecked the disease spreads via the air. Mist droplets carrying the Legionella bacteria escape from the water system and are inhaled by the people present. A thorough and regular programme of inspection and water treatment is needed to prevent the growth and spread of Legionella bacteria within your cooling tower.
Halogens such as chlorine or bromine should be added as frequently as possible to keep Legionella bacteria under control. Continuous application is recommended. The use of electronic water treatment devices may also be applied. Material coatings are another approach or bio-static components.
Drift eliminators that are in good working order are crucial. It is important to ensure that all components are clean and clear. Be sure to check all seals to prevent water from escaping and bypassing the eliminators.
In the cold water basin sludge and debris can build up and become a perfect breeding ground for bacteria. It is important to check for this regularly. Look at the condition of the sump screen. It should be free of trash. Look for any signs of corrosion in all the components of the basin. Again, check all seals.
If any work is to be done inside your cooling tower turn off the fans first. This prevents contamination and spread. It is also a good idea for any workers to wear a face respirator mask with High Efficiency Particulate Air filters (HEPA) whilst inside the cooling tower.
There is a risk of exposure to Legionella in any workplace where a man-made water system is present. As someone who is in control of business premises, employee or landlord, it is your responsibility to take the precautions necessary to control this risk. Systematic and rigorous monitoring is part of this.
Legionella monitoring should be carried out by accreditted qualified service provider. Pathogen screening should be tested by a UKAS accredited laboratory. The UK Health & Safety Executive recommends that the sampling method should be in accordance with ISO 11731:19988. A service provider will offer an extensive package that includes screening for Salmonella, Listeria, E.coli O157, Campylobacter, Clostridium, Perfringens, Pseudomonas and Norwalk virus as well as Legionella.
An efficient and well planned monitoring programme will not look for Legionella bacteria every time a sample is taken. This is because complex, specialist laboratory techniques are required to identify Legionella. Instead, general bacterial species will be tested for regularly. This is a more straightforward process which can indicate whether or not your microbiological controls remain effective. Alongside this Legionella will be monitored for periodically.
Whilst general bacteria is being tested for regularly, Legionella should be looked for on an annual basis from hot & cold water systems, more frequent quarterly analysis for Cooling Towers and Evaporative Condenser systems. There are times when it will be necessary to sample for Legionella more frequently. For example, during outbreaks, companies may be called on to submit extra samples to help find the source. Moreover, if you are commissioning a new water based system, samples for Legionella should be taken on a monthly basis until it is certain that the new system is under control.
Legionella is a bacteria widely prevalent in nature, so it is likely to be found during monitoring quite frequently. If a sample for Legionella is confirmed positive steps are taken to regain control. Firstly, the harmful biocide will be neutralised. A thorough review of the system and risk assessment will then be carried out. More frequent samples will be required as part of this. These should be taken as near to the heat source as possible. This will continue until it is established that the system is stable.
Monitoring is only a small part of Legionella risk management that should run alongside systematic assessments, controls and thorough record keeping. For in depth information on your duties under the law visit the Health & Safety Executive website.
Many industrial processes produce excess heat that needs to be dissipated, and this is where cooling towers come in. They remove heat safely and dispel it into the atmosphere.
When you think of cooling towers you may envisage the awesome buildings found in oil refineries, chemical plants and thermal power stations. Some of these are huge hyperboloid structures towering up to 200 meters tall and 100 meters in diameter. These feats of engineering are associated with nuclear power plants and, although this might be what we think of as a cooling tower, the vast majority of them are much smaller. Tiny roof top installations are very common, as are small units attached to buildings to discharge heat from air conditioning.
Cooling tower technology strives to limit the ammount of energy required to disipate the heat, whilst reducing the volume of water used as much as possible in order to inhibit environmental damage.
As water from the cooling tower evaporates it leaves behind impurities. These build up continually, leading to corrosion and scaling. Some of this water, known as bleed, is sent back to the sewer system. Bleed should be kept to a minimum in order to save water and reduce the chance of harmful chemicals leaking into the environment.
The type of water treatment methods selected can make a significant difference here. Corrosion and scale can be kept in check by adding chemicals and biocides to the water in the cooling tower. Bleed is successfully reduced by keeping impurities low. However, the chemicals used may ultimately end up in local eco systems.
Non-traditional methods of water treatment are now available. One of these types is the use of solid chemicals, concentrates are delivered in small 6kg containers and dilutions made up on sites. Thus minimising transportation costs, disposal costs and operating costs all good for the environment together with an excellent health & safety profile.
Further alternative method include; pulsed power method which uses high frequency electrical pulses to break open biosolid cell membranes, Ultrasonic Control which emits frequencies which can rupture different cell walls. Specific ultrasonic vibrations can inhibit bacteria from settling and thus forming a biofilm.
Over the last decade there have been exciting advances in water treatment technology. It is down to our industry in partnership with responsible company leaders to ensure that we continue to provide environmentally friendly water treatment solutions
Production companies use steam boilers to power many industrial processes. The possibilities are endless, so you will come across steam boilers being utilised as a power source in a huge variety of businesses.
Problems arise because harmful materials dissolve readily in the pure water that the system uses. Substances such as carbon dioxide, oxygen and metals are absorbed and water treatment solutions are required to remove them before they cause damage.
If left unchecked these impurities can lead to many problems:
This forms during evaporation. Impurities are precipitated out of the water and deposited in the boiler as crystalline and rock like structures. Scale acts as an insulating layer so heat cannot pass through the tubes to the circulating water, as small as an ammount of 1-2mm layer can increase the fuel consumption by upto 11%. Ultimatelt this causes boiler tubes to overheat and fail.
This is one of the most serious problems and is irreversible. Oxygen and carbon dioxide reduce the metal parts of the boiler to iron so that it crumbles leaving holes and weak points in the structure of the boiler.
This is when the steam produced is contaminated by the boiler water. Solids and impurities in the boiler water cause it to foam. This foam is then carried up in the steam. The suspended solids deposit in the condensate and steam system causing it to fail.
It is essential that a good water treatment plan is put in place to remove these impurities. Without one the chemical build up begins to compromise efficiency. More fuel is needed to produce the steam. More water may be needed to compensate for leaks. All this leads to sky rocketing costs. There could also be health and safety risks as chemicals and heat escape where it shouldn't. In extreme cases boilers have been known to explode.
By using a good water treatment plan you can dramatically reduce costs and extend the life of industrial equipment. Strict industrial standards are in place regarding steam boilers and water treatment plays a vital role in maintaining these.
Contact us today to find out more about Steam Boiler Treatment and how we can help.
Legionnaires' disease is an infection of the lung that kills the victim in up to 10-15% of cases. It can occur in any water systems in the UK and around the world. However, as long as the right preventative measures are taken, the risk of infection can be greatly reduced.
Legionnaires' disease is caused by the Legionella bacteria, which poses the greatest risk in artificial water systems such as air conditioning systems, cooling towers, heating systems and even fountains and spas. If the conditions are right, the Legionella bacteria can rapidly multiply and cause an outbreak.
When water systems are maintained properly, the risk of the Legionella bacteria infection is minimised greatly. There are a number of strict regulations governing water systems, especially larger systems in hotels and hospitals. By sticking to the regulations and checking that they are carried out effectively on a regular basis, prevention becomes a lot easier.
One of the most important regulations is that water that is stored in a system is kept at the correct temperature. This should be either below 20°C or above 60°C. If water is kept between these two temperatures then the risk of infection increases.
It is important to control the hygiene of the water in the system to prevent the spread of the Legionella virus. This involves making sure that the water is not stagnant and that it does not contain any impurities.
To minimise the risk posed by the Legionella bacteria, it is a good idea to arrange a regular risk assessment by a specialist water treatment company. This will highlight any risk areas and allow you to make any necessary changes to avoid problems occurring.
Whether you are an employer, a landlord or even just a homeowner, you have a duty to reduce the risk of a Legionnaires' disease outbreak by maintaining your water supply correctly.
Legionnaires' disease can kill, but you can reduce your risk of your water system causing an outbreak through careful prevention. If you are in doubt about your obligations and you want to carry out a full risk assessment, contact us today.
Water treatment companies can help to kill deadly bacteria and save lives. Large establishments should therefore ensure that they have their water systems inspected and treated for Legionella and other bacteria to avoid potential serious issues from arising.
However, how do you choose a treatment company? There are a few factors to consider, and here are a few of the most important.
Water treatment is a specialist area, and it is important that your chosen company is fully compliant with all the latest legislation. One thing to look out for is a list of accreditations, which could include:
The professionals who work at the water treatment company should all be highly experienced. If you are unsure, find out whether they receive regular training and testing to ensure that they are constantly kept up to speed with the latest developments.
Any water treatment company that you choose, should have a range of different programmes in place to meet your needs. Water safety and water hygiene services could consist of removing scale formation and corrosion from your cooling system, removing bacterial activity from closed water systems, steam boiler treatment, waste water treatment and a range of other treatments.
Although the price of the treatment is not the most important factor to consider when choosing a water treatment company, it is still better to find treatments that are not overpriced so that you can take full advantage of all of the crucial treatments at an affordable price.
Effective water treatment is very important, and could mean the difference between life and death. Make sure that when you are choosing a water treatment company you always base your decision on the above at the very minimum. You will then know that you have an excellent team of top professionals working with you to ensure that your water systems are safe.
To find out more about how Advanced Water Technologies can help you with water treatment, click here to contact us. We look forward to hearing from you.
Bathing waters are any body of water that attracts a large number of bathers. It might be along a stretch of beach, or part of an inland picnic area. It could even be a section of water that is part of a tourist related business, like a caravan park or amusement ride area.
In 2012 the government issued a revised Bathing Water Directive with tighter standards and new classifications. The water treatment industry faces the task of meeting the new standards by 2015. This exciting but challenging objective requires extensive resources. For example, in Scotland, which has 83 bathing waters to date, over £100 million has been invested between 2002 and 2010.
There are several steps Water Treatment companies must take towards improving bathing water.
This includes bacteria, which may be used to break down organic matter such as fats, human metabolic waste or food in a controlled environment within the water treatment site.
If this material is discharged into waters directly, then naturally occurring bacteria will set about breaking it down. Outside of controlled conditions, this process soon uses up all the oxygen in the water leaving dead zones where no wildlife can survive and the eco systems collapse. However, toxicity becomes high which will effect swimmers. The water can also carry pathogens like Noroviruses.
Tertiary UV treatment is another provision applied. This is when filtered water is passed under UV light to remove pathogens, chemicals or nutrients from the bathing water. The UV rays are set to peak at 254 nanometers. This level causes cellular damage to kill micro-organisms. Water treatment may also take steps to reduce discharges from combined sewage overflows.
The new Bathing Water Directive assesses water quality against just two parameters over a longer time frame to reduce the cost of monitoring. There are four new classifications in place, Excellent, Good, Sufficient and Poor. The Excellent and Sufficient classes are both twice as stringent compared to the old guidelines.
The Bathing Water Directive (76/160/EEC) is a welcome commission. We can all rest assured that it is striving to protect the public from illness and pollution when they swim in public waters.
Nutrients like phosphate and nitrate are essential to the plants and animals in our rivers. However, when these elements rise above a healthy level they can have a devastating effect on wildlife.
Excessive phosphate requires a massive amount of oxygen to break it down. Oxygen levels in the water become so low that only tough organisms like Diatoms and macrophytes can survive. As a result, overwhelming blooms of algae can occur causing an unsightly green sludge on the water. This endangers more animals, causes unpleasant sights and smells and drives down property value.
Water Treatment has a part to play in combating nutrient pollution in UK's rivers and lakes.
However, the problem starts in our businesses and homes. Phosphate is added to laundry detergent and cleaning products to help it remove dirt. The wastewater containing these phosphate rich products then needs to be dealt with through water treatment and when it is not, too many nutrients end up back in the water ways. While some water treatment processes have also added to the problem by using phosphates as part of chemical corrosion and scale control.
Over the last 20 years the industry has been working closely with the Environment Agency, which has seen water quality has improved significantly. Water treatment now uses phosphate removal systems which utilise specialist bacteria to absorb phosphates, or chemical precipitation using salts of iron. These processes produce a phosphate rich sludge that can be recycled as fertiliser.
In terms of overall ecological quality, 26 per cent of rivers are good or better, 60 per cent are moderate, 12 per cent are poor and 2 per cent are bad across England and Wales. This is better than it was, but not perfect. As Wastewater Treatment has done much to reduce its nutrient output, the Environment Agency are now approaching other angles. The current focus is on farming, discharges from septic tanks and feedlots, as well as emissions from combustion.
Awareness is key and can empower us to protect the environment. Zeolite is a naturally occurring alternative to phosphate in cleaning products. This substance is environmentally friendly and does not contribute to nutrient pollution. So look out for this when buying detergent.
We, in the industry, are proud of what we have achieved. By working together to engineer effective solutions we can continue to improve our waterways.
This is an issue that can affect a surprisingly wide range of companies. Almost any workplace or commercial area could be at risk from Legionella contamination if there are water systems present.
If your premises use cooling towers, hot and cold water systems, spa pools, humidifiers, air washers, emergency showers, eye wash sprays, indoor ornamental fountains or aqueous tunnel washers then you are required by law to carry out a comprehensive Legionella risk assessment.
This legislation is outlined in The Control of Substances Hazardous to Health Regulations act of 2002 (COSHH) and the Health and Safety at Work Act of 1974 (HSWA).
The person or team appointed with this task could be the manager, workers, or a specialist company from outside the business. The main point is that the chosen assessor has the necessary skills, knowledge and experience.
If risk factors are found then you will need to put measures in place to eliminate them. This may mean changing your water system or using a method to control bacteria growth within it.
There is a danger of the bacteria flourishing and spreading if:
A good risk assessment should include a description of your system and any sources of risk. It must then state the controls in place. There must also be a clear outline of your monitoring, inspection and maintenance procedures along with a record of the dates and results of these. Finally, a review date is essential to accommodate inevitable changes.
Remember, Legionella causes Legionnaires disease which is at best unpleasant and at worst fatal. This is not an issue that can be ignored by responsible business owners.
Contact us today to discuss legionella risk assessments further.
The Legionella bacteria is found in natural and manmade water systems, but often only in very small numbers. However, if the bacteria multiplies rapidly, it can cause an infection called Legionnaires' disease. It is therefore essential that establishments with water systems at risk from the Legionella bacteria do everything possible to prevent infections from occurring.
Legionnaires' disease is a lung infection that is sometimes fatal. People may become infected when they come into contact with the Legionella bacteria, which can sometimes appear in water systems in buildings.
Symptoms of Legionnaires' disease include a high fever, which can sometimes be over 38°C, headaches, muscle pain, a nasty cough, confusion and even chest pains and diarrhoea.
The treatment for Legionnaires' disease involves a course of antibiotics, often Erythromycin or Clarithromycin. However, in 10-15% of cases where healthy people have become infected, it can lead to death. The number is higher in more vulnerable people including the elderly and people with health conditions such as diabetes.
The Legionella bacteria is commonly found in natural water sources like lakes, but it can also find its way into artificial water systems if the conditions are right for the bacteria to multiply.
It is typically a more serious problem in larger buildings like hotels and hospitals, which have larger water systems. Regulations are in place to reduce the risk of the spread of the Legionella bacteria, which include keeping the water to below 20°C and above 60°C. Even so, outbreaks still occur and many people die of the infection each year in the UK alone.
Due to the serious risk posed by the Legionella bacteria, it is essential that large establishments ensure that they receive efficient water prevention advice from a specialist. Prevention is always the best plan of action, so establishments should arrange a Legionella risk assessment to find out how much of a risk Legionella poses.
It is never worth taking a risk with something as serious as the Legionella bacteria and Legionnaires' disease. If you want to make sure that your water system is safe, arrange a Legionella risk assessment today.
Advanced Water Technologies
2 Webster Court
Carina Place
Gemini Business Park
Warrington
Cheshire
WA5 8WD
© Advanced Water Technologies
